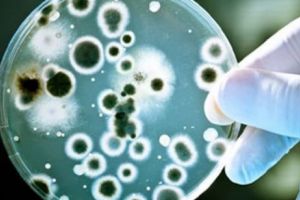
OMENIREA este în PERICOL. PANDEMIA care ar putea ucide 147 de milioane de vieţi omeneşti

Parteneriat între Complexul Muzeal Arad şi Asociaţia Turism Alternativ Arad
newsar.ro - Arad
Citeşte azi ce scriu ziarele de mâine!

Veoneer Academy
www.tion.ro - Timiş
ADVERTORIAL. Urmează paşii din hartă şi descoperă cum poţi începe o nouă călătorie în Ținutul Veoneer.

Raman doua terenuri pentru sala polivalenta. Robu e patimas cu locul din Timisoara
www.tion.ro - Timiş
Când doi se ceartă, cine câştigă? Disputa pentru sala polivalentă pe care CNI s-a angajat că o construieşte pentru Timişoara s-a mutat pentru o clipă în consiliul local. Aleşii au fost chemaţi „de îndată” să dezbată o altă problemă, iar primarul a reuşit să strecoare şi un proiect privind ultimul teren propus pentru ridicarea mult-aşteptatei săli. După aproape o oră de discuţii, propunerea a trecut, iar CNI rămâne cu două variante: un teren lângă stadion şi cel de la Giroc. Tot CNI decide unde se face sala, dar primarul Nicolae Robu spune că e pătimaş şi nu acceptă un alt loc decât unul din Ti

Mitropolitul Banatului raspunde criticilor: Nu mi-e rusine ca am sustinut familia crestina
www.tion.ro - Timiş
Mitropolitul Banatului, ÎPS Ioan, a răspuns criticilor aduse de profesorul Vasile Popovici, care i-a cerut demisia în urma rezultatului referendumului privind redefinirea căsătoriei. Înaltul ierarh spune că nu îi este ruşine că prin poziţia sa a susţinut familia creştină.

Negocieri de cinci ore in scandalul de la Filarmonica Banatul
www.tion.ro - Timiş
Primarul Timişoarei este decis să intervină în scandalul de la filarmonică, dar doar dacă negocierile dintre sindicaliştii nemulţumiţi şi managerul Ioan Gârboni nu se încheie până la sfârşitul săptămânii. Oamenii vor un contract colectiv de muncă, dar spun că directorul instituţiei de cultură refuză să îl semneze. S-a negociat cam cinci ore, luni, pe această temă.

Bilantul Politiei Locale, dupa patrulele zilnice in Traian: cele mai multe amenzi, pentru scandaluri
www.tion.ro - Timiş
Au făcut într-o săptămână cât n-au făcut tot anul în zonă! Poliţiştii locali, puşi de primarul oraşului să patruleze zilnic în Piaţa Traian, au tras linie după o săptămână plină. Se laudă cu peste 200 de amenzi, cele mai multe fiind aplicate pentru scandaluri şi înjurături.

Se cere demisia Mitropolitului Banatului dupa rezultatul de la referendum
www.tion.ro - Timiş
Reprezentanţii Iniţiativei Timişoara au făcut publică o scrisoare deschisă a profesorului Bazil Popovici (Vasile Popovici), către Mitropolitul Banatului, ÎPS Ioan. În depeşa făcută publică duminică, 7 octombrie, profesorul Popovici îi cere Mitropolitului Banatului demisia, după rezultatele referendumului.

Referendum 2018: Câţi clujeni au VOTAT ”DA” şi câţi au pus ştampila pe ”NU”
www.stiridecluj.ro - Cluj
Referendum 2018: Câţi clujeni au VOTAT ”DA” şi câţi au pus ştampila pe ”NU”

Ziua Carierei, la Palatul Copiilor Bacău
www.desteptarea.ro - Bacău
Zece părinţi de profesii diferite, care şi-au înscris copiii la cursurile Palatului Copiilor Bacău, au fost invitaţi să vorbească elevilor instituţiei de învăţământ nonformal din Bacău despre frumuseţea, provocările sau dificultăţile meseriilor pe care le practică, în cadrul evenimentului ”Ziua Carierei”, organizat vineri, 6 octombrie, de Ziua Mondială a Educaţiei. Elevii prezenţi, copii de clasele …

De ce vă indignaţi
www.desteptarea.ro - Bacău
O prinţesă şochează presa britanică pentru că ar fi încălcat protocolul închizându-şi singură uşa de la maşină. Melania Trump e criticată pentru că a purtat, în Africa, o caschetă asemănătoare cu cea purtată de trupele coloniale şi care mai este folosită şi astăzi de turişti. În SUA e scandal cât China de mare pentru că …

Recital extraordinar, la Sala Ateneu
www.desteptarea.ro - Bacău
Marţi, 9 octombrie, ora 18.30, la sala Ateneu, amatorii muzicii clasice au posibilitatea să se întâlnească cu pianistul Evgheni Starodubtsev (Rusia), la un recital extraordinar. Laureat a zeci de concursuri internaţionale, pianistul rus va interpreta lucrări de Bach (Toccata în Fa # minor), Enescu (Sonata nr. 1), Liszt (Rapsodia spaniolă şi studii transcedentale), A. Skriabine …

Măgireştenii şi-au sărbătorit bunicii şi părinţii
www.desteptarea.ro - Bacău
Vremea numai bună pentru lucrările agricole de toamnă a amânat sărbătorirea Zilei Internaţionale a Persoanelor Vârstnice în comuna Măgireşti cu aproape o săptămână. Dar, duminică, 7 octombrie – ne-a informat preşedintele Subfilialei Cultul Eroilor, Constantin Dospinescu -, în sala Primăriei au fost invitate, pentru a fi felicitate cu acest prilej, 11 familii care au împlinit …

Vizită a unei delegaţii din republica Moldova
www.desteptarea.ro - Bacău
Vineri, 5 octombrie, vicepreşedintele Consiliului Judeţean Bacău, Silviu Pravăţ a primit vizita unei delegaţii din Republica Moldova, aflată într-o deplasare de lucru în judeţul nostru. Delegaţia a fost condusă de Ruslan Codreanu, primar general interimar al municipiului Chişinău, alături de care s-au aflat şefii Direcţiei Generale de Transport Public şi Căi de Comunicaţie, Direcţiei Generale …

O ediţie de Excelenţă a Simpozionului Naţional „Vasile Pârvan”
www.desteptarea.ro - Bacău
Opinii unanime: ediţia din acest an a Simpozionului Naţional „Vasile Pârvan” a fost una de Excelenţă, desfăşurat sub egida Anului Centenar. Comunicările în plen şi pe secţiuni au abordat teme fundamentale ale istoriei şi arheologiei naţionale, vieţii spirituale, cât şi dedicate unor personalităţi din perioada luptei pentru Unirea cea Mare din 1918. Prima conferinţă ştiinţifică …

Clanul caricaturiştilor, în Bacău
www.desteptarea.ro - Bacău
Între două saloane internaţionale de caricatură, Brăila şi Vaslui, la invitaţia caricaturistului băcăuan Victor Eugen Mihai – VEM, nouă caricaturişti din toate colţurile ţării s-au reunit în Bacău, la Centrul de Cultură “George Apostu”, într-un workshop, pe o temă denumită – cum se putea altfel! – “Despre caricatură”. Au răspuns invitaţiei caricaturiştii Constantin Ciosu (Bacău), …

Pe terenul campioanei
www.desteptarea.ro - Bacău
Continuă seria meciurilor dificile pentru CSM Bacău în această primă jumătate a turului din Liga Zimbrilor. După Steaua, CSM Bucureşti şi Potaissa Turda vine rândul campioanei en titre, Dinamo Bucureşti să se pună de-a curmezişul în calea „CSMeilor”. Programată în această seară, la ora 19.00, în Polivalenta „Dinamo”, partida Dinamo- CSM Bacău deschide etapa a …

Adevăr şi provocare
www.desteptarea.ro - Bacău
Sănătatea repede şi bine… Dacă nu ştim cum să obţinem sănătatea, societatea noastră se va obliga să ne propună sau, mai bine, să ne vândă soluţii. Se vor dovedi ele satisfăcătoare? Care este răspunsul corect? Sănătatea nici nu se vinde, nici nu se cumpără. Mai este acest lucru valabil şi astăzi? Dacă ai avea o …

New generation
www.desteptarea.ro - Bacău
Derulată weekendul trecut, în Bacău, etapa de zonă a Campionatului Naţional pentru juniori mici la lupte a reunit peste 100 de sportivi de la cluburi din Moldova. CSM Bacău şi SCM Bacău, pregătite la acest nivel de vârstă (11-15 ani) de antrenorii Ion Șarban şi Irinel Botez şi-au asigurat nu mai putin de zece luptători …

Scandal în autobuz
www.desteptarea.ro - Bacău
Zilele trecute, printr-un apel la Dispeceratul Poliţiei Locale a Municipiului Bacău, ofiţerul de seviciu a fost sesizat cu privire la faptul că o femeie însoţită de un copil tulbură ordinea şi liniştea publică într-un autobuz pe Traseul 17 din municipiul Bacău. Joi, 4 octombrie, poliţistii locali au procedat la identificarea numitei T. E. în vârstă …

Frumuseţe şi bucurie la Festivalul ”Cununa Munţilor – 2018”, de la Asău
www.desteptarea.ro - Bacău
La Asău, unde sus sub culmile brazilor mai este câte o cabană în margine de poieni, sub lumina strălucitoarelor raze ale unei frumoase zile de toamnă, a avut loc Festivalul de folclor şi tradiţii populare ”Cununa Munţilor 2018”. Această manifestare folclorică deosebită s-a desfăşurat pe stadionul din localitate, care şi-a deschis larg porţile pentru a …

Vaccin antigripal gratuit pentru băcăuani
www.desteptarea.ro - Bacău
Vaccinul antigripal este disponibil deja prin Direcţia de Sănătate Publică (DSP) Bacău şi va fi utilizat pentru imunizarea gratuită în cadrul campaniei derulate de Ministerul Sănătăţii. „Instituţia noastră a stabilit şi necesarul de vaccin antigripal pentru sezonul rece 2018-2019, la nivelul judeţului Bacău. Acesta este de 46.265 de doze, necesar ce a fost stabilit în …

Care a fost prezenţa la vot în judeţul Bacău.Topul extremelor: de la 4,69% la 67,75%
www.desteptarea.ro - Bacău
În cele două zile ale Referendumului naţional pentru revizuirea Constituţiei, în judeţul Bacău au votat 129.116 de cetăţeni din cei 605.043 înscrişi pe listele electorale permanente. Prezenţa la vot în judeţul Bacău a fost de 21,33 la sută. Din cele 635 de secţii, cele mai multe au avut procente apropiate de medie, dar au existat …

Drum judetean de peste 10 kilometri reabilitat in Tara Fagetului. Un nou acces spre lacul Surduc
www.tion.ro - Timiş
Un drum judeţean în lungime de peste 10 kilometri din Țara Făgetului a fost inaugurat luni, 8 octombrie. Este vorba despre drumul judeţean DJ 681, care asigură legătura dintre Drumul Naţional (DN) 68A (Făget) cu localitatea Drăgsineşti, cu zona turistică Fârdea (lacul Surduc) şi cu DN 6, prin localităţile Fârdea – Hăuzeşti – Crivina - Criciova.

Grindeanu sare in apararea Mitropolitului: Atacul la adresa IPS Ioan este de neinteles
www.tion.ro - Timiş
Fostul premier Sorin Grindeanu a sărit în apărarea Mitropolitului Banatului, ÎPS Ioan, la doar câteva ore după ce i s-a cerut demisia în urma rezultatelor referendumului pentru redefinirea căsătoriei.

Camioneta şi BMW-ul s-au lovit la Mărăcineni
ziarulargesul.ro - Argeş
Cu câteva momente în urmă s-a produs un accident rutier la Mărăcineni, lângă intersecţia cu Colibaşi. Din informaţiile noastre, două dintre vehiculele implicate în accident au fost un BMW gri închis şi o dubă galbenă(foto). Circulaţia a fost blocată spre Câmpulung. Revenim cu detalii. Foto...

Duba şi BMW-ul s-au lovit la Mărăcineni
ziarulargesul.ro - Argeş
Cu câteva momente în urmă s-a produs un accident rutier la Mărăcineni, lângă intersecţia cu Colibaşi. Din informaţiile noastre, două dintre vehiculele implicate în accident au fost un BMW gri închis şi o dubă galbenă(foto). Circulaţia a fost blocată spre Câmpulung. Revenim cu detalii. Foto...

Țara în care producătorii germani testează deja automobilele autonome
evz.ro - Bucureşti
Fără tam-tam şi declaraţii sforăitoare, mărcile premium germane Audi, BMW şi Mercedes au început teste de anvergură ale maşinilor autonome de nivel superior...

Pe cine a numit premierul Dancila sefa la una dintre cele mai importante agentii guvernamentale. De unde vine aceasta
www.ziuaconstanta.ro - Constanţa
Oficiul National pentru Achizitii Centralizate

Tudor Chirilă a avut dreptate! Cum am recuperat 21,112.45$ cheltuind peste şaizeci de mii. Horoscop
evz.ro - Bucureşti
Horoscop Apoi am stat pe un fotoliu cu căţeii cuminţi şi isteţi în jurul meu şi mi-am mai amintit de una, de alta. Am zâmbit, am râs, m-am întristat. Este ...

Recitări: „Împreună pentru România”
mesageruldecovasna.ro - Covasna
Vrei să fii notificat când apare un articol nou? Abonează-te prin e-mail

Ajutoare de deces de peste 8,4 milioane de lei, achitate gorjenilor
www.gorjeanul.ro - Gorj
Peste 8,4 milioane de lei a achitat Casa Judeţeană de Pensii (CJP) Gorj, în primele opt luni ale acestui an, cu titlu de ajutor de deces. Sumele sunt unele mai mari faţă de aceeaşi perioadă a anului trecut şi ca urmare a majorării indemnizaţiei, ce s-a făcut potrivit unui act norm

Feţanu conduce IPJ Gorj! Concursul, organizat în această lună
www.gorjeanul.ro - Gorj
Reprezentanţii Inspectoratului General al Poliţiei Române au stabilit, ieri, cine va conduce Poliţia Gorj, după ce a expirat împuternicirea comisarului-şef Decebal Drăghiea. Unul dintre adjuncţi, Daniel Feţanu, a preluat, temporar, atribuţiile inspectorului şef, până la organizarea con

Scandal la spitalul din Rovinari, după moartea unei paciente! A fost nevoie de intervenţia poliţiştilor
www.gorjeanul.ro - Gorj
Inspectoratul de Poliţie Judeţean Gorj a declanşat o anchetă la Spitalul Sfântul Ștefan din Rovinari, duminică, după moartea unei femei de 57 de ani, din comuna Teleşti. Rudele pacientei îi acuză pe medici de nepăsare, fiind nevoie de intervenţia oamenilor legii, pentru calmarea spirite

CSM CSU Oradea a debutat cu o victorie la 11 puncte, în noua ediţie a Ligii Naţionale
www.ebihoreanul.ro - Bihor
Baschetbaliştii de la CSM CSU Oradea s-au revanşat după înfrângerile din debutul noului sezon şi s-au impus luni seară, în Arena Antonio Alexe, în confruntarea cu CS SCM Timişoara. 'Leii roşii' au câştigat la o diferenţă de 11 puncte, cu 76-65, după ce au practicat un joc foarte bun, cu o apărare foarte bine organizată.

O şcoală din Licurici recrutează administrator financiar
www.gorjeanul.ro - Gorj
Şcoala Gimnazială Negreni din comuna Licurici, judeţul Gorj, organizează concurs de recrutare pentru ocuparea pe perioadă nedeterminată a funcţiei contractuale vacante, de administrator financiar contabil cu 0,5 normă. Pentru a ocupa un post contractual vacant sau temporar vacant, candidaţi

CJAS Gorj aşteaptă rectificarea bugetară
www.gorjeanul.ro - Gorj
Casa Judeţeană de Asigurări de Sănătate (CJAS) Gorj aşteaptă o rectificare bugetară pentru unităţile sanitare din judeţul nostru. Cel mai probabil aceasta va veni până la sfârşitul lunii.Conducerea Casei Judeţene de Asigurări de Sănătate Gorj confirmă că spi

Plăţi în avans pentru fermierii gorjeni
www.gorjeanul.ro - Gorj
Guvernul a aprobat în şedinţa de săptămâna trecută o hotărâre pentru acordarea unor plăţi în avans pentru fermieri, începând din 16 octombrie. Astfel, Guvernul a aprobat Hotărârea privind stabilirea pentru anul 2018 a cuantumului per hectar al plăţii unice pe suprafaţă, al plăţ

Încep lucrările pe DN 67 D Târgu-Jiu – Tismana
www.gorjeanul.ro - Gorj
Constructorii vor începe în câteva zile lucrările pe DN 67 D Târgu Jiu – Tismana. Parlamentarul Mihai Weber a anunţat că a fost organizată o licitaţie în urma căreia contractul de reabilitare a DN 67 D a fost încredinţat unei firme de specialitate. Astfel, dacă vremea va permite, luc

Căldură în saloanele Spitalului Orăşenesc Novaci
www.gorjeanul.ro - Gorj
Spitalul Orăşenesc Novaci este situat într-o zonă montană, motiv pentru care furnizarea agentului termic se face, de regulă, mai devreme spre deosebire de alte unităţi sanitare. Conducerea spitalului din Novaci confirmă faptul că în saloane este căldură de peste o săptămână. A fost

Pandurii, gata să uite eşecul cu UTA
www.gorjeanul.ro - Gorj
Deşi au pierdut primul joc din acest sezon pe teren propriu, pandurii merg în deplasarea de la Clinceni fără teamă. Antrenorul formaţiei noastre, Adrian Bogoi, a declarat că următoarele două meciuri sunt un prilej pentru trupa gorjeană să-şi măsoare forţele cu cele mai bune echipe din

Corina Cretu: Nu mai accept insultele Guvernului Romaniei fata de munca mea. Facem eforturi supraomenesti sa evitam dezangajarile
ziarmm.ro - Maramureş
Comisarul pentru politica regionala, Corina Cretu, a criticat dur, intr-o conferinta la Bruxelles, lipsa marilor proiecte romanesti pentru atragerea fondurilor europene si a anuntat ca nu mai accepta

Facilităţi pentru foştii deţinuţi
www.gorjeanul.ro - Gorj
La începutul acestei luni, senatorii au aprobat o iniţiativă legislativă care prevede ca persoanele care sunt eliberate din închisoare şi care provin din categorii defavorizate să beneficieze de o serie de facilităţi în scopul integrării sociale, printre care alocaţie de hrană şi un lo

LIGA I. Dinamo se duce pe TOBOGAN. „Câinii”, ÎNVINȘI de FC Botoşani. Un jucător este DEMOLAT: „Ăsta e terorist, un terorist al fotbalului”
evz.ro - Bucureşti
Dinamo a fost învinsă, luni, în deplasare, de FC Botoşani, scor 0-2, în ultima confruntare din etapa a 11-a a campionatului intern....

România participă la Ziua Internaţională a Reciclării Deşeurilor Electrice
www.gorjeanul.ro - Gorj
Ziua Internaţională a Reciclării Deşeurilor Electrice este organizată pentru prima dată pe 13 octombrie 2018 pentru a promova colectarea selectivă a echipamentelor electrice şi electronice din întreaga lume. Campania a fost iniţiată de WEEE Forum, asociaţia internaţională a sistemelor

Petrolul Bustuchin, încă o victorie mare
www.gorjeanul.ro - Gorj
Campioana judeţeană de anul trecut, Petrolul Bustuchin, îşi continuă parcursul foarte bun din ultima vreme. După ce au eliminat formaţia din Fărcăşeşti în Cupă, petroliştii i-au învins pe vulturi şi în campionat, redobândindu-şi astfel statul de echipă care trage la promovare. Pe

Amendată pentru că a vândut alcool lângă secţia de votare
www.gorjeanul.ro - Gorj
Administratorul unui magazin din comuna Logreşti a fost sancţionat, pentru că nu a respectat legea şi a vândut băuturi alcoolice, deşi se afla la aproximativ 100 de metri distanţă de o secţie de votare, la referendumul pentru familie. ”La data de 6 octombrie, poliţiştii din cadrul IPJ

Note de lectură – STRIGĂT
www.gorjeanul.ro - Gorj
O carte a unui fost deţinut politic şi luptător în Rezistenţa anticomunistă timp de 40 de aniA scrie despre a treia carte a Domnului Sergiu Mischie nu e uşor.Am citit-o şi pe aceasta ca pe un document lăsat urmaşilor săi ca pe o carte de istorie, un Strigăt în pustie despre Român

Gorun, mulţumit de startul handbaliştilor
www.gorjeanul.ro - Gorj
UCB Târgu Jiu a fost învinsă de către CSM Şcolar Reşiţa, 36-31 (16-15) în runda cu numărul 3 a Seriei C din eşalonul doi handbalistic. Gorjenii au ajuns la două înfrângeri în campionat, contabilizând şi un succes pe teren propriu. Cu toate acestea, având în vedere lipsa de experien

Mii de români, interesaţi de soarta pădurilor virgine
www.gorjeanul.ro - Gorj
Aplicaţia lansată, săptămâna trecută, de organizaţia Greenpeace pentru monitorizarea pădurilor virgine din România are deja peste 2300 de utilizatori, de ieri aceasta fiind valabilă şi pentru utilizatorii de IOS. Până acum aplicaţia era disponibilă doar în Google Play şi este intere

Șofer beat, prins în timp ce conducea un moped
www.gorjeanul.ro - Gorj
Un bărbat de 46 de ani, din comuna Mătăsari, riscă să ajungă după gratii. Acesta a fost depistat de poliţişti, duminică, în timp ce conducea un moped, aflându-se în stare avansată de ebrietate. ”Poliţiştii din cadrul Poliţiei Oraşului Turceni au oprit în trafic un moped condus d

256 de cazuri de meningite/meningoencefalite, cauzate de infecţia cu virusul West Nile
www.gorjeanul.ro - Gorj
Un număr de 256 de cazuri de meningite/meningoencefalite cauzate de infecţia cu virusul West Nile şi 36 de decese au fost înregistrate până în prezent, conform datelor furnizate Ministerului Sănătăţii de către Centrul Naţional de Supraveghere şi Control al Bolilor Transmisibile. În ul

Turiştii, aşteptaţi pe Transalpina şi în octombrie
www.gorjeanul.ro - Gorj
Luna octombrie a debutat cu condiţii meteorologice bune pentru plimbări în aer liber. Tocmai de aceea, iubitorii muntelui sunt aşteptaţi şi în acest weekend la Rânca şi pe Transalpina, pentru a admira peisaje de toamnă şi a se bucura de un sfârşit de săptămână relaxant, în natură.

Gemene născute prematur, preluate de două elicoptere SMURD
www.gorjeanul.ro - Gorj
Două fetiţe nou-născute prematur la spitalul din Târgu-Jiu au fost transportate la Timişoara, ieri, cu două elicoptere SMURD, unul de la Craiova şi celălalt de la Arad. Gemenele suferă de insuficienţă respiratorie şi nu au putut fi transportate cu acelaşi elicopter, pentru că nu aveau

Drumarii au început toaletarea arborilor din vecinătatea şoselelor
www.gorjeanul.ro - Gorj
Secţia Drumuri Naţionale Târgu-Jiu a început activităţile de toaletare şi eliminare a arborilor din vecinătatea şoselelor. La sfârşitul săptămânii trecute s-a intervenit pe DN 67D pe tronsonul Arcani – Tismana.Reprezentanţii Secţiei Drumuri Naţionale (SDN) Târgu-Jiu au identi

ADEVĂRATA lovitură pentru Liviu Dragnea ABIA ACUM vine: Nu se aştepta la asta
evz.ro - Bucureşti
Rezultatele slabe de la Referendum ascund o lovitură încă şi mare pentru preşedintele PSD: Dragnea a fost trădat de baronii locali, iar acest lucru s-ar put...

SE SCHIMBĂ HARTA Europei: “Independenţa va fi o certitudine”. Țara care vrea să se rupă
evz.ro - Bucureşti
Viitorul Scoţiei va fi stabilit imediat după acordul pentru Brexit. “Cred că independenţa va fi o certitudine,” a declarat Nicola Sturgeon, prim-ministrul s...

Slujire Arhierească la Sărbătoarea Spitalului Orăşenesc de Urgenţă din Târgu-Cărbuneşti, Gorj
www.gorjeanul.ro - Gorj
Sâmbătă, 6 octombrie 2018, în prezenţa Înaltpreasfinţitului Părinte dr. Irineu, Arhiepiscopul Craiovei şi Mitropolitul Olteniei, a reprezentanţilor administraţiei publice locale şi judeţene, a salariaţilor şi a unui număr însemnat de invitaţi, a celor care au slujit în decursul an

Doi tineri au fost tăiaţi cu briceagul, în timpul unui conflict la Rovinari
www.gorjeanul.ro - Gorj
Un conflict a izbucnit, duminică seara, între mai multe persoane, într-o parcare din oraşul Rovinari. Doi tineri au ajuns la spitalul din localitate, în urma altercaţiei în care ar fi fost tăiaţi cu un briceag. După ce au fost stabilizaţi, unul dintre ei a fost transportat la Secţia Chir

Băleşti 2018 – sărbătorirea persoanelor vârstnice
www.gorjeanul.ro - Gorj
Ziua Internaţională a Persoanelor Vârstnice este marcată în fiecare an la 1 octombrie pentru promovarea drepturilor persoanelor de vârsta a treia, prin încurajarea de a participa activ la viaţa economică, politică, socială şi culturală, dar şi pentru promovarea unei imagini pozitive a

Regretul profund al lui Ponta pentru PSD
www.gorjeanul.ro - Gorj
Nevalidarea referendumului, desfăşurat timp de două zile la sfârşitul săptămânii trecute, l-a făcut pe Victor Ponta să mărturisească un “regret profund” pe care îl are pentru fostul partid pe care l-a condus. Deputatul de Gorj a făcut o analiză a reacţiilor pe care le-a avut PSD,

Din 22 octombrie se primesc cereri pentru ajutoarele de încălzire
www.gorjeanul.ro - Gorj
Şi în acest an, mii de târgujieni vor beneficia de ajutorul de încălzire acordat de Direcţia Publică de Protecţie Socială (DPPS).Cererile vor fi depuse începând cu 22 octombrie la Cluburile vârstei a treia din Târgu-Jiu. “Cererile pentru acordarea ajutoarelor de

Ca la noi, la nimeni – Scandaluri imense după eşecul Referendumului!
www.gorjeanul.ro - Gorj
Duminică seară, n-aş fi avut posibilitatea să ştiu cu exactitate rezultatele Referendumului pentru redefinirea familiei, ca una formată din bărbat şi soţie şi, dacă dă Bunul Dumnezeu, copii. Datele de la ora 16,00 nu erau deloc optimiste şi, din păcate, s-au cheltuit vreo 40 de milioan

Ronaldo încasează lovitură după lovitură
evz.ro - Bucureşti
Scandalul izbucnit în jurul lui Cristiano Ronaldo ia amploare pe zi ce trece. Acuzat că ar fi violat-o pe Kathryn Mayorga, în 2009, la Las Vegas, portughezu...

Celebritatea ca un sport sîngeros. Reflexul de cultură
evz.ro - Bucureşti
Sînt multe teoii despre motivele asasinării regelui macedonean Filip al II-lea, în 336 ÎdC. Se zice că asasinul, Pausanias din Orestis, unul dintre bodyguar...

Marţi 9 octombrie
evz.ro - Bucureşti
Nr. 834125 de pagini 2,8 lei ...

Referendumul a fost ultimul pas spre privatizarea credinţei! EXCUSIV EVZ
evz.ro - Bucureşti
Părintele Eugen Tănăsescu, consilierul de comunicare al Arhiepiscopiei Tomisului, a spus pentru EVZ că acest rezultat „este, într-un fel, logic, pentru că d...

Părerea lui Terente
evz.ro - Bucureşti
Părerea lui Terente...

Replici dure între Toader şi Lazăr la CSM, pe seama protocoalelor
evz.ro - Bucureşti
Războiul verbal dintre ministrul Justiţiei, Tudorel Toader, şi procurorul general al României, Augustin Lazăr, a continuat, ieri, în plină şedinţă a CSM, un...

„Duşmanii Europei s-au baricadat în buncărul de la Bruxelles”
evz.ro - Bucureşti
Marine Le Pen şi aliatul său Matteo Salvini, alături de aliaţii lor europeni, speră să răstoarne echilibrul din Parlamentul European. ...

La Maramureş se fac gogoşi cu bormaşina
evz.ro - Bucureşti
Un comerciant cu un stand stradal autorizat de Primăria Baia Mare să participe la Festivalul Castanelor, care e încă în desfăşurare, a fost amendat cu 30.00...

Corina Creţu, mesaj dur pentru Guvernul României
evz.ro - Bucureşti
Comisarul european pentru politică regională, Corina Creţu, a afirmat, ieri, că nu mai acceptă insulte din partea Guvernului României, în contextul în care ...

Când ucideţi de tot şi Centenarul? Editorial de Florian Bichir
evz.ro - Bucureşti
De vreo şase ani de când activez drept cadru didactic universitar m-am obişnuit participarea la conferinţele ştiinţifice. La început, naiv mergeam la toate....

ACUM! Accident la Maracineni
ziarulargesul.ro - Argeş
Cu cateva momente in urma s-a produs un accident rutier la Maracineni, intersectia cu Colibasi. Din informatiile noastre, doua dintre vehiculele implicate in accident au fost un BMW gri inchis si o duba galbena(foto). Circulatia a fost blocata spre Campulung. Revenim cu detalii. Foto Info Trafic...

Caz REVOLTĂTOR! BEBELUȘ ţinut în PUNGĂ 10 ORE. DOCTORII au CREZUT că este MORT
evz.ro - Bucureşti
O femeie din Prahova acuză doctorii de la spitalul din Câmpina au incinerat bebeluş acesteia născut prematur, fără să i se facă autopsia....

Lovitură pentru Google. O mare reţea de socializare a fost închisă
evz.ro - Bucureşti
Gigantul Google a închis Google+ după ce datele a peste 500.000 de utilizatori au fost expuse. ...

UMILINȚĂ pentru PSD! Victor Ponta dă de pământ cu partidul lui Dragnea
evz.ro - Bucureşti
Fostul premier Victor Ponta a precizat că cele două legende prin care PSD trăia, au dispărut. Prima a dispărut din cauza „guvernului penibil”, iar ce-a de a...

Diversiunea RO-EXIT. Ce se ascunde în spatele acestei ştiri FLASE
evz.ro - Bucureşti
Victor Negrescu, ministrul delegat pentru Afaceri Europene a afirmat luni că Ro-Exit este o idee falsă lansată în societatea românească pentru a „stârni con...

Elena Udrea cere ajutorul Ambasadei României la Mexic
www.stiridecluj.ro - Cluj
Iubitul Elenei Udrea, Adria Alexandrov, a declarat că că arestarea ei şi a Alinei Bica ...

Noi parcuri în Lunca Argeşului?
ziarulargesul.ro - Argeş
Primăria Piteşti are în plan amenajarea a două noi parcuri în zona Căii Depozitelor, respectiv Lunca Argeşului II şi III. Fiecare dintre cele două parcuri va costa 4 milioane euro, bani europeni (procedura este în derulare). Conform proiectelor, cele două parcuri vor avea 22 hectare - primul -...

FOTO – Bazinul Olimpic, inchis de aproape trei luni. Reprezentanti LPS Baia Mare: “Iar se pierd generatii de potentiali campioni”
ziarmm.ro - Maramureş
Bazinul Olimpic "Gheorghe Demeca" din Baia Mare este inchis de aproape trei luni pentru reparatii. Acest lucru provoaca insa nemultumiri in mediul sportiv din oras. Reprezentanti ai LPS Baia Mare afir

Sibiu 100. Centenarul României Mari – Academia Forţelor Terestre Nicolae Bălcescu – Partener strategic al evenimentului
www.oradesibiu.ro - Sibiu
Primăria Municipiului Sibiu în parteneriat cu Academia Forţelor Terestre Nicolae Bălcescu Sibiu şi firma Continental Automotive Systems au organizat sâmbătă, 6 octombrie, în Piaţa Mare din Sibiu…

Filmele româneşti obligatoriu subtitrate – Toate televiziunile sunt obligate
www.oradesibiu.ro - Sibiu
Un proiect care s-a aflat în stadiu de propunere legislativă, a fost parafat de Senatul României. Televiziunile sunt obligate să subtitreze şi filmele în limba română. Senatul a adoptat, luni…

Ziua educaţiei, la Poarta Eroilor
ziarulargesul.ro - Argeş
Vineri, 5 octombrie, de Ziua Educaţiei, elevii clasei a IX-a K de la Colegiul Naţional "Ion C. Brătianu" Piteşti au luat cunoştinţă de faptele de arme ale eroilor Regimentului 4 Dorobanţi Argeş, căzuţi în Primul Război Mondial. Lecţia de istorie a fost susţinută de profesorul Constantin...

Elena Udrea cere ajutorul Ambasarei României la Mexic
www.stiridecluj.ro - Cluj
Iubitul Elenei Udrea, Adria Alexandrov, a declarat că că arestarea ei şi a Alinei Bica ...

Piaţa Primăriei – în dezbatere publică
ziarulargesul.ro - Argeş
Pe 16 octombrie, la Piteşti, va fi organizată o dezbatere publică privind modernizarea Pieţei Primăriei. Municipalitatea propune lucrări de amploare, prin care o zonă reprezentativă a oraşului va fi reconfigurată. În şedinţa Consiliului Local din 18 octombrie vor fi prezentate imagini cu...

Cardul de sănătate şi seminţele de scandal
ziarulargesul.ro - Argeş
Cu luni de zile în urmă am publicat în acest colţ de pagină tableta cu titlul "Cardul de sănătate şi carul de nervi". De atunci şi până azi, la fel ca micile porţiuni de autostradă care se strică la puţin timp după ce au fost cu tam-tam inaugurate, când ţi-e lumea mai dragă, sistemul...

Senatorul Resmeriţă, la final de referendum: „Democraţia costă!”
glasul-hd.ro - Hunedoara
Cristian Resmeriţă, senator de Hunedoara şi preşedinte executiv al organizaţiei judeţene a PSD consideră că e incorect ca partidul din care face parte să fie considerat răspunzător pentru eşecul referendumului de sâmbătă şi duminică. Mai mult, Resmeriţă spune că organizarea consultării populare era necesară, în ciuda costurilor acesteia, pe motiv că, în orice ţară dezvoltată …

Patru MasterChefi din Franţa şi Portugalia identifică gastronomia regională în judeţ
glasul-hd.ro - Hunedoara
Vizite la producătorii locali, degustare de produse tradiţionale sau identificarea gastronomiei regionale din judeţ sunt doar câteva acţiuni desfăşurate de şapte cadre didactice din Franţa şi Portugalia, dintre care patru MasterChefi, săptămâna aceasta în judeţ. Totul are loc în cadrul proiectului Erasmus + intitulat „Identites gastronomiques regionales et mondialisation” (Identificarea gastronomiei regionale şi globalizarea acesteia). …

DIAVOLUL DIN SIBERIA a fost descoperit. CREATURA URIAȘĂ i-a uluit pe oamenii de ştiinţă. În viaţa lor N-AU VĂZUT CEVA SIMILAR...
evz.ro - Bucureşti
Un monstru marin a fost descoperit pe fundul lacului Labynkyr din Siberia. Cercetătorii ruşi susţin că descoperirea este cu atât mai importantă cu cât s-au ...

Fabricile de mezeluri au SECRETE FOARTE MURDARE. UN ANGAJAT A VORBIT: „Pasta aceea este amestecată cu apă, multă sare şi tot felul de prafuri”
evz.ro - Bucureşti
Mezelurile sunt printre cele mai accesibile, din punct de vedere al preţurilor practicate de comercianţi, produse alimentare de pe piaţa românească. Pe lâng...

Rezultate interesante în etapa a şasea din Liga a patra
glasul-hd.ro - Hunedoara
Campionatul Judeţean de Fotbal al Ligii a patra Hunedoara a programat în week-end partidele rundei cu numărul 5, ceea ce înseamnă că ne apropiem de mijlocul turului în acest sezon 2018 – 2019. Aşa cum anticipam în avancronica etapei, am avut parte atât de meciuri cu deznodământul aşteptat, cât şi de surprize, mai ales prin …

Victorie în faţa ultimei clasate pentru Energeticianul
glasul-hd.ro - Hunedoara
Singura formaţie de liga a doua din judeţ, Energeticianul din Petroşani, se prezenta la partida de sâmbătă cu Dacia Unirea Brăila după două înfrângeri, un 1 – 2 la Miercurea Ciuc cu Csikszereda în Cupa României şi un 0 – 1 la Năvodari cu Farul Constanţa în campionat. Aflată departe de locurile fruntaşe, cu un …

Acţiune de colectare a deşeurilor la Deva
glasul-hd.ro - Hunedoara
Devenii au ocazia să scape corect de deşeurile de echipamente electrice şi electronice, trimiţându-le la reciclare. Totul în cadrul unei acţiuni de colectare a deşeurilor, care va avea loc în perioada 12-13 octombrie, în Deva. Acţiunea, organizată de Primăria Deva şi Serviciul Local de Colectare Hunedoara, are caracter educativ şi este susţinută de Asociaţia Română …

Telecabina de la Cetatea Devei este în revizie tehnică
glasul-hd.ro - Hunedoara
Turiştii care au dorit să viziteze Cetatea Devei ieri, au putut-o face doar la pas pentru că începând de luni telecabina care facilitează accesul turiştilor în Cetatea Devei se află în revizia tehnică lunară. Ascensorul va fi repus în funcţiune mâine, 10 octombrie 2018, începând cu ora 8:00, şi va funcţiona conform programului normal, adică …

Disproporţie impresionantă la votul din Hunedoara: mai bine de 90 la sută dintre participanţi au spus „DA”
glasul-hd.ro - Hunedoara
Biroul Electoral de Circumscripţie Hunedoara a publicat ieri rezultatele finale ale referendumului pentru familia tradiţională. Dintre cei prezenţi la vot, o proporţie covârşitoare a votat pentru modificarea Constituţiei, astfel încât aceasta să precizeze clar faptul că o căsătorie poate avea loc doar între un bărbat şi o femeie (lucru specificat, totuşi, în Codul Civil). Dintre …

Sare-n ochi
glasul-hd.ro - Hunedoara
În urmă cu 95 de ani (100 – n.red.), Iuliu Maniu semna cu sufletul îndoit memorandumul prin care românii ardeleni cereau unirea cu Regatul. La 20 de ani după unire, lucrurile nu erau aşa cum le-au visat „fraţii” din fostul Imperiu, ceea ce l-a determinat pe Maniu să-i adreseze un memorandum regelui Carol al II-lea. …

Sporting Crişcior, RGI & ECP şi Universitatea Viile Noi – lideri în cele trei ligi ale Campionatului Realsport
glasul-hd.ro - Hunedoara
Campionatul Realsport de minifotbal Deva a continuat la sfârşitul săptămânii trecute cu meciurile etapei a doua din Ligile A, B şi C. Să spunem că în momentul de faţă sunt nouă echipe cu maximum de puncte şi tot nouă formaţii care nu au acumulat încă nici un punct (deşi mai trebuie ţinut cont şi de …

Perechea romano-elvetiana Irina Bara-Xenia Knoll, calificata in sferturile de finala de la Linz
www.ziuaconstanta.ro - Constanţa
Perechea alcatuita din jucatoarea romana de tenis Irina Bara si elvetianca Xenia Knoll s-a calificat, luni, in sferturile de finala ale probei de dublu din cadrul turneului WTA de la Linz Austria , ...

ANTONESCU a făcut o DECLARAȚIE surprinzătoare despre PSD: „DRAGNEA nu trebuie să îşi dea DEMISIA”
evz.ro - Bucureşti
Fostul preşedinte al PNL, Crin Antonescu, a declarat, într-o intervenţie la România TV, că eşecul referendumul nu trebuie Dragnea...

Filmele româneşti obligatoriu subtitrate – Toate televiziunile sunt obligate
infonews.oradesibiu.ro - Sibiu
Un proiect care s-a aflat în stadiu de propunere legislativă, a fost parafat de Senatul României. Televiziunile sunt obligate să subtitreze şi filmele în limba română. Senatul a adoptat, luni…

Dragnea ARE UN STRATEG CELEBRU lângă el? Omul a apărut la TVR şi A JURAT PE BIBLIE. Câteva cuvinte, zeci de sensuri
evz.ro - Bucureşti
Mircea Dinescu a venit cu Biblia în emisiunea lui Ionuţ Cristache de la TVR1.Dinescu a susţinut că nu este apropiat lui Dragnea, aşa cum s-a spus la anumite...

Dulcegarii intre feline
www.ziuaconstanta.ro - Constanţa
Merge acasa motanul impreuna cu iubita lui, dupa o noapte plina de evenimente. Motanul nu se poate stapani si miauna - Oh, iubita mea, as muri pentru tine! Pisicuta ii arunca o privire incantata ...

Deputat PSD: Homosexuali se nasc aşa cum un om se naşte cu o maladie, cu o problemă medicală
www.stiridecluj.ro - Cluj
Deputat PSD: Homosexuali se nasc aşa cum un om se naşte cu o maladie, cu o problemă medicală

Ion Cristoiu: „Corina Creţu s-a răţoit la România”
evz.ro - Bucureşti
Comisarul European Corina Creţu a criticat, luni, Guvernul României de lipsa proiectelor pe fonduri europene, deşi există bani....

Stiati ca…? Fostul fotbalist Gica Popescu implineste astazi 51 de ani
www.ziuaconstanta.ro - Constanţa
Gheorghe Popescu, cunoscut mai ales ca Gica Popescu n. 9 octombrie 1967, Calafat este un fost fotbalist roman, actualmente impresar. Potrivit Wikipedia.org, Popescu a participat cu echipa nationala de ...

Stiati ca…? Fostul fotbalist Gica Popescu implineste astazi 51 de ani
www.ziuaconstanta.ro - Constanţa
Gheorghe Popescu, cunoscut mai ales ca Gica Popescu n. 9 octombrie 1967, Calafat este un fost fotbalist roman, actualmente impresar. Potrivit Wikipedia.org, Popescu a participat cu echipa nationala de ...

Ligile a 5-a si a 6-a. Rezultate si clasamente: FC Farul Constanta disputa marti restanta cu CS Navodari
www.ziuaconstanta.ro - Constanţa
Stadionul ITC din Constanta gazduieste marti, 9 octombrie, dubla intalnire FC Farul Constanta - CS Navodari, restanta din etapa intai a Ligii a 4-a de fotbal a judetului Constanta. De la ora 13.00, se ...

Trei tineri handbalisti de la Dobrogea Sud Constanta au debutat in cupele europene cu ocazia intalnirii cu Talent Robstav MAT Plzen
www.ziuaconstanta.ro - Constanţa
Echipa masculina de handbal HC Dobrogea Sud Constanta s-a calificat in turul trei al Cupei EHF, dupa ce a trecut, cu o dubla victorie, de formatia Talent Robstav MAT Plzen. Ambele partide din turul doi ...

Societatea Taverna Constanta va avea asociat unic. Cine s-a retras din firma
www.ziuaconstanta.ro - Constanţa
Societatea Taverna Constanta SRL a luat mai multe decizii in cadrul Adunarii Generale a Asociatilor. Astfel, Dragan Caranovic, Didu Marian, Aurelian Cacenco si Virgil Jichitu-Siticov, cel din urma fiind ...

Spatiile comerciale din Spitalul Judetean Constanta, scoase la licitatie
www.ziuaconstanta.ro - Constanţa
Spitalul Clinic Judetean de Urgenta Sf. Apostol Andrei Constanta anunta ca organizeaza licitatie publica deschisa pentru inchirierea unor spatii aflate in administrarea unitatii spitalicesti, ...

Un nou imobil rasare“ in Mamaia Nord. Investitorul modifica proiectul pentru a mai amenaja un etaj (document)
www.ziuaconstanta.ro - Constanţa
Societatea Pirates Home SRL a depus la Agentia pentru Protectia Mediului Constanta un memoriu de prezentare pentru modificarea unui proiect in timpul executiei. Este vorba de investitia Modificare ...

OMV Petrom, gata sa sape doua noi sonde de exploatare. Unde sunt localizate
www.ziuaconstanta.ro - Constanţa
OMV Petrom SA - zona de productie X, Petromar Constanta a solicitat de la Agentia pentru Protectia Mediului Constanta acord de mediu pentru proiectul Saparea sondelor de exploatare L4 Lebada Est gaura ...

Liber la supraetajarea unui imobil: Sotii Claudiu si Carmen Nedu au primit raspuns de la APM Constanta
www.ziuaconstanta.ro - Constanţa
Claudiu si Carmen Nedu, care au depus la Agentia pentru Protectia Mediului Constanta memoriul tehnic de prezentare a proiectului Modificare proiect in curs de executie autorizat cu AC 99 21.02.2018 prin ...

Spitalul Militar Constanta cumpara medicamente pentru diabet. Cine sunt furnizorii (document)
www.ziuaconstanta.ro - Constanţa
Ministerul Apararii Nationale a publicat numele agentilor economici care si-au adjudecat contractul privind livrarea de medicamente pentru diabet insulina pentru Unitatea Militara 02175 Spitalul ...

Accident mortal in Mamaia! Autorul, pus in libertate
www.ziuaconstanta.ro - Constanţa
Curtea de Apel Constanta a decis punerea in libertate a unui tanar de 26 de ani, din Cernavoda, suspectat ca a accidentat mortal o femeie care traversa pe o trecere de pietoni din statiunea Mamaia. Decizia ...

Admitere in magistratura: Trei constanteni au fost declarati admisi. Unul are identitatea protejata
www.ziuaconstanta.ro - Constanţa
Institutul National al Magistraturii a dat publicitatii tabelul cu rezultatele obtinute de candidati la etapa eliminatorie din cadrul concursului de admitere in magistratura, din perioada 10 iulie - 16 ...

Politia Locala a amendat Electrocentrale Constanta
www.ziuaconstanta.ro - Constanţa
Electrocentrale Constanta SA a inregistrat pe rolul Judecatoriei Constanta, la inceputul acestei luni, dosarul 26937 212 2018, care are ca obiect o plangere contraventionala. Parat in dosar este Directia ...

CFR Constanta da in chirie spatii. Detalii
www.ziuaconstanta.ro - Constanţa
Compania Nationala de Cai Ferate CFR SA - Sucursala Regionala CF Constanta, divizia comerciala - Serviciul Valorificari Active anunta organizarea, pe 25 octombrie, la ora 12, la sediul Sucursalei ...

CNE Cernavoda a solicitat aviz pentru demolarea unor decantori. Iata motivul invocat! (document)
www.ziuaconstanta.ro - Constanţa
Societatea Nuclearelectrica Cernavoda a solicitat de la Agentia pentru Protectia Mediului avizul de mediu necesar pentru implementarea proiectului Demolare decantori 0-7061-TK 2.1 TK 2.2 TK 2.3, in zona ...

Asfaltari in Palazu Mare. Iata unde urmeaza sa intervina Confort Urban! (document)
www.ziuaconstanta.ro - Constanţa
Primaria Municipiului Constanta, prin Confort Urban, a depus la Agentia pentru Protectia Mediului Constanta un memoriu de prezentare pentru eliberarea avizului de mediu aferent proiectului de Amenajare ...

Opal Construct va furniza o ambarcatiune gonflabila Centrului de Scafandri Constanta (document)
www.ziuaconstanta.ro - Constanţa
Ministerul Apararii Nationale - Unitatea Militara 02145 Constanta Centrul de Scafandri a semnat cu societatea Opal Construct SRL, care si-a adjudecat contractul de furnizare a unei ambarcatiuni ...

Actionarii Aeroportului International Mihail Kogalniceanu Constanta, convocati in sedinta. Proiecte importante pe ordinea de zi
www.ziuaconstanta.ro - Constanţa
Presedintele Consiliului de Administratie al Societatii Nationale Aeroportul International Mihail Kogalniceanu Constanta SA convoaca Adunarea Generala Ordinara a Actionarilor, pentru data de ...

Ordinea de zi a sedintei ordinare a actionarilor CN APM Constanta de la sfarsitul lunii, completata. Ce subiect important va fi adus in atentie
www.ziuaconstanta.ro - Constanţa
Compania Nationala Administratia Porturilor Maritime SA Constanta a anuntat completarea ordinii de zi a sedintei ordinare a actionarilor, convocata in data de 29 octombrie, la Ministerul ...

Contract fabulos pentru intretinerea drumurilor din judetul Constanta si a Autostrazii A2. Cine efectueaza lucrarile (document)
www.ziuaconstanta.ro - Constanţa
Compania Nationala de Administrare a Infrastructurii Rutiere SA, prin Directia Regionala de Drumuri si Poduri Constanta, a atribuit un contract pentru achizitia de lucrari de intretinere periodica ...

SSC Farul revine acasa! Miercuri, meci cu U Cluj: Vocile voastre sa fie din nou auzite la unison, pe stadionul unde s-a scris istorie“
www.ziuaconstanta.ro - Constanţa
SSC Farul Constanta revine acasa, pe stadionul Farul , de miercuri, 10 octombrie, de la meciul cu Universitatea Cluj. Partida, prima sustinuta de marinari pe arena din str. Primaverii in Liga a 2-a, va ...

ARR. Ce venituri a avut Danut Marian Trandafir, director Coordonare Agentii din Teritoriu (document)
www.ziuaconstanta.ro - Constanţa
Danut Marian Trandafir este director Coordonare Agentii din Teritoriu in cadrul Autoritatii Rutiere Romane. La data de 5 iunie 2018 si-a depus declaratia de avere. Astfel, directorul are un teren ...

O firma din Timisoara elaboreaza proiectul de reamenajare a parcului de la Teatrul National de Opera si Balet Oleg Danovski“
www.ziuaconstanta.ro - Constanţa
Primaria Constanta a atribuit un contract pentru serviciul de elaborare DALI inclusiv documentatii avize, studii topo, geo si expertiza tehnica pentru obiectivul de investitii Reamenajarea spatiului ...

Director de institutie, trimis in judecata de DNA Constanta. Dosarul a primit un nou termen
www.ziuaconstanta.ro - Constanţa
Tribunalul Tulcea a acordat un nou termen in dosarul in care Iuliana Lefter, fost director executiv al Agentiei Judetene pentru Ocuparea Fortei de Munca Tulcea, a fost trimisa in judecata de procurorii ...

Deputatul Stelian Ion - Guvernul ar trebui sa ia in considerare toate recomandarile facute de Comisia de la Venetia!“
www.ziuaconstanta.ro - Constanţa
In cadrul unui interviu acordat RFI, deputatul USR Stelian Ion a sustinut ca Executivul condus de Viorica Dancila ar trebui sa includa in OUG pe justitie TOATE recomandarile facute de expertii ...

Eveniment dedicat educatiei, la Casa de Cultura din Constanta. Targul ofertelor educationale Știu sa imi aleg meseria“ si-a deschis portile (galerie foto)
www.ziuaconstanta.ro - Constanţa
Ieri, ISJ Constanta a dat startul targului de toamna al ofertelor educationale din invatamantul profesional Stiu sa imi aleg meseria , aflat la cea de-a treia editie. Evenimentul este gazduit de Casa ...

Cum vrea sa-si sporeasca veniturile CN APM Constanta: Insula si chei de acostare pentru nave mari. Detalii din proiect (document)
www.ziuaconstanta.ro - Constanţa
Compania Nationala Administratia Porturilor Maritime SA Constanta a solicitat de la Agentia pentru Protectia Mediului Constanta acord de mediu pentru proiectul Dezvoltarea insulei - cheu de acostare pe ...

Cum vrea sa-si sporeasca veniturile CN APM Constanta: Insula si chei de acostare pentru nave mari. Detalii din proiect (document)
www.ziuaconstanta.ro - Constanţa
Compania Nationala Administratia Porturilor Maritime SA Constanta a solicitat de la Agentia pentru Protectia Mediului Constanta acord de mediu pentru proiectul Dezvoltarea insulei - cheu de acostare pe ...

La 68 de ani, celebrul culturist Vasile Serban a cucerit al 14-lea titlu de campion national! (galerie foto)
www.ziuaconstanta.ro - Constanţa
Celebrul culturist veteran din Navodari Vasile Serban si-a confirmat valoarea si la editia 2018 a Campionatului National, care s-a desfasurat la Sibiu. In varsta de 68 de ani, sportivul a concurat, ...

Analele Dobrogei“ - tematica; particularitati
www.ziuaconstanta.ro - Constanţa
In anul 1920, la Constanta se infiinteaza, sub conducerea profesorului Constantin Bratescu si a avocatului Ioan N. Roman, Societatea de cultura dobrogeana . Programul societatii prevedea, la primul ...

Interceptari: Condamnarea unui medic! Doi ani de inchisoare cu suspendare, pentru mita
www.ziuaconstanta.ro - Constanţa
Un medic ortoped a fost condamnat de judecatorii Curtii de Apel Bucuresti la doi ani de inchisoare cu suspendarea sub supraveghere, pentru savarsirea infractiunii de luare de mita. Decizia este ...

20 de milioane de euro in ultimii 16 ani. Pomacost, contract subsecvent cu Primaria Constanta. Cat costa hibernarea pentru fiecare palmier din Mamaia (documente)
www.ziuaconstanta.ro - Constanţa
Municipalitatea a semnat, la inceputul lunii septembrie, un contract cu Pomacost SA privind achizitia serviciului de intretinere palmieri existenti in municipiul Constanta . Firma se obliga sa presteze ...

20 de milioane de euro in ultimii 16 ani. Pomacost, contract subsecvent cu Primaria Constanta. Cat costa hibernarea pentru fiecare palmier din Mamaia (documente)
www.ziuaconstanta.ro - Constanţa
Municipalitatea a semnat, la inceputul lunii septembrie, un contract cu Pomacost SA privind achizitia serviciului de intretinere palmieri existenti in municipiul Constanta . Firma se obliga sa presteze ...

Senatul a aprobat. Filmele romanesti vor fi subtitrate pentru persoanele cu deficiente de auz
www.ziuaconstanta.ro - Constanţa
Senatul a adoptat, luni, in calitate de Camera decizionala, in unanimitate 97 de voturi pentru , o propunere legislativa pentru completarea unui articol din Legea audiovizualului nr. 504 2002, prin care ...

Ion Cristoiu: „Trebuie să facem diferenţă între a te duce la vot şi a spune să ieşi la vot”
evz.ro - Bucureşti
Ion Cristoiu a susţinut, luni, la TVR1, că Ludovic Orban nu a îndemnat lumea să iasă la vot, în contextul în care liderul liberalilor a fost acuzat din inte...

Oamenirea, în pericol. MOLIMA molimelor POATE SECERA SUTE DE MILIOANE rapid. Alertă mondială de sănătate
evz.ro - Bucureşti
Condiţiile climatice, modul de viaţă şi îmbătrânirea polupaţiei la nivel mondial sunt doar câteva condiţii care ar putea să favorizeze apariţia unei pandemi...

REVOLTĂ la o echipă din fotbalul românesc. Fanii au luat cu asalt cantonamentul: „Luaţi-o drept un ultimatum: ori vă treziţi, ori plecaţi”
evz.ro - Bucureşti
Suporterii echipei FC „U” Craiova au transmis mesaje de ameninţare jucătorilor, după înfrângerea cu Flacăra Horezu, scor 0-2. ...

Detalii neştiute! Ce pensie are Nadia Comăneci?
evz.ro - Bucureşti
Nadia Comăneci este prima gimnastică din lume care a primit nota 10 într-un concurs olimpic de gimnastică. Este considerată a fi una dintre cele mai bune sp...

DIAVOLUL din SIBERIA a fost DESCOPERIT. CREATURA este URIAȘĂ
evz.ro - Bucureşti
Un monstru marin a fost descoperit pe fundul lacului Labynkyr din Siberia. Cercetătorii ruşi susţin că descoperirea este cu atât mai importantă cu cât s-au ...

Daniel Stanciu vine la CFR Cluj. Alături de el vine şi Copilu. Se se întâmplă cu Mureşan
www.stiridecluj.ro - Cluj
Daniel Stanciu vine la CFR Cluj. Alături de el vine şi Copilu. Se se întâmplă cu Mureşan
![[FOTO-VIDEO] Neamţ: Incendiu la un depozit de materiale de construcţii](/showimg/300-200--zi/images/fullinfo.ro-images/news-233189.jpg)
[FOTO-VIDEO] Neamţ: Incendiu la un depozit de materiale de construcţii
www.stiri-neamt.ro - Neamţ
Un incendiu de proporţii a izbucnit în această seară, 8 octombrie, la depozitul de materiale de construcţii „Maluco” din oraşul Târgu-Neamţ. La locul

IUBITUL Elenei UDREA se TEME pentru COPILUL lor. „FETIȚA noastră poate deveni o ȚINTĂ”
evz.ro - Bucureşti
Iubitul Elenei Udrea a făcut dezvăluiri despre arestarea ex-ministrului Turismului şi despre statutul de refugiat provizoriu, într-un interviu acordat Anten...

FOTO Rămas bun, Ştefan Firu! Sute de sibieni la priveghi
www.oradesibiu.ro - Sibiu
Sute de oameni au fost prezenţi luni seara, la Biserica „Buna Vestire” din Sibiu, cunoscută de sibieni ca Biserica din Groapă, pentru a participa la rugăciunea oficiată de un sobor de preoţi…

Unul dintre cei mai cunoscuţi specialişti în domeniul Pedagogiei va primi titlul de Doctor Honoris Causa al Universităţii din Alba Iulia
ziarulunirea.ro - Alba
În această săptămână la Alba Iulia se desfăşoară Conferinţa Naţională „Educaţia din perspectiva valorilor”. În cadrul acesteia, miercuri, ora 12.00, în Amfiteatrul A9 (Aula Magna – UAB) va avea loc Festivitatea de decernare a titlului de Doctor Honoria Causa unuia dintre cei mai cunoscuţi specialişti în domeniul Pedagogiei, distinsul Profesor univ. dr. CONSTANTIN CUCOȘ, căruia […]

Copil de 13 ani, lovit de un autoturism in Valu lui Traian
www.ziuaconstanta.ro - Constanţa
Un copil de 13 ani a fost lovit, luni seara, de un autoturism dupa ce a traversat prin loc nepermis. Potrivit IPJ Constanta, in data de 08.10.2018, ora 19 20, un barbat de 56 ani, a condus un autoturism ...

Jurnalistul Mirel Curea a analizat evenimentele de la Referendum: „PSD a mimat ca să nu şi-o ia de la Bruxelles. Și Biserica a mimat”
evz.ro - Bucureşti
Eşecul referendumului pentru familia tradiţională a pornit ample dezbateri în spaţiul public. Coaliţia pentru Familie a acuzat partidele politice de boicot....

SCANDAL în social media. Ce a ASCUNS Google+ până acum. Sute de mii de utilizatori au fost afectaţi
evz.ro - Bucureşti
După ce au fost dezvăluite datele private a sute de mii de utilizatori, compania Google a decis închiderea reţelei de socializare online Google+. De teama s...

Degringoladă la ING Bank – Ce s-a întâmplat în weekend
infonews.oradesibiu.ro - Sibiu
Clienţii băncii ING au aflat cu stupoare că toate plăţile pe care le-au făcut cu cardul în weekend-ul trecut au fost procesate de două ori de către bancă. Oamenii s-au trezit astăzi că au mai puţini…

Hoţ de lemne reclamat la Scutul Pădurii în Vurpăr
infonews.oradesibiu.ro - Sibiu
Este vorba de un localnic care avea patru carpeni şi nu a putut să arate actele de provenienţă pentru aceste lemne. La data de 5 octombrie, în jurul orei 08,30, pe raza comunei Vurpăr…

Sibiu 100. Centenarul României Mari – Academia Forţelor Terestre Nicolae Bălcescu – Partener strategic al evenimentului
infonews.oradesibiu.ro - Sibiu
Primăria Municipiului Sibiu în parteneriat cu Academia Forţelor Terestre Nicolae Bălcescu Sibiu şi firma Continental Automotive Systems au organizat sâmbătă, 6 octombrie, în Piaţa Mare din Sibiu…

FOTO Rămas bun, Ştefan Firu! Sute de sibieni la priveghi
infonews.oradesibiu.ro - Sibiu
Sute de oameni au fost prezenţi luni seara, la Biserica „Buna Vestire” din Sibiu, cunoscută de sibieni ca Biserica din Groapă, pentru a participa la rugăciunea oficiată de un sobor de preoţi…

VIDEO. Am bătut toate recordurile din Satu Mare. Clipul cu 10 milioane de vizualizări!
portalsm.ro - Satu Mare
VIDEO. Am bătut toate recordurile din Satu Mare. Clipul cu 10 milioane de vizualizări! Cei 14 fraţi care au speriat internetul :)

România a luat aur la Jocurile Olimpice de Tineret la Judo
www.stiridecluj.ro - Cluj
România a luat aur la Jocurile Olimpice de Tineret la Judo

AMENINȚĂRI de la UE. BANII vor fi CONDIȚIONAȚI de INDEPENDENȚA justiţiei. AVERTISMENT pentru fostele ȚĂRI COMUNISTE
evz.ro - Bucureşti
Guvernele fostelor state comuniste vor avea presiuni bugetare de la Bruxelles dacă nu vor respecta regulile unui sistem judiciar independent, UE...

Declaraţii explozive. A venit cu Biblia în direct
evz.ro - Bucureşti
Mircea Dinescu a venit cu Biblia în emisiunea lui Ionuţ Cristache de la TVR1....

Veste ȘOC despre ION ILIESCU! Lovitură DURĂ pentru PSD
evz.ro - Bucureşti
Preşedintele de onoare al PSD, Ion Iliescu, nu a votat la referendumul pentru redefinirea familiei, potrivit celor de la secţia de votare Jean Monnet din Ca...

Ipoteză şoc: PSD a mimat participarea la referendum
evz.ro - Bucureşti
Eşecul referendumului pentru familia tradiţională a pornit ample dezbateri în spaţiul public. Coaliţia pentru Familie a acuzat partidele politice de boicot....

Victor Ponta, despre legea offshore - "Vom vota pentru un proiect de lege care sa permita efectuarea exploatarii"
www.ziuaconstanta.ro - Constanţa
Parlamentarii afiliati partidului Pro Romania vor vota o forma a legii offshore care sa permita efectuarea exploatarii resurselor naturale, a declarat, luni, intr-o conferinta de presa, liderul ...

Unde se afla primul cartier românesc. Informaţii interesante despre oraş în cartea „Românii din Bistriţa”
www.timponline.ro - Bistriţa-Năsăud
(FOTO) Primul volum al cărţii "Românii din Bistriţa", scrisă de prof. univ. Mircea Gelu Buta şi de Adrian Onofreiu de la Arhivele Naţionale, a fost lansat luni seara la Biblioteca Judeţeană "George Coşbuc" în prezenţa unei asistenţe numeroase formată din oameni de cultură şi de afaceri, reprezentanţ

Sibiu 100. Centenarul României Mari – Academia Forţelor Terestre Nicolae Bălcescu – Partener strategic al evenimentului
presasibiu.oradesibiu.ro - Sibiu
Primăria Municipiului Sibiu în parteneriat cu Academia Forţelor Terestre Nicolae Bălcescu Sibiu şi firma Continental Automotive Systems au organizat sâmbătă, 6 octombrie, în Piaţa Mare din Sibiu…

Contraventii: Peste 200 de procese verbale intocmite de Politia Locala Baia Mare intr-o saptamana
ziarmm.ro - Maramureş
In perioada 1-7 octombrie, politistii locali din cadrul Directiei Politia Locala Baia Mare au desfasurat activitati specifice in domeniul asigurarii ordinii si linistii publice, a constructiilor, medi

De ce a eşuat Referendumul? Pentru că PSD a avut interesul să eşueze. România lui Cristoiu
evz.ro - Bucureşti
Neatingerea pragului de 30% la Referendumul din 6-7 octombrie 2018, denumit impropriu Pentru familie, a stîrnit în spaţiul public binecunoscuta gălăgie a da...

IUBITUL lui UDREA rupe TĂCEREA: „NU ne AȘTEPTAM la aşa CEVA”
evz.ro - Bucureşti
Iubitul Elenei Udrea, Adrian Alexandrov, a făcut apeluri repetate şi şi-a exprimat revolta, încă de la arestarea ex-ministrului Turismului....

Melania Trump şi pălăria Panama în Egipt: Şedinţă foto sau vizită diplomatică? Foto în articol
evz.ro - Bucureşti
Pălărie Panama pe cap, balerini de firmă în picioare şi un look masculin. Aşa a apărut celebra first lady americană fotografiată la umbra Piramidelor care p...

DESTĂINUIREA unei apreciate artiste din România. Milioane de fani o REGRETĂ
evz.ro - Bucureşti
Frumoasa artistă româncă Kitty Cepraga a mărturisit că nu de mai întoarce în România, decât ca turist. Pe lângă avtivitatea sa profesională care i-a adus fo...

Senat: 2019 – Anul Cărţii în România (proiect adoptat)
mesageruldecovasna.ro - Covasna
Vrei să fii notificat când apare un articol nou? Abonează-te prin e-mail

Sportivi ai CSM Sf.Gheorghe au obţinut rezultate bune în Germania
mesageruldecovasna.ro - Covasna
Vrei să fii notificat când apare un articol nou? Abonează-te prin e-mail

Festivalul Racilor şi Fructelor de Mare, în PREMIERĂ în municipiul Satu Mare
portalsm.ro - Satu Mare
Festivalul Racilor şi Fructelor de Mare, în PREMIERĂ în municipiul Satu Mare

Rădulescu (AFR): Autorităţile nu au ştiut ce să facă în cazul pestei porcine; interesele politice s-au amestecat în această problemă
mesageruldecovasna.ro - Covasna
Vrei să fii notificat când apare un articol nou? Abonează-te prin e-mail

De ce a eşuat Referendumul? Pentru că PSD a avut interesul să eşueze. România lui Cristoiu
evz.ro - Bucureşti
Neatingerea pragului de 30% la Referendumul din 6-7 octombrie 2018, denumit impropriu Pentru familie, a stîrnit în spaţiul public binecunoscuta gălăgie a da...

Daea, despre pesta porcină africană: Sunt judeţe întregi unde boala nu a mai recidivat
mesageruldecovasna.ro - Covasna
Vrei să fii notificat când apare un articol nou? Abonează-te prin e-mail

Un producător de lactate dintr-o comună din Alba se îndreaptă spre vânzări de 5 milioane de euro în 2018. Produsele ajung în 11 ţări din Europa şi în marile supermarketuri din ţară
ziarulunirea.ro - Alba
Business-ul deţinut de familia Bîcu, Unilact Transilvania, producătorul de lactate din comuna Unirea, judeţul Alba, se îndreaptă anul acesta spre vânzări de 5 milioane euro cu brandul De la Ferma, în creştere cu circa 20% faţă de anul precedent, potrivit reprezentanţilor companiei. „Vindem în Auchan, Carrefour, Kaufland, în HoReCa printr-un distribuitor din Bucureşti şi în […]

Fundaţia Comunitară finanţează excursii şcolare prin programul „Mai mult decât un loc pe hartă”
mesageruldecovasna.ro - Covasna
Vrei să fii notificat când apare un articol nou? Abonează-te prin e-mail

Hoţ de lemne reclamat la Scutul Pădurii în Vurpăr
presasibiu.oradesibiu.ro - Sibiu
Este vorba de un localnic care avea patru carpeni şi nu a putut să arate actele de provenienţă pentru aceste lemne. La data de 5 octombrie, în jurul orei 08,30, pe raza comunei Vurpăr…

Aniversarea a 50 de ani de relatii diplomatice romano-australiene: Ministrul Teodor Melescanu a primit astazi delegatia Parlamentului Federal al Australiei
www.ziuaconstanta.ro - Constanţa
Ministrul afacerilor externe, Teodor Melescanu, a primit astazi, 8 octombrie 2018, delegatia Parlamentului Federal al Australiei, condusa de senatorul Ian Macdonald. Seful diplomatiei romane a apreciat ...

#ReferendumFamilie Covasna:Peste 90% dintre alegători au votat DA; 8,51% prezenţa la urne-ultimul loc la nivel naţional
mesageruldecovasna.ro - Covasna
Vrei să fii notificat când apare un articol nou? Abonează-te prin e-mail

VIDEO: Un sistem de protecţie UNIC în Europa va fi instalat în 2019 pe DN2-E85
www.jurnaldevrancea.ro - Vrancea
“Şoseaua morţii”, cum este numit DN2 E85 va fi, din 2019, un drum mai sigur. Compania Naţională de Administrare a Infrastructurii Rutiere va introduce un | Jurnal de Vrancea

#ReferendumFamilie/ Horia Grama (PSD Covasna):Nici bisericile, nici politicienii maghiari nu au explicat suficient importanţa referendumului
mesageruldecovasna.ro - Covasna
Vrei să fii notificat când apare un articol nou? Abonează-te prin e-mail

Elena Udrea, primele declaraţii. Greşeala statului care o poate scăpa de închisoare
evz.ro - Bucureşti
Elena Udrea a explicat, din spatele gratiilor, că motivările în dosarele în care este condamnată nu au fost trimise de către statul român în Costa Rica, toc...

Ultimele zile de înscrieri în programul „MOL pentru sănătatea copiilor”
mesageruldecovasna.ro - Covasna
Vrei să fii notificat când apare un articol nou? Abonează-te prin e-mail

Monitorul Social: Ponderea alocării resurselor în sistemul de învăţământ românesc e extrem de diferită de cea a altor ţări UE
mesageruldecovasna.ro - Covasna
Vrei să fii notificat când apare un articol nou? Abonează-te prin e-mail

Conferinţă pe tema situaţiei Casei de Cultură a Sindicatelor, la Sfântu Gheorghe
mesageruldecovasna.ro - Covasna
Vrei să fii notificat când apare un articol nou? Abonează-te prin e-mail

Cum să îţi aranjezi biroul: 7 trucuri pentru o atmosferă de lucru mai bună
ph-online.ro - Prahova
In timpul saptamanii, petrecem mai mult timp la birou decat acasa. De aceea, spun specialistii, este important sa decoram biroul si spatiul de lucru i...

S-a făcut ţuica! Cu sau fără alcool, oamenii îşi rup capul în accidente!
ziarulargesul.ro - Argeş
Ultimele zile au fost pline de accidente soldate cu răniţi, dar din fericire nu s-au înregistrat pierderi de vieţi omeneşti. Un singur caz grav s-a petrecut la Moşoaia, iar despre acesta v-am relatat pe larg aici: Pietonul accidentat la Moşoaia, tot în comă Se vede treaba că e gata ţuica...

Reacţia ING România, după ce mii de români au rămas fără bani: 'Cauza vine dintr-o eroare operaţională'
ph-online.ro - Prahova
Mai mulţi clienţii ai ING Bank România, a şasea bancă din sistemul bancar românesc, s-au plâns, luni, că au avut probleme cu plăţile făcute în weekend...

Excursii ghidate la cetăţile din Munţii Bodoc şi pe Muntele Puturosu, în „Săptămâna ariilor protejate”
mesageruldecovasna.ro - Covasna
Vrei să fii notificat când apare un articol nou? Abonează-te prin e-mail

Toate deciziile completelor de 5 judecători ale ÎCCJ din 2014 până în prezent ar putea fi ANULATE
ph-online.ro - Prahova
Prin sesizarea transmisă CCR de către Guvernul României, premierul a cerut Curţii să constate existenţa unui conflict juridic de natură constituţional...

GROAZĂ la Galaţi. Pământul se surpă sub un bloc LOCUIT. Oamenii sunt DISPERAȚI
evz.ro - Bucureşti
O situaţie foarte dificilă îi îngrozeşte pe locatarii unui bloc din municipiul Galaţi. Terenul de sub construcţie s-a deplasat cu 10 centimetri iar pereţii ...

BREȘA de SECURITATE de la WHATSAPP. TOȚI utilizatorii sunt în PERICOL
evz.ro - Bucureşti
Utilizatorii aplicaţiei Whatsapp sunt atenţionaţi în privinţa unei noi breşe de securitate prin care este posibil furtul contului....

Radicalismul este în creştere în Europa. Tensiuni între Ungaria şi Franţa
evz.ro - Bucureşti
Ministrul francez pentru Afaceri Europene, Nathalie Loiseau, a criticat Guvernul de la Budapesta şi a declarat că Ungaria merge pe un drum greşit iar radica...

Lucrările premiate la concursul internaţional „TransNatura”, expuse la Muzeul Cinegetic din Sfântu Gheorghe
mesageruldecovasna.ro - Covasna
Vrei să fii notificat când apare un articol nou? Abonează-te prin e-mail

Rezultatele finale ale Referendumului pentru revizuirea Constitutiei. Referendumul nu este valid
www.ziuaconstanta.ro - Constanţa
Mai putin de patru milioane de romani s-au prezentat pe 6 si 7 octombrie la urne pentru a decide daca ar trebui schimbata Constitutia in sensul redefinirii familiei, potrivit rezultatelor finale ale ...

Conducea cu permisul auto suspendat
www.zi-de-zi.ro - Mureş
Poliţişti din cadrul Secţiei de Poliţie Rurală nr. 5 Miercurea Nirajului au oprit în trafic duminică

Anunţul care zguduie lumea! "Suntem foarte ingrijorati." A început înarmarea
evz.ro - Bucureşti
Un schimb dur de replici a avut loc între secretarul de stat american Mike Pompeo şi omologul său chinez Wang Yi. În urma acestor replici, conflictul diplom...

OMENIREA este în PERICOL. PANDEMIA care ar putea ucide 147 milioane de oameni
evz.ro - Bucureşti
Condiţiile climatice, modul de viaţă şi îmbătrânirea polupaţiei la nivel mondial sunt doar câteva condiţii care ar putea să favorizeze apariţia unei pandemi...

Misterele boicotului politic al Referendumului încep să se dezlege. Cheia este la Bruxelles
evz.ro - Bucureşti
Este evident pentru mulţi că parte din eşecul Referendumului pentru Familie se datorează neimplicării partidelor politice în mobilizarea oamenilor la urne. ...

Atac ARMAT într-un BAR. Un bărbat a MURIT. POLIȚIA este în ALERTĂ.
evz.ro - Bucureşti
Un bărbat, în vârstă de 35 de ani, a fost ucis iar un altul, în vârstă de 40 de ani, a fost rănit într-un schimb de focuri atac armat...

Săptămâna Ariilor Protejate – De vorbă cu natura
www.zi-de-zi.ro - Mureş
Primăriile comunelor Răstoliţa, Stânceni şi Lunca Bradului, în parteneriat cu Regia Naţională a Pădu

Pompierii, solicitati in judetul Constanta. Unde arde
www.ziuaconstanta.ro - Constanţa
Pompierii ISU Constanta intervin luni seara in localitatea Ciobanu pentru a lichida un incendiu de vegetatie uscata. ...

O tânără cu experienţă în domeniul farmaceutic produce într-un mic laborator din Aiud săpunuri cu ulei de de struţ, lumânări la ceaşcă sau gel de acid hialuronic
ziarulunirea.ro - Alba
Săpun cu ulei de struţ, lumânări la ceaşcă sau gel de acid hialuronic produse într-un mic laborator din Aiud, de o tânără cu experienţă în domeniul farmaceutic Daniela Truţă a lansat gama de săpunuri şi cosmetice naturale Midan Naturelle bazându-se pe experienţa sa în domeniul farmaceutic Lumânări la ceaşcă cu parfum de cafea, brioşe de […]

Barbat prins de politisti dupa ce a intrat cu toporul in Universitatea „Constantin Dragan” din Lugoj
www.tion.ro - Timiş
Cascadă de infracţiuni, la Lugoj, pentru un bărbat în vârstă de 52 de ani, domiciliat în Coşteiu. El a fost reţinut de poliţie, după ce a intrat cu un topor în Universitatea „Constantin Drăgan” şi i-a ameninţat pe cei de acolo. Individul a mai fost prins de două ori conducând beat şi cu permisul suspendat şi a fost depistat că a intrat cu trei cuţite în Judecătoria Lugoj. Totul în numai câteva zile.

Misterele boicotului politic al Referendumului încep să se dezlege. Cheia este la Bruxelles. Editorial de Alecu Racoviceanu
evz.ro - Bucureşti
Este evident pentru mulţi că parte din eşecul Referendumului pentru Familie se datorează neimplicării partidelor politice în mobilizarea oamenilor la urne. ...

Planul NEȘTIUT de după Brexit care va lua prin SURPRINDERE Uniunea Europeană. „Va fi o certitudine”
evz.ro - Bucureşti
Premierul scoţian Nicola Sturgeona afirmat luni că imediat după semnarea acordului pentru realizarea Brexitului va începe procedura prin care Scoţia va deve...

Săpunuri cu ulei de struţ, lumânări la ceaşcă sau gel de acid hialuronic, produse într-un mic laborator din Aiud, de o tânără cu experienţă în domeniul farmaceutic
ziarulunirea.ro - Alba
Săpun cu ulei de struţ, lumânări la ceaşcă sau gel de acid hialuronic produse într-un mic laborator din Aiud, de o tânără cu experienţă în domeniul farmaceutic Daniela Truţă a lansat gama de săpunuri şi cosmetice naturale Midan Naturelle bazându-se pe experienţa sa în domeniul farmaceutic Lumânări la ceaşcă cu parfum de cafea, brioşe de […]

CSM nu o vrea! Adina Florea, propusă de Ministrul Justiţiei la şefia DNA, a primit aviz negativ
www.ebihoreanul.ro - Bihor
Procurora Adina Florea, propusă de Ministrul Justiţiei, Tudorel Toader, la funcţia de şef al DNA, a primit aviz negativ din partea Secţiei pentru procurori a CSM. Anterior, CSM a decis amânarea audierii acesteia, pe motiv că pe numele său există o sesizare la Inspecţia Judiciară.

MAE. Consultari si la Constanta: Concluziile consultarilor cetatenesti arata ca romanii isi doresc ca tara noastra sa isi asume mai mult apartenenta la UE
www.ziuaconstanta.ro - Constanţa
Ministrul delegat pentru Afaceri Europene, Victor Negrescu, a prezentat luni, 8 octombrie 2018, concluziile ciclului de Consultari cetatenesti pentru viitorul Uniunii Europene care a avut loc in Romania ...

Săpun cu ulei de struţ, lumânări la ceaşcă sau gel de acid hialuronic produse într-un mic laborator din Aiud, de o tânără cu experienţă în domeniul farmaceutic
ziarulunirea.ro - Alba
Săpun cu ulei de struţ, lumânări la ceaşcă sau gel de acid hialuronic produse într-un mic laborator din Aiud, de o tânără cu experienţă în domeniul farmaceutic Daniela Truţă a lansat gama de săpunuri şi cosmetice naturale Midan Naturelle bazându-se pe experienţa sa în domeniul farmaceutic Lumânări la ceaşcă cu parfum de cafea, brioşe de […]

Victor Negrescu: Un proiect de lege privind parteneriatul civil va fi depus săptămâna viitoare la Parlament
ziarulunirea.ro - Alba
Ministrul delegat pentru Afaceri Europene, Victor Negrescu, a informat luni că săptămâna viitoare va fi depus la Parlament un proiect de lege privind parteneriatul civil. „Vreau să vă spun că acest proiect este aici şi este completat, este complet, a fost discutat cu partenerii din societatea civilă, cu actorii sociali, cu formaţiunile politice şi acest […]

Mai multe colegii din Timisoara isi pierd titlul si se transforma in licee, iar un liceu devine colegiu
www.tion.ro - Timiş
Opt colegii din Timişoara devin licee, după ce Ministerul Educaţiei Naţionale a decis să revoce titlul de Colegiu Naţional sau Colegiu unităţilor de învăţământ de stat din capitala Banatului. Un liceu cunoscut primeşte însă acest titlu, tot prin ordin al ministerului.

A râs sau nu Jean-Claude Juncker de Theresa May? Comisia Europeană reacţionează
evz.ro - Bucureşti
Preşedintele Comisiei Europene, Jean-Claude Juncker, a încântat asistenţa, cu câteva mişcări de dans, la o conferinţă organizată la Bruxelles....

Asta-i mai lipsea lui Dăncilă, UN ATAC EXTERN DE LA NIVEL ÎNALT: "Vă anunţ public că nu mai accept"
evz.ro - Bucureşti
Comisarul european pentru politică regională, Corina Creţu, a afirmat, luni, că nu mai acceptă insulte din partea Guvernului României, în contextul în care ...

Împuşcături în aeroport! Poliţiştii s-au împuşcat între ei la „beţie”
evz.ro - Bucureşti
Un poliţist care lucra la aeroportul internaţional din Tadjikistan şi-a împuşcat un coleg de tură cu pistolul din dotare după o ceartă ”la beţie”....

DRAMA unui nou-născut infestat în maternitate cu un VIRUS PERICULOS. Despăgubirile sunt URIAȘE
evz.ro - Bucureşti
Un caz ieşit din comun s-a întâmplat la o meternitate din Marea Britanie unde un nou-născut a contractat virusul Herpes Simplex
...

VREMEA. AVERTIZĂRILE meteorologilor. Unde vin PLOILE în următoarele SĂPTĂMÂNI
evz.ro - Bucureşti
Potrivit Administraţiei Naţionale de Meteorologie, în următoarele două săptămâni vremea va fi în general frumoasă dar vor reveni şi ploile....

Rezultatul referendumului, analizat de parlamentarii mureşeni
www.zi-de-zi.ro - Mureş
Cotidianul Zi de Zi a invitat parlamentarii de Mureş să comenteze rezultatul referendumului pentru r

Bun, aţi înfrânt, beligeranţilor, dar cu copiii ce facem în viitor? Promiteţi că-i lăsaţi needucaţi sexual după modelul LGBT? Editorial de Simona Ionescu
evz.ro - Bucureşti
A trecut şi testul Referendumului, consultarea poporului pentru o problemă actuală cu efecte uriaşe în viitor. În viitorul acela în care şi Dragnea, şi Prea...

AVERTIZARE de la SUA: RACHETELE ruseşti ”ar putea ATINGE orice CAPITALĂ EUROPEANĂ”
evz.ro - Bucureşti
Rusia a dezvoltat submarine militare puternice iar SUA şi NATO sunt preocupate de menţinere vigilenţei în oceanul Atlantic şi Marea Mediterană, a declarat c...

Îmbrăcămintea VIITORULUI. INVENȚIA care REVOLUȚIONEAZĂ lumea MODEI
evz.ro - Bucureşti
Tehnologia din aproape toate domeniile este mereu surprinzătoare prin nenumărate invenţii. În materie de îmbrăcăminte mereu se găseşte câte ceva care să ne...

Teatrul Arcadia a fost premiat la Festivalul Internaţional de Animaţie "Sub bagheta lui Merlin" (FOTO)
www.ebihoreanul.ro - Bihor
Teatrul Arcadia a participat, săptămâna trecută, la cea de a III-a ediţie a Festivalului Internaţional de Animaţie 'Sub bagheta lui Merlin', Timişoara 2018, cu producţia artistică Cenuşăreasa. Spectacolul s-a bucurat de aprecierea publicului, dar şi a juriului care i-a oferit scenografei Oana Cernea Premiul pentru Costume.

Teatrul de Stat Constanta da startul stagiunii 2018 - 2019 cu un program divers
www.ziuaconstanta.ro - Constanţa
Dupa spectacolul desfasurat sambata la Edificiul Roman cu Mozaic, ca un preambul sugestiv pentru unul dintre obiectivele principale ale institutiei noastre - punerea in valoare a patrimoniului cultural ...

Semieşecul cu FC Avrig a tulburat şi mai mult apele la FC Unirea Alba Iulia! Armando Popescu: „Chiar e ultimatum pentru jucători şi banca tehnică! Suntem la trei puncte de retrogradare!”
ziarulunirea.ro - Alba
Semieşecul cu FC Avrig de pe “Cetate”, venit după o prestaţie cenuşie a “alb-negrilor”, pare a fi picătura ce a umplut paharul nemulţumirilor în curtea divizionarei terţe Unirea Alba Iulia, ce a strâns 6 jocuri fără victorie (în două competiţii, campionat şi Cupa României). Formaţia din Cetatea Marii Uniri este într-o evidentă criză şi au […]

Neamţ: În stare gravă la spital după ce a fost sfâşiat de 2 câini
www.stiri-neamt.ro - Neamţ
Un bărbat a ajuns în stare gravă la spital după ce a fost atacat de doi câini. Incidentul a avut loc astăzi, 8 octombrie, în comuna Bârgăoani. Se pare că

SSemieşecul cu FC Avrig a tulburat şi mai mult apele la FC Unirea Alba Iulia! Armando Popescu: „Chiar e ultimatum pentru jucători şi banca tehnică! Suntem la trei puncte de retrogradare!”
ziarulunirea.ro - Alba
Semieşecul cu FC Avrig de pe “Cetate”, venit după o prestaţie cenuşie a “alb-negrilor”, pare a fi picătura ce a umplut paharul nemulţumirilor în curtea divizionarei terţe Unirea Alba Iulia, ce a strâns 6 jocuri fără victorie (în două competiţii, campionat şi Cupa României). Formaţia din Cetatea Marii Uniri este într-o evidentă criză şi au […]

Bun, aţi înfrânt, beligeranţilor, dar cu copiii ce facem în viitor? Promiteţi că-i lăsaţi needucaţi sexual după modelul LGBT?
evz.ro - Bucureşti
A trecut şi testul Referendumului, consultarea poporului pentru o problemă actuală cu efecte uriaşe în viitor. În viitorul acela în care şi Dragnea, şi Prea...

Amplu incendiu precedat de o explozie la cea mai mare rafinarie din Canada
www.tion.ro - Timiş
În dimineaţa zilei de luni, o explozie a zguduit cartierele din jurul celei mai mari rafinării din Canada, aparţinând Irving Oil. Ulterior, s-a produs şi un incendiu.

Prinşi de poliţişti la furat de coroane mortuare
stiridegalati.ro - Galaţi
Hoţii le-au spus oamenilor legii că voiau să le vândă.

UPDATE FOTO – Motociclist american rănit pe Transfăgărăşan la Bâlea Lac
www.oradesibiu.ro - Sibiu
Un echipaj Smurd din Avrig intervine pe DN7C, la aproximativ 4 kilometri de la Bâlea Cascadă înspre Cârţişoara. Echipajul medical se deplasează la faţa locului pentru acordarea asistenţei medicale…

Cui face jocurile PNL. „Se răsucesc Brătienii în mormânt”
evz.ro - Bucureşti
Deputaţii au dezbătut, luni, o moţiune simplă depusă de PNL împotriva ministrului Economiei. Moţiunea „Dănuţ Andruşcă sau cum să destabilizezi deliberat eco...

Dragnea a făcut ANUNȚUL: S-a decis cine va fi DAT AFARĂ din Guvern!
evz.ro - Bucureşti
Preşedintele PSD, Liviu Dragnea, a anunţat că evaluarea miniştrilor din cabinetul Dăncilă a ajuns la final. ...

Cum vede Biserica Ortodoxă înfrângerea de la referendum? "Un succes nedeplin"
www.ebihoreanul.ro - Bihor
Prima reacţie a Bisericii Ortodoxe române după înfrângerea de la referendumul pentru interzicerea căsătoriilor gay a apărut luni, interpretând eşecul consultării populare pe tema familiei tradiţionale ca fiind 'un succes nedeplin'. 'Atitudinea românilor trebuie respectată şi analizată', precizează, totuşi, comunicatul BOR.

Incendiu pe strada Brizei din Constanta!
www.ziuaconstanta.ro - Constanţa
Pompierii Inspectoratul General pentru Situatii de Urgenta intervin in aceste momente pe strada Brizei din Constanta pentru a lichida un incendiu de vegetatie. ...

Ministrul Economiei, Dănuţ Andruşcă a fost IRONIZAT în Camera Deputaţilor. „Nu vă recomandă nici vocea, nici talentul”
evz.ro - Bucureşti
În plenul Camerei Deputaţilor a fost supusă dezbaterii moţiunea simplă pe Economie. În timpul dezbaterii deputatul PNL Lucian Bode l-a ironizat pe ministrul...

Olguţa Vasilescu a făcut MARELE ANUNÂ: Când se MĂRESC salariile? Anumite persoane vor fi AFECTATE. Vezi dacă eşti şi tu pe listă
evz.ro - Bucureşti
O mulţime de români vor fi afectaţi! Un proiect de hotărâre de Guvern, aflat în aşteptare pentru a fi aprobat şi publicat în Monitorul Oficial vizează toate...

Paradă militară de 1 Decembrie 2018 la Alba Iulia: De Centenarul Marii Uniri, 12 detaşamente şi peste 70 de maşini de luptă
ziarulunirea.ro - Alba
Paradă militară de 1 Decembrie 2018 la Alba Iulia La Centenarul Marii Uniri, pe 1 Decembrie 2018, deocamdată 12 detaşamente şi peste 70 de maşini de luptă, la parada militară de la Alba Iulia. La solicitarea ziarului „Unirea”, Divizia 4 Infanterie „Gemina” Cluj-Napoca ne-a comunicat, în exclusivitate, că a demarat pregătirile pentru ceremonia dedicată Zilei […]

Vino, Doamne, să vezi ce-a mai rămas din oameni! Piatra funerară a cântăreţului Vali Sterian, distrusă
www.ebihoreanul.ro - Bihor
Piatra funerară a cântăreţului şi compozitorului român de muzică folk Valeriu Sterian a fost distrusă în weekend, potrivit unei postări pe Facebook a compozitoarei Zoia Alecu, care a publicat o fotografie cu piatra funerară făcută bucăţi.

VIDEO EMOȚIONANT. UN RUS S-A REÎNTÂLNIT DUPĂ CINCI SĂPTĂMÂNI CU CÂINELE PE CARE ÎL PIERDUSE ÎNTR-UN ACCIDENT ÎN VÂLCEA
ziaruldevalcea.ro - Vâlcea
Imagini emoţionante au fost surprinse în Vâlcea, unde un câine pierdut într-un accident, pe Valea Oltului, şi-a reîntâlnit stăpânul, după cinci săptămâni. Animalul s-a rătăcit imediat după acciden…

FOTO Căţel pierdut într-un accident pe Valea Oltului găsit după cinci săptămâni de un poliţist
www.oradesibiu.ro - Sibiu
Poliţistul Daniel Stoenete, din cadrul Serviciului Rutier Vâlcea, a găsit căţelul unei familii de ruşi, animalul pierzând-se în urma unui accident rutier care a avut loc la începutul lunii septembrie…

Degringoladă la ING Bank – Ce s-a întâmplat în weekend
presasibiu.oradesibiu.ro - Sibiu
Clienţii băncii ING au aflat cu stupoare că toate plăţile pe care le-au făcut cu cardul în weekend-ul trecut au fost procesate de două ori de către bancă. Oamenii s-au trezit astăzi că au mai puţini…

Motociclist rănit pe Transfăgărăşan la Bâlea Lac
presasibiu.oradesibiu.ro - Sibiu
Un echipaj Smurd din Avrig intervine pe DN7C, la aproximativ 4 kilometri de la Bâlea Cascadă înspre Cârţişoara. Echipajul medical se deplasează la faţa locului pentru acordarea asistenţei medicale…

Constanta. Accident rutier pe bulevardul A. Lapusneanu. Tanar, lovit pe trecerea de pietoni
www.ziuaconstanta.ro - Constanţa
Un tanar a fost lovit de un autoturism pe trecerea de pietoni, in urma unui accident rutier produs luni dupa-amiaza. Potrivit IPJ Constanta, la data de 08.10.2018, ora 17 10, un barbat de 66 ani a ...

Planul NEȘTIUT de după Brexit care va lua prin SURPRINDERE Uniunea Europeană. „Va fi o certitudine”.
evz.ro - Bucureşti
Premierul scoţian Nicola Sturgeona afirmat luni că imediat după semnarea acordului pentru realizarea Brexitului va începe procedura prin care Scoţia va deve...

DESTIN tragic! Un ADOLESCENT şi-a pus CAPĂT zilelor de DORUL PĂRINȚILOR
evz.ro - Bucureşti
Un adolescent, în vârstă de 17 ani, din Botoşani, s-a sinucis de dorul părinţilor plecaţi la muncă în strâinătate. El a fost găsit de către o rudă a sa....

Veste BOMBĂ la doar O ZI după Referendum! SE DĂ LEGE! Anunţ de ULTIMĂ ORĂ de la Guvern
evz.ro - Bucureşti
La doar o zi după ce Referendumul pentru Familie a fost invalidat din lipsă de cvorum, guvernul Dăncilă a făcut anunţul privind legea parteneriatului civil....

Probleme la ING: O parte dintre tranzacţiile făcute în weekend au fost procesate de două ori!
www.ebihoreanul.ro - Bihor
Dacă vedeţi 'minusuri' în conturi, nu disperaţi! O parte dintre tranzacţiile făcute în weekend de clienţii ING Bank au fost procesate de două ori. Reprezentanţii băncii susţin că a fost vorba de o eroare operaţională, iar banii vor fi returnaţi.

Accident rutier pe DN 2A, Harsova. Fetita de 10 ani, lovita de masina
www.ziuaconstanta.ro - Constanţa
O fetita a fost lovita de masina in localitatea Harsova dupa ce a traversat strada prin loc nepermis. Potrivit IPJ Constanta, in data de 08.10.2018, ora 15 10, un barbat de 22 ani, a condus un ...

Referendumul pentru redefinirea casatoriei, invalidat. Rezultatele finale transmise de BEC
www.tion.ro - Timiş
Biroul Electoral Central (BEC) a anunţat că la nivel naţional prezenţa la vot a fost de 21,1 %. Dintre persoanele care au votat, 91,56% au fost de acord cu modificarea propusă – cea de a revizui articolul 48 din Constituţia României, în timp ce 6,47% au votat împotriva acestei propuneri. Voturi nule: 1,9%.

Artistul orădean Ovi D. Pop, câştigătorul unei secţiuni la "Fotograful Anului în România" (VIDEO)
www.ebihoreanul.ro - Bihor
O fotografie realizată de orădeanul Ovi D. Pop, cu drona, pe drumul care duce spre Derna, a câştigat locul I la secţiunea Open a concursului 'Fotograful Anului în România'. Aceeaşi fotografie a mai câştigat 32 de medalii în acest an.

„Moromeţii” continuă! Personajele lui Marin Preda aduc filmul mai întâi în Caraş-Severin!
expressdebanat.ro - Caraş-Severin
După 30 de ani de la prima ecranizare, cea de-a doua parte din „Moromeţii” apare pe marile ecrane din România în luna noiembrie. Primele proiecţii, în prezenţa echipei de filmare, vor avea loc însă în cinematografele din Caraş-Severin! Judeţul Caraş-Severin mai bifează o reuşită în domeniul cinematografic. „Moromeţii 2”, o producţie care va fi lansată…

„Sunt multe cauze pentru neîntrunirea cvorumului: politizarea evenimentului, asocierea referendumului cu Liviu Dragnea” CRITICI ÎN PREMIERĂ din partea BOR. Breaking news
evz.ro - Bucureşti
Purtătorul de cuvânt al Patriarhiei Române, Vasile Bănescu, a declarat într-un interviu că eşecul referendumului pentru modificarea Constituţiei. Dragnea...

ALERTĂ maritimă. Două nave s-au CIOCNIT în largul mării. Urmările sunt DEZASTRUOASE
evz.ro - Bucureşti
În largul Mării Tireniene s-au ciocnit două nave, un feribot tunisian şi o ambarcaţiune care transporta containere din Cipru. Coliziunea a avut loc duminică...

Autoturism lovit de tren
www.gorjeanul.ro - Gorj
Un autoturism a fost lovit, în urmă cu puţin timp, de un tren de persoane, la trecerea de cale ferată din comuna Drăguţeşti. Din fericire, nu au fost înregistrate victime.La faţa locului s-au deplasat echipaje din cadrul Detaşamentului de Pompieri Târgu-Jiu pentru degajarea autoturism

Mihai Fifor, intalnire cu ambasadorul Regatului Unit al Marii Britanii si Irlandei de Nord in Romania, la sediul MApN
www.ziuaconstanta.ro - Constanţa
Ministrul apararii nationale, Mihai Fifor, a avut luni, 8 octombrie, la sediul MApN, o intrevedere cu noul ambasador al Regatului Unit al Marii Britanii si Irlandei de Nord in Romania, Andrew Noble. ...

Un deputat PSD a făcut MARELE ANUNȚ! Când se va putea repeta referendumul
evz.ro - Bucureşti
Un deputat PSD a declarat luni la Parlament că din punctul său de vedere referendumul pentru familie s-ar putea repeta....

Reducerea birocraţiei în Primăria Caransebeş costă 3,5 milioane de lei
expressdebanat.ro - Caraş-Severin
Aleşii locali din municipiul Caransebeş au aprobat, la recenta şedinţă de lucru, un proiect cu o finanţare de peste 3,5 milioane de lei în vederea reducerii birocraţiei din Primăria Caransebeş.

ATAC DUR în PNL: Alina „Sandviş”, „Căpuşa politică” şi Predoiu DISTRUG PARTIDUL
evz.ro - Bucureşti
PNL se află în faţa unor dispute grele între foşti şi actuali lideri, după eşecul Referendumului pentru familie. Oreste Teodorescu a comentat, pe Facebook...

PATRIARHIA ACUZĂ: Eşecul REFERENDUMULUI, cauzat de „ASOCIEREA cu Liviu DRAGNEA”
evz.ro - Bucureşti
Purtătorul de cuvânt al Patriarhiei Române, Vasile Bănescu, a declarat într-un interviu că eşecul referendumului pentru modificarea Constituţiei. Dragnea...

Pestera Muierilor,locul in care femeile care nu pot avea copii pot gasi leac
www.7est.ro - Iaşi
%

Grav accident rutier in statul New York: 20 de persoane si-au pierdut viata
www.tion.ro - Timiş
Accidentul – cel mai grav de acest fel produs în ultimii nouă ani – a avut loc în cursul zilei de duminică, în momentul în care o limuzină la bordul căreia se aflau 18 persoane s-a izbit violent de o altă maşină aflată într-o parcare.

A apărut staţia de încărcare ultrarapidă: Asigură unei maşini electrice necesarul pentru 400 de kilometri autonomie în doar opt minute
ziarulunirea.ro - Alba
Unul dintre exemplele prezentate de asociaţia industriei eoliene din Europa, Wind Europe, cu scopul de a ilustra avansul mobilităţii electrice, este o staţie de încărcare ultrarapidă, care asigură unei maşini electrice necesarul pentru 400 de kilometri autonomie în doar opt minute. Să încarci maşina electrică la fel de rapid cum faci plinul la maşina cu […]

Victorii în deplasare pentru echipele din fruntea clasamentului Ligii a IV-a
www.ebihoreanul.ro - Bihor
Echipele din fruntea clasamentului s-au impus, sâmbătă şi dumincă, în deplasare, în etapa a 7-a a Ligii a IV-a. Învingătoare cu 5-2 la Diosig, CSC Sânmartin rămâne liderul cu punctaj maxim al ierarhiei. Pe locul II se află Unirea Livada, care s-a impus pe terenul echipei din Oşorhei, în timp ce CAO 1910 Oradea şi-a consolidat poziţia a III-a, după victoria cu 6-0 la Mădăras.

Daniel Suciu: Nu mă dezic de votul meu, nu te dezice de boicotul tău, dar să ne oprim
www.timponline.ro - Bistriţa-Năsăud
”A trecut... chiar a trecut ziua de ieri. Dar trebuie să treacă şi hăul. Și cuvintele grele. Și reproşurile. Nu mă dezic de votul meu, nu te dezice de boicotul tău... dar să ne oprim. Există suficiente cuvinte, savante sau nu, prin care să explici orice... de ce am mers, de ce ai stat acasă, dar ast
 www.zi-de-zi.ro - Mureş
www.zi-de-zi.ro - Mureş
Lucrările de construcţie a noii centrale termoelectrice de la Iernut, un proiect dezvoltat de cel ma

Accident între Zărneşti şi Vulcan
feedproxy.google.com - Braşov
Inspectoratul pentru Situaţii de Urgenţă (ISU) Braşov a fost solicitat să intervină la un accident rutier care a avut loc pe drumul judeţean dintre Vulcan şi Zărneşti. Un autoturism s-a ciocnit cu o autoutilitară. În urma impactului, cele două maşini au ieşit în decor, iar dubiţa s-a răsturnat. La faţa locului au ajuns un echipaj

Dragnea AVEA UN PLAN FABULOS dacă ieşea bine la Referendum. ȘI IOHANNIS ERA VIZAT! Dezvăluiri din culisele PSD. News alert în politică
evz.ro - Bucureşti
Referendumul pentru redefinirea familiei a avut loc de-a lungul a două zile - pe 6 şi pe 7 octombrie. Prezenţa finală la vot a fost de 20,41%, sub pragul de...

PANICĂ în VIAȚA unei cunoscute VEDETE de la noi. Pentru ce este AMENINȚATĂ CU MOARTEA! „NIMIC NU RĂMÂNE NEPLĂTIT”
evz.ro - Bucureşti
După ce populara vedetă Andreea Bălan a postat pe o reţea de socializare un mesaj în care a spus că este de acord cu Referendumul, au apărut numeroase comen...

Declaraţii HALUCINANTE ale deputatului ”mitralieră” după Referendum
www.stiridecluj.ro - Cluj
Deputatul PSD Cătălin Rădulescu a declarat că este dezamăgit „ca rom&ac...

Ana Birchall - "Republica Moldova poate conta pe sprijinul Romaniei pentru integrarea europeana si euro-atlantica"
www.ziuaconstanta.ro - Constanţa
Viceprim-ministrul Ana Birchall a avut, luni, 8 octombrie, la Bucuresti, o intrevedere cu viceprim-ministrul pentru reintegrare al Republicii Moldova, Cristina Lesnic, potrivit comunicatului oficial emis de ...

Decraraţii HALUCINANTE ale deputatului ”mitralieră” după Referendum
www.stiridecluj.ro - Cluj
Deputatul PSD Cătălin Rădulescu a declarat că este dezamăgit „ca rom&ac...

Decraraţii HALUCINANTE ale deputatuului ”mitralieră” după Referendum
www.stiridecluj.ro - Cluj
Deputatul PSD Cătălin Rădulescu a declarat că este dezamăgit „ca rom&ac...

Un deputat PSD cere REPETAREA referendumului pentru redefinirea familiei
www.stiridecluj.ro - Cluj
Un deputat PSD cere REPETAREA referendumului pentru redefinirea familiei

Jandarmii, chemaţi de urgenţă la Universitatea „Eftimie Murgu” din Reşiţa!
expressdebanat.ro - Caraş-Severin
În UEM Reşiţa, lucrurile ciudate parcă sunt normalitate. Dincolo de celebrele cazuri dovedite de încălcare a legii, universitatea reşiţeană a încercat să îşi reclădească imaginea, însă un episod petrecut astăzi dovedeşte că lucrurile sunt departe de a se linişti.

Un PREZENTATOR de la ANTENA a vrut să se SINUCIDĂ. SINISTRA decizie, după ce a fost ABUZAT. Cum a scăpat din ghearele MORȚII
evz.ro - Bucureşti
Răzvan Botezatu, un prezentator cunoscut de la Antena Stars, a vrut să se sinucidă. Acesta a povestit momentele negre prin care a trecut....

Lovitură CUMPLITĂ de la PROCURORI: Dragnea e în stare de ȘOC! Au anunţat ACUM
evz.ro - Bucureşti
DNA cere majorarea pedepsei de 3 ani si 6 luni de inchisoare pentru instigare la abuz in serviciu, pronuntata in prima instanta in cazul lui Liviu Dragnea....

Anunţuri de specialitate la SCM Dr. Coica
portalsm.ro - Satu Mare
Anunţuri de specialitate la SCM Dr. Coica

Vanzare teren intravilan in Ciumarna, jud. Salaj – Extras publicatie imobiliara, din data de 08. 10. 2018
ziarmm.ro - Maramureş
Noi, Societatea Civila Profesionala de Executori Judecatoresti Morari si Asociatii cu sediul in loc. Baia Mare, str. George Cosbuc, nr. 25A, ap. 10, jud. Maramures, prin executor judecatoresc Iosif-Ni

"Respectăm Centenarul": Centrul Oradiei a fost încărcat cu ghirlande tricolore de dimensiuni mari (FOTO/VIDEO)
www.ebihoreanul.ro - Bihor
Orădenii vor sărbători ziua oraşului printre ghirlande tricolore. Muncitorii Luxten atârnat deja, luni, mai multe astfel de ghirlande de dimensiuni mari şi în formă de semicerc în Piaţa Unirii. Alte ghirlande tricolore în formă dreptunghiulară vor fi expunse pe podul Sfântul Ladislau, respectiv pe străzile Aurel Lazăr şi Vasile Alecsandri.

Campionatul Judeţean de tir cu arcul şi-a desemnat laureaţii (FOTO)
www.ebihoreanul.ro - Bihor
Desfăşurate cu ocazia manifestărilor „Toamnei orădene”, ultima etapă şi finala Campionatului Judeţean de Tir cu arcul au reunit, în Parcul Cetăţii, aproape 60 de arcaşi bihoreni. Cele mai multe clasări pe podium le-au obţinut sportivii de la clubul Redpoind, care au ocupat primul loc şi în clasamentul general pe puncte.

Referendumul, la final. Peste 91 la sută dintre votanţi au spus „DA”
www.desteptarea.ro - Bacău
Rezultatele finale ale Referendumului naţional pentru revizuirea Constituţiei din 6-7 octombrie, comunicate de Biroul Electoral Central luni, la ora 17, arată că 91,56 la sută dintre participanţii la vot au spus „DA”. Revizuirea Constituţiei viza înlocuirea sintagmei „între soţi” cu sintagma „între un bărbat şi o femeie” din art. 48. Acesta ar fi sunat aşa: …

CUTREMUR la Înalta Curtea de Casaţie şi Justiţie. Gestul lui DRAGNEA te lasă FĂRĂ CUVINTE. Breaking news
evz.ro - Bucureşti
După Curtea Constituţională a fost sesizată de Guvern cu privire la un conflict juridic între Parlament şi ÎCCJ, referitor la compunerea completurilor de 5 ...

Caz ȘOCANT! A primit DOAR TREI ani de ÎNCHISOARE pentru că a ABUZAT o VACĂ
evz.ro - Bucureşti
Un bărbat din Noua Zeelandă, în vârstă de 50 de ani, a fost condamnat la închisoare după ce s-a filmat întreţinând relaţii sexuale cu o vacă şi cu un ponei....

Cum pierde Româniea bani de la UE. Călin Popescu Tăriceanu nu are NICIO REZERVĂ faţă de CRITICILE europarlamentarului Corina Creţu
evz.ro - Bucureşti
Preşedintele ALDE, Călin Popescu Tăriceanu a afirmat că este de acord cu criticile aduse de europarlamentarul Corina Creţu în legătură cu situaţia infrastr...

Imaginea cu care Vica Blochină şi-a ÎNNEBUNIT toţi fanii! Doamne, ce forme... Se vede TOT - FOTO INCENDIAR
evz.ro - Bucureşti
Vica Blochină şi-a înnebunit toţi fanii cu o fotografie pe care şi-a făcut-o zilele trecute: vedeta a vrut, încă o dată, să arate tuturor că vârsta este doa...

Referendum 2018 – Rezultatele finale. Vezi câţi oameni au votat DA
www.stiri-neamt.ro - Neamţ
Biroul Electoral Central a anunţat în urmă cu puţin timp rezultate finale ale referendumului pentru familie, după centralizarea tuturor secţiilor de

Rezultate partiale Referendum, ora 17.00. Peste 70.000 de voturi nule
www.ziuaconstanta.ro - Constanţa
Biroul Electoral Central a afisat la ora 17.00 rezultatele partiale ale referendumului pentru familie. Astfel, din 18.279.011 de personae inscrise in lista pentru referendumul, 3.531.732 au spus DA si ...

Euro forteaza de doua saptamani pragul de 4,67 lei
ziarmm.ro - Maramureş
Cursul euro a facut un mic pas inapoi, insa dolarul si francul elvetian au crescut, in timp ce indicii ROBOR au revenit la normal. Cursul euro a scazut de la 4,6685 lei, maximul ultimelor trei luni, l

Poponarii au pus stapanire pe PSD? De ce nu a fost mobilizat electoratul?!
ziaruldevalcea.ro - Vâlcea
De ce nu s-a implicat PSD, sa-si mobilizeze electoratul, sa voteze la acest referendum? Chiar asa, poponarii au pus stapanire si pe acest partid? Nu exista nicio explicatie pertinenta a lipsei de i…

Surpriză plăcută: Orădencele s-au impus pe terenul celor de la Minaur II Baia Mare, la 2 goluri diferenţă
www.ebihoreanul.ro - Bihor
Handbalistele de la CSU Oradea au furnizat surpriza etapei a 4-a din Seria D a campionatului Diviziei A, după ce duminică s-au impus la o diferenţă de două goluri, cu scorul de 26-24, pe terenul celor de la Minaur II Baia Mare. Elevele antrenoarei Doina Ardelean, care conduceau şi la pauză, cu 13-12, au obţinut, astfel, prima victorie din noua ediţie de campionat.

Accident rutier in Agigea. O persoana, ranita
www.ziuaconstanta.ro - Constanţa
Un accident rutier a avut loc cu putin timp in urma in localitatea Agigea. Potrivit SAJ Constanta, o persoana a fost ranita. Stire in curs de actualizare. ...

EXTRATEREȘTRII există? OAMENII de ȘTIINȚĂ spun că ei EXISTĂ dar nu îi VEDEM
evz.ro - Bucureşti
Omenirea a privit spre stele din timpuri străvechi, aşteptând un semn, dar oamenii de ştiinţă nu au găsit până în prezent dovezi de existenţă extraterestrii...

ALERTĂ BANCARĂ în România! Cine sunt CEI MAI AFECTAȚI CLIENȚI? Dispar banii de pe carduri! Breaking news
evz.ro - Bucureşti
Începând de vineri, 05 octombrie 2018 şi până în prezent banca ING se confruntă cu o gravă eroare la sistemul de plăţi. Departamentul avizat a răspuns numer...

Ploiestiul, invadat de PLOSNITE de grau. "Ne intra in pãr, pe stradã!"
ph-online.ro - Prahova
Plosnitele de grau au invadat Ploiestiul si pare ca administratia locala asteapta venirea iernii pentru ca insectele urat mirositoare sa dispara de la...

APIA anunta efectuarea platii ajutorului de stat pentru reducerea accizei la motorina utilizata in agricultura
www.ziuaconstanta.ro - Constanţa
Agentia de Plati si Interventie pentru Agricultura APIA informeaza ca incepand cu data de 09.10.2018, va efectua plata ajutorului de stat pentru reducerea accizei la motorina utilizata in ...

Condamnat pentru ilegalităţi rutiere, prins la Râmnicu Vâlcea
ziaruldevalcea.ro - Vâlcea
Poliţişti ai Serviciului de Investigaţii Criminale au pus în aplicare un mandat de executare a pedepsei cu închisoarea, emis de Judecătoria Râmnicu Vâlcea, faţă de un bărbat din municipiu. La data …

FOTO – Ritmul zilnic al lucrărilor de la stadionul Municipal – Încet şi foarte încet sau mai deloc
www.oradesibiu.ro - Sibiu
Lucrările la stadionul Municipal ar fi trebuit să avanseze într-un ritm alert, dacă e să judecăm după promisiunile constructorului. În 22 septembrie FC Hermannstadt ar fi trebuit să joace acasă cu CFR…

Prima reacţie a Patriarhiei după eşecul referendumului pentru familie
www.oradesibiu.ro - Sibiu
Eşecul Referendumului pentru familie a făcut ca Patriarhia Română să aibă o reacţie în sensul îndemnării în continuare la unitatea familiei şi la cea spirituală. Reprezentanţii instituţiei le-a…

Politicienii după eşuarea referendumului: Bolojan vede o mulţime de cauze, Mang dă vina pe UDMR şi pe Coaliţie, iar Cseke spune că e normal că maghiarii nu au ieşit la vot
www.ebihoreanul.ro - Bihor
Politicienii din Bihor care au susţinut participarea la referendum reacţionează diferit după eşuarea lui. Şeful PSD Bihor spune că primarii pesedişti şi-au atins „targetul”, obţinând prezenţe de 65-70%, însă nu acelaşi lucru îl poate afirma despre UDMR, iar despre români afirmă că au dovedit că nu preţuiesc „ceea ce este dat de la Dumnezeu”. Liderul PNL Bihor, Ilie Bolojan, recunoaşte, în schimb, şi vina politicienilor, dar şi rolul campaniei favorabile boicotului.

Cât de bogat este Liviu Dragnea? Sumele COLOSALE care îi intră în buzunar liderului PSD
evz.ro - Bucureşti
Liderul PSD Liviu Dragnea este unul dintre cei mai controversaţi politicieni de la ora actuală. Cu siguranţă multe persoane s-au întrebat ce avere are preşe...

Exatlon. IUBITA unui concurent A APĂRUT GOALĂ. Imaginile +18 au arătat totul. Galerie foto
evz.ro - Bucureşti
Bombă la Exatlon. Iubita faimosului concurent Yamato Zaharia a apărut goală pe internet. Blonda Nu a avut nicio inhibiţie să se dezbrace în faţa camerei....

O nouă schimbare la vârful Poliţiei Alba: Cine este comisarul desemnat să îndeplinească atribuţiile de şef al inspectoratului
ziarulunirea.ro - Alba
Comisarul şef de poliţie Mihai Rus a fost desemnat, luni, de Inspectoratul General al Poliţiei Române, să îndeplinească atribuţiile şefului de inspectorat, după ce au expirat cele şase luni în care a fost împuternicit Cioancă Ioan, care se întoarce la conducerea serviciului de ordine publică. Comisarul şef Mihai Rus, care până acum a fost adjunct […]

Scandal din cauza Referendumului pentru familie. Ce i-a făcut o femeie soţului său, pentru că nu a mers la vot
www.stiridecluj.ro - Cluj
Un scandal uriaş a avut loc într-o familie din Timiş, încheiat cu in...

Estimările Comisiei Europene privind preţul cărnii de porc, de Crăciun, în contextul pestei porcine
ziarulunirea.ro - Alba
Producţia mare de carne de porc ţine anul acesta preţul la un nivel scăzut, chiar dacă tot mai multe state europene, dar mai ales România, se confruntă cu numeroase focare de pestă porcină africană (PPA), potrivit unui raport al Comisiei Europene. În 2019, presunea pe preţ ar putea fi şi mai mare din cauza prăbuşirii […]

Un boier pe bani publici din nordul judetului Valcea, in vizorul DNA
ziaruldevalcea.ro - Vâlcea
Pe surse am aflat ca procurorii anticoruptie ar fi cerut mai multe documente de la o primarie din nordul judetului. Oamenii legii ancheteaza modul de incredintare a mai multor lucrari de constructi…

OMENIREA este în PERICOL. PANDEMIA care ar putea ucide 147 de milioane de vieţi omeneşti
evz.ro - Bucureşti
Condiţiile climatice, modul de viaţă şi îmbătrânirea polupaţiei la nivel mondial sunt doar câteva condiţii care ar putea să favorizeze apariţia unei pandemi...

Liviu Pleşoianu a fost BLOCAT pentru 30 de zile pe Facebook! Cine s-a SUPĂRAT atât de tare pe deputatul PSD?
evz.ro - Bucureşti
Liviu Plesoianu anunţă prin intermediul prietenilor de pe social media că i-a fost blocat contul personal de Facebook pentru o perioadă de 30 de zile, notea...

Doctorandul Radu Fortiş este noul arhitect şef al Oradiei
www.ebihoreanul.ro - Bihor
Fostul preşedinte al Ordinului Arhitecţilor Bihor, Radu Fortiş, este, de săptămâna trecută, noul arhitect şef al Oradiei. Absolvent al Institutului de Arhitectură Ion Mincu Bucureşti, fost profesor la Facultatea de Arhitectură Oradea şi doctorand al Universităţii Tehnice Cluj, Fortiş îşi propune debirocratizarea muncii funcţionarilor din cadrul Instituţiei Arhitectului Şef şi implementarea unor mijloace moderne de acces la documentele instituţiei cum ar fi eliberarea online a Certificatelor de Urbanism.

Homosexuali sărutându-se în centrul Bucureştiului. Asociaţiile LGBT cer legalizarea „de urgenţă” a familiilor formate din persoane de acelaşi sex
ph-online.ro - Prahova
ActiveNews.ro: Referendumul pentru căsătorie nu va fi validat de Curtea Constituţională, care va constata că nu a fost îndeplinit criteriul cvoru...

Ultimul acord al “Zilelor Muzicii Contemporane”, ediţia 2018
www.desteptarea.ro - Bacău
În ultima zi a Festivalului “Zilele Muzicii Contemporane”, duminică 7 octombrie, a avut loc, de la ora 11.00, la Centrul de Cultură “George Apostu”, concertul Ansamblului Universităţii de Muzică din Chişinău. Cu o interpretare admirabilă, foarte bine primită de public, care i-a gratulat pe cei patru solişti cu aplauze prelungite, ansamblul din Chişinău a încheiat …

Un adolescent de 15 ani a furat un telefon dintr-o benzinărie
www.desteptarea.ro - Bacău
La data de 07 octombrie a.c., poliţiştii din Comăneşti au identificat un tânăr de 15 ani, bănuit de comiterea infracţiunii de furt. În fapt, tânărul în cauză, în timp ce se afla într-o staţie de alimentare cu carburant de pe raza oraşului Comăneşti, ar fi profitat de neatenţia unei femei de 58 de ani căreia …

Naţional: Eroare de sistem la o bancă. Mai mulţi români s-au trezit fără bani în conturi
www.stiri-neamt.ro - Neamţ
ACTUALIZARE: ”O parte dintre tranzacţiile făcute în weekend au fost procesate de două ori din cauza unei erori operaţionale. În 24 de ore banii vor fi

Tânăr de 28 de ani, la volan cu o alcoolemie de 0,96 in aer
www.desteptarea.ro - Bacău
La data de 06 octombrie a.c., un echipaj de poliţie rutieră din Buhuşi a depistat în trafic un tânăr de 28 de ani, din comuna Blăgeşti, în timp ce conducea un autoturism pe strada Stadionului, sub influenţa alcoolului. Conducătorul auto a fost testat cu aparatul alcooltest, rezultatul fiind de 0,96 mg/l alcool pur în aerul …

Naţional: Eroare de sistem la o bancă. Mai mulţi români s-au trezit fără bani în conturi
www.stiri-neamt.ro - Neamţ
Mai mulţi români s-au trezit fără bani în conturi şi cu tranzacţiile dublate după o eroare de sistem la ING Bank. - notează observator.tv Oamenii au

Prins cu o cultură de CANNABIS, în judeţ! Arădeanul se află acum în AREST PREVENTIV
newsar.ro - Arad
Un arădean a fost arestat pentru trafic ilicit de droguri de risc. Poliţiştii Serviciului de Combatere a Criminalităţii Organizate, sub coordonarea procurorului D.I.I.C.O.T., împreună cu poliţiştii oraşului Sebiş, cu sprijinul luptătorilor din cadrul Serviciului pentru Acţiuni Speciale, au desfăşurat, la sfârşitul săptămânii trecute, trei percheziţii domiciliare, la domiciliul unui bărbat bănuit de trafic ilicit de

Tranzactii cu probleme la o banca cunoscuta din Romania. Clientii s-au trezit cu conturile pe minus
www.ziuaconstanta.ro - Constanţa
Mai multi clienti ai ING Bank se confrunta cu probleme cu conturile, reclamand ca banca le-a dublat tranzactiile efectuate in ultimele trei zile si ca s-au trezit fara bani in cont sau chiar pe ...

3 ani şi 10 luni pentru că a condus fără permis şi a părăsit locul accidentului
www.desteptarea.ro - Bacău
La data de 06 octombrie a.c., poliţişti din cadrul Secţiei 1 Poliţie Bacău, în urma cercetărilor specifice efectuate au identificat un tânăr de 26 de ani, din localitate, care poseda mandat de executare a pedepsei închisorii. Acesta a fost condamnat la o pedeapsă de 3 ani şi 10 luni închisoare pentru săvârşirea infracţiunilor de conducerea …

Au debutat, au căştigat, dar au şi cedat
ph-online.ro - Prahova
În acest weekend, echipa de baschet U14 de la CSM Ploieşti, a debutat în campionat. Fetele antrenate de Corina Savu au fost repartizate în Grupa A3 şi...

Autor de furt din auto prins în flagrant de poliţişti
www.desteptarea.ro - Bacău
La data de 07 octombrie a.c., poliţişti din cadrul Secţiei 2 Poliţie Bacău au depistat în flagrant un bărbat de 32 de ani, din localitate, care ar fi sustras bunuri dintr-o autoutilitară parcată în faţa unui imobil. Din cercetările poliţiştilor a rezultat că bănuitul ar fi deschis portiera culisantă a autoutilitarei ce fusese lăsată neasigurată …

Urmeaza pasii din harta si descopera cum poti incepe o noua calatorie in Tinutul Veoneer
www.tion.ro - Timiş
ADVERTORIAL. Toamna aceasta, Veoneer dă startul programului de reconversie profesională - Veoneer Academy. Celor care îşi doresc să se înscrie în acest proiect le vor fi testate cunoştinţele tehnice, logice şi matematice iar cei care reuşesc să treacă de toate provocările vor fi admişi.

Un bărbat s-a luat la harţă cu trei tineri. Apoi s-a dus acasa şi s-a întors cu un pistol
www.desteptarea.ro - Bacău
Tânăr reţinut de poliţişti pentru lovire sau alte violenţe, tulburarea ordinii şi liniştii publice, ameninţare şi port sau folosire fără drept de obiecte periculoase Poliţiştii au identificat şi reţinut un tânăr care, la data de 07 octombrie a.c. ar fi agresat şi ameninţat trei persoane într-o societate comercială din comuna Gârleni. La data de 07 …

FOTOGALERIE. Cu ochii spre acoperişul lumii. O sătmăreancă, la tabăra de bază de pe Everest!
portalsm.ro - Satu Mare
Cu ochii spre acoperişul lumii. O sătmăreancă, la tabăra de bază de pe Everest!

Iuliu Mureşan a refuzat funcţia propusă de patronul CFR Cluj
www.stiridecluj.ro - Cluj
Iuliu Mureşan a refuzat funcţia propusă de patronul CFR Cluj

Adolf Hitler a fost GAY şi a iubit băieţii adolescenţi, susţin dosarele CIA. Foto DOCUMENT în articol
evz.ro - Bucureşti
Adolf Hitler a fost homosexual şi a avut o afinitate pentru băieţii adolescenţi, potrivit unor documente CIA extrem de secrete despre liderul nazist. Fişie...

Vizită ISTORICĂ la Moscova. Interes MAJOR al liderului nord coreean Kim Jong Un pentru Rusia
evz.ro - Bucureşti
Preşedintele Coreei de Nord, Kim Jong Un, a anunţat că doreşte să efectueze o vizită oficială la Moscova. În urmă cu trei ani liderul coreean a renunţat la ...

Apar ACUZELE în PARTID. SENATOR PSD, despre întrebarea de la REFERENDUM: „NU a fost destul de CLARĂ”
evz.ro - Bucureşti
Senatorul PSD, Niculae Bădălau, a declarat că lipsa de claritate a întrebării de pe buletinele de vot este cauza pentru numărul scăzut de votanţi....

Se anunţă grevă generală la AITT. Miercuri, 10 octombrie, la ora 6.00 se vor semna tabelele de grevă
www.gazetadambovitei.ro - Dâmboviţa
Norii de grevă generală plutesc în aer… la AITT! Termenul limită până la care se mai poate face ceva, pentru

Incendiu la un fânar. Trei echipaje de pompieri la faţa locului
www.oradesibiu.ro - Sibiu
Un incendiu puternic s-a declanşat la un fânar care se află în câmp deschis, al ieşirea din Cârţişoara spre Arpaşu de Sus. Pentru a localiza şi stinge focul la faţa locului s-au deplasat trei echipaje…

FOTO – Accident în nordul judeţului. Cel putin trei răniţi
www.oradesibiu.ro - Sibiu
Neatenţia în conducere a dus la producerea a încă un accident de circulaţie. În Localitatea Târnava două maşini s-au ciocnit din cauza neacordării de prioritate a uneia dintre ele. O şoferiţă de 41 de…

METEO: Cum va fi VREMEA până pe 21 octombrie. Prognoza meteo pe două săptămâni
www.stiri-neamt.ro - Neamţ
Vremea va fi în general apropiată de normalul pentru această perioadă în următoarele două săptămâni, iar probabilitatea de ploaie va redusă, conform

Va era dor de „Yahoo! Messenger”? S-a lansat o noua versiune
ph-online.ro - Prahova
Încă de când a intrat în portofoliul Verizon sub brandul Oath, Yahoo a trecut prin mai multe schimbări. Nu numai că Yahoo Messenger, popularul servici...

Alti bani, alta distractie! Angajatii Primariei Ploiesti vor fi "instruiti impotriva coruptiei", cu 62.000 de euro, bani publici
ph-online.ro - Prahova
Veţi fi probabil bucuroşi să aflaţi că Primăria Ploieşti intră într-un proiect european, participarea fiind aprobată săptămâna trecută de forul legisl...

IGPR a anunţat cine conduce IPJ Gorj, de astăzi
www.gorjeanul.ro - Gorj
Reprezentanţii Inspectoratului General al Poliţiei Române au stabilit cine va conduce Poliţia Gorj, începând de astăzi, după ce a expirat împuternicirea comisarului-şef Decebal Drăghiea. Unul dintre adjuncţi, Daniel Feţanu, a preluat, temporar, atribuţiile inspectorului şef, până la

ACUM – Accident grav la Budeasa
ziarulargesul.ro - Argeş
[mom_row][/mom_row]În urmă cu câteva momente, s-a produs un accident rutier în com. Budeasa, pe drumul către Mărăcineni. Din primele date ale ISU, au fost implicate 2 turisme şi au fost identificate 4 victime. Intervin în acest moment o autospeciala, 2 ambulanţe SMURD şi două ambulanţe ale...

Lovitura SUPREMĂ pentru cei care au maşini DIESEL şi pe BENZINĂ! Detalii INCREDIBILE au ieşit la iveală: S-a aflat TOTUL!
evz.ro - Bucureşti
La nivelul Blocului Comunitar, scumpirea carburanţilor este de 9%, în timp ce în ţara noastră creşterea preţurilor a fost de două ori mai rapidă....

Schimbari in zona Piata Grivitei din Constanta! Ce strada devine pietonala
www.ziuaconstanta.ro - Constanţa
Primaria Municipiului Constanta anunta ca, de miercuri dimineata, traficul rutier va fi resistematizat. Astfel, strada Stefan Mihaileanu, tronsonul cuprins intre strazile Grivitei si Stefan cel ...

Accident cu trei maşini în Mănăştur FOTO
www.stiridecluj.ro - Cluj
Un accident rutier a avut loc, luni după-amiază, în zona Pritax, din Mănăşt...

Motivul NEBĂNUIT pentru care nu poţi scăpa de KILOGRAMELE în plus şi o METODĂ SIMPLĂ care te-ar putea AJUTA
newsar.ro - Arad
Citeşte azi ce scriu ziarele de mâine!

Gabriela Urse: Ne bucurăm că dl. Scripcaru promovează propunerile consilierilor locali PSD
feedproxy.google.com - Braşov
Primarul Braşovului, George Scripcaru, a anunţat vineri, într-o conferinţă de presă, referitoare la transportul public de călători din municipiul Braşov, că există mai multe proiecte pentru dezvoltarea şi eficientizarea acestuia. „Printre ideile expuse de domnia sa a figurat şi ideea punerii la dispoziţia elevilor a unor autobuze şcolare. Mă bucur foarte mult că dl. primar

Maramures: Vezi prognoza meteo pentru perioada 8-21 octombrie
ziarmm.ro - Maramureş
Vremea va fi in general apropiata de normalul pentru aceasta perioada in urmatoarele doua saptamani, iar probabilitatea de ploaie va redusa, conform prognozei pentru intervalul 8-21 octombrie, publica

Predelean dat dispărut după ce a plecat din spital
feedproxy.google.com - Braşov
Politistii din Brasov cauta un barbat de 66 ani, din Predeal, care astazi, in jurul orei 8.10 a plecat voluntar dintr o unitate medicala din Brasov, unde fusese internat din data de 4 octombrie a.c., pentru tratament neurologic. Barbatul are urmatoarele semnalmente: inaltime aproximativ 1.8 m, constitutie astenica, fata ovala, par saten, ochi caprui, mustata.

Dragnea a dat în judecată Înalta Curte de Casaţie şi Justiţie
ph-online.ro - Prahova
După ce Guvernul a sesizat Curtea Constituţională pentru un conflict juridic între Parlament şi ÎCCJ, cu privire la compunerea completurilor de 5 jude...

Castigatorii Festivalului Castanilor-In memoriam Gabi Dobre, organizat la Ploiesti. Niciun prahovean pe lista
ph-online.ro - Prahova
Primăria Municipiului Ploieşti şi Casa de Cultură Ion Luca Caragiale, în parteneriat cu Teatrul Toma Caragiu, au organizat, în perioada 5-6 octo...

"Bărbatul care aduce fericirea". Un elveţian de origine română îşi prezintă romanul "fulminant" la Oradea
www.ebihoreanul.ro - Bihor
Orădenii sunt invitaţi marţi, 16 octombrie, de la ora 18.30, la o întâlnire cu scriitorul Cătălin Dorian Florescu, laureatul Premiul Andreas Gryphius 2018, care va vorbi despre romanul său 'Bărbatul care aduce fericirea', prezentat de publicaţia Stern drept 'un roman fulminant despre un secol de rătăciri, izfoniri, evadări, de căutare a norocului'.

ENEL anunta intreruperea furnizarii energiei electrice in judetul Constanta
www.ziuaconstanta.ro - Constanţa
Programul intreruperilor programate in judetul Constanta, in s pt mana 40 01 05octombrie2018. Pentru lucrarile anuale de reparatii si intretinere instalatii si retele electrice, precum si posturi de ...

Piatra-Neamţ: Tarifele pentru fotbal, tenis şi alte activităţi la Sala Polivalentă
www.stiri-neamt.ro - Neamţ
Sala Polivalentă din Piatra-Neamţ, a cărei construcţie a fost finalizată în anul 2010, este o facilitate sportivă publică care aparţine pietrenilor şi se Sala Polivalentă din Piatra-Neamţ, a cărei construcţie a fost finalizată în anul 2010, este o facilitate sportivă publică care aparţine pietrenilor

DÂMBOVIȚA: Un control APIA arată că fermierii au de furcă mai mult cu mapa, decât cu sapa
www.gazetadambovitei.ro - Dâmboviţa
APIA Dâmboviţa a finalizat controlul pe teren, la fermele eşantionate, reuşind astfel să respecte termenul impus de Ministerul Agriculturii, de

Criminalul la puşcărie, victima în pământ, dar amândoi prieteni pe Facebook…
ziarulargesul.ro - Argeş
...Acesta este absurdul situaţiei după omorul de la Călineşti, un dosar de anvergură prin prisma faptului că a făcut înconjurul ţării fiind preluat de o mulţime de publicaţii locale şi naţionale. Alin Turlea, adică suspectul crimei, a fost arestat preventiv la sfârşitul săptămânii, iar victima...

Demarare implementare proiect „Extinderea activitatii Policlinicii Sfantul Ioan S.R.L”
ziarmm.ro - Maramureş

Andreea Bălan a făcut publice ameninţările cu moartea primite pentru că susţine comunitatea LGBT
www.stiridecluj.ro - Cluj
Andreea Bălan s-a declarat o susţinătoare a comunităţii LGBT, iar în perioa...

Oraşul Cugir, fără niciun colegiul naţional, după ce ”David Prodan” a primit denumirea de ”liceu teoretic”
ziarulunirea.ro - Alba
Primăria oraşului Cugir a primit o adresă prin care a fost informată cu privire la revocarea titlului de ”Colegiu Naţional” acordat Colegiului Naţional ”David Prodan” Cugir. ”Ordinul nr. 5091/2018 a fost comunicat unităţii de învăţământ, care va întreprinde demersurile necesare pentru cuprinderea acesteia în reţeaua şcolară noua denumire, Liceul Teoretic ”David Prodan” Cugir, începând cu […]

Daea, despre pesta porcina africana: Sunt judete intregi unde boala nu a mai recidivat
ziarmm.ro - Maramureş
Ministrul Agriculturii, Petre Daea, a afirmat luni ca sunt judete intregi unde pesta porcina africana nu a mai recidivat, iar in Bihor si Satu Mare s-a trecut la etapa a doua, respectiv instalarea pur

Referendum pentru redefinirea casatoriei. Rezultate finale in Timis: peste 90% dintre alegatori au votat DA
www.tion.ro - Timiş
În Timiş, după numărarea voturilor de la cele 597 de secţii, Biroul Electoral Judeţean a emis rezultatele finale ale consultării publice în ceea ce priveşte redefinirea căsătoriei. Deşi referendumul a fost invalidat din cauza prezenţei care nu a atins pragul de 30 la sută, în Timiş peste 90 la sută dintre cei care au ieşit la vot au pus ştampila pe „DA”.

Preşedintele Grupului S&D din PE, după referendum: Guvernul să înainteze lucrul pentru legislaţia parteneriatului civil
ziarulunirea.ro - Alba
Preşedintele Grupului Alianţei Progresiste a Socialiştilor şi Democraţilor din Parlamentul European, Udo Bullmann, a comunicat că a primit cu bucurie vestea că referendumul pentru schimbarea definiţiei căsătoriei in Constituţia României nu a obţinut sprijinul necesar pentru a fi validat, afirmând că acest rezultat arată că majoritatea românilor nu au niciun interes în a-şi vedea ţara […]

VEȘTI BOMBĂ în showbiz-ul românesc S-a FORMAT un NOU CUPLU? Pe cine a sărutat Tudor Chirilă
evz.ro - Bucureşti
Tudor Chirilă şi Loredana Groza sunt foarte buni prieteni, iar asta se poate observa şi din comportamentul lor. Cei doi artişti s-au filmat în timp ce se pu...

AVERTISMENT ONU: Pământul e în pericol. Sunt necesare schimbări fără precedent. Omenirea mai are 12 ani
evz.ro - Bucureşti
Sunt necesare schimbări fără precedent în modul de funcţionare a societăţii pentru limitarea încălzirii globale la 1,5 grade Celsius, sub limita convenită, ...

CLUJ: Percheziţii de amploare la traficanţi de droguri. Șase persoane au fost arestate FOTO
www.stiridecluj.ro - Cluj
Poliţiştii clujeni au efectuat, alături de procurorii D.I.I.C.O.T., 14 percheziţii, &a...

Trofeul Timishort 2018 a fost castigat de scurtmetrajul Kapitalists!
www.tion.ro - Timiş
Scurtmetrajul câştigător al ediţiei cu numărul 10 al celui mai important festival de scurtmetraje din vestul ţării, Timishort, este „Kapitalists” în regia lui Pablo Muñoz Gomez.

Inspectorii ITM Alba au dat 19 avertismente şi amenzi în valoare de 17.000 de lei, în urma controalelor efectuate în perioada 1 – 5 octombrie 2018
ziarulunirea.ro - Alba
Inspectorii ITM Alba au dat 19 avertismente şi amenzi în valoare de 17.000 de lei, în urma controalelor efectuate în perioada 1 – 5 octombrie 2018 Prin Programul cadru de acţiuni al I.T.M. Alba pentru anul 2018, aprobat de către conducerea Inspecţiei Muncii, s-a stabilit că unul dintre obiectivele prioritare ale activităţii inspectoratului îl reprezintă […]

Barbat, arestat preventiv pentru trafic ilicit de droguri de risc dupa ce ar fi cultivat cannabis (document)
www.ziuaconstanta.ro - Constanţa
La data de 06.10.2018 procurorii Directiei de Investigare a Infractiunilor de Criminalitate Organizata si Terorism Biroul Teritorial Arad au dispus retinerea pentru o perioada de 24 de ore a ...

FOTO Căţel pierdut într-un accident pe Valea Oltului găsit după cinci săptămâni de un poliţist
presasibiu.oradesibiu.ro - Sibiu
Poliţistul Daniel Stoenete, din cadrul Serviciului Rutier Vâlcea, a găsit căţelul unei familii de ruşi, animalul pierzând-se în urma unui accident rutier care a avut loc la începutul lunii septembrie…

FOTO – Ritmul zilnic al lucrărilor de la stadionul Municipal – Încet şi foarte încet sau mai deloc
presasibiu.oradesibiu.ro - Sibiu
Lucrările la stadionul Municipal ar fi trebuit să avanseze într-un ritm alert, dacă e să judecăm după promisiunile constructorului. În 22 septembrie FC Hermannstadt ar fi trebuit să joace acasă cu CFR…

Prima reacţie a Patriarhiei după eşecul referendumului pentru familie
presasibiu.oradesibiu.ro - Sibiu
Eşecul Referendumului pentru familie a făcut ca Patriarhia Română să aibă o reacţie în sensul îndemnării în continuare la unitatea familiei şi la cea spirituală. Reprezentanţii instituţiei le-a…

Incendiu la un fânar. Trei echipaje de pompieri la faţa locului
presasibiu.oradesibiu.ro - Sibiu
Un incendiu puternic s-a declanşat la un fânar care se află în câmp deschis, al ieşirea din Cârţişoara spre Arpaşu de Sus. Pentru a localiza şi stinge focul la faţa locului s-au deplasat trei echipaje…

FOTO – Accident în nordul judeţului. Cel putin trei răniţi
presasibiu.oradesibiu.ro - Sibiu
Neatenţia în conducere a dus la producerea a încă un accident de circulaţie. În Localitatea Târnava două maşini s-au ciocnit din cauza neacordării de prioritate a uneia dintre ele. O şoferiţă de 41 de…

APEL DE SELECȚIE NR. 2/2018 aferent măsurii M1/6B – Dezvoltarea şi modernizarea localităţilor rurale
expressdebanat.ro - Caraş-Severin
APEL DE SELECȚIE NR. 2/2018 Grupul de Acţiune Locală Caraş-Timiş anunţă lansarea sesiunii de cerere de proiecte aferente Măsurii 1/6B - „Dezvoltarea şi modernizarea localităţilor rurale” Data lansării apelului de selecţie: 09.10.2018 Măsura lansată prin apelul de selecţie: Măsura 1/6B - „Dezvoltarea si modernizarea localităţilor rurale” Beneficiari eligibili: • Comunele şi asociaţiile acestora, conform legislaţiei naţionale…

Tăriceanu, prima REACȚIE după REFERENDUM. Tema NU a PREOCUPAT suficient SOCIETATEA. Altfel, opţiunea e CLARĂ
evz.ro - Bucureşti
Preşedintele Senatului României, Călin Popescu Tăriceanu, a declarat că eşecul Referendumului pentru Familie nu este nici o victorie, nici o înfrângere......

Rezultatele finale ale referendumului în Bihor: Aproape 95% dintre cetăţenii participanţi au votat DA
www.ebihoreanul.ro - Bihor
Prefectura Bihor a făcut publice, luni, rezultatele finale ale referendumului pentru redefinirea căsătoriei ca uniunea dintre un bărbat şi o femeie. Conform datelor oficiale ale Biroului Electoral Judeţean, din totalul cetăţenilor care au votat, doar 28,92% din cei cu drept de vot, majoritatea covârşitoare, şi anume 94,47%, s-au pronunţat în sensul dorit de Coaliţia pentru Familie.

ATAC NEAȘTEPTAT de la Bruxelles. Corina Creţu ȘTERGE PE JOS cu lideri din PROPRIUL PARTID. „Nu mai ACCEPT INSULTE din partea GUVERNULUI”
evz.ro - Bucureşti
Comisarul european Corina Creţu a răbufnit din nou la adresa Guvernului României şi a reiterat că autostrada Iaşi-Târgu Mureş este o prioritate pentru Comis...

Mişcare de ultimă oră a lui Dragnea! Nu mai este preşedintele Camerei Deputaţilor
evz.ro - Bucureşti
Liderul PSD a fost astăzi aşteptat la instanţa supremă, unde ar fi trebuit să aibă loc primul termen al apelului în dosarul angajărilor fictive, însă Liviu ...

Comunicat de presa: Conferinta de prezentare a proiectului Medierea – politica publica eficienta in dialogul civic
www.ziuaconstanta.ro - Constanţa
...

MORENI: Câştig de 63.000 de lei la Loto 5/40
www.gazetadambovitei.ro - Dâmboviţa
Loteria Română a anunţat, astăzi, un câştig de 63.253 de lei,la categoria a II-a,la tragerea Loto 5/40 din 7 duminică, înregistrat

Anunt pierderi
www.infobraila.ro - Brăila
Comentarii comentariu

Viteze excesive pe autostrazi! Printre vitezomani s-au aflat si soferi bauti
www.ziuaconstanta.ro - Constanţa
Politistii Brigazii Autostrazi si Misiuni Speciale a Politiei Romane au depistat, in prima saptamana a lunii octombrie, 70 de persoane care conduceau cu viteze de peste 180 km h, 17 peste 200 km h si ...

Anunt pierderi
www.infobraila.ro - Brăila
Comentarii comentariu

Cu bicicleta in Serbia si inapoi. La Jimbolia a fost deschis un popas turistic
www.tion.ro - Timiş
Un proiect realizat cu bani europeni în zona de graniţă dintre România şi Serbia, în Jimbolia, va deveni exemplu pentru derularea unor proiecte similare. Împreună cu o localitate sârbească, oraşul timişean a realizat un program cicloturistic care are deja desenate patru trasee.

Veşti bune de la meteorologi. Cum va fi vremea în Transilvania în următoarele două săptămâni
www.stiridecluj.ro - Cluj
Meteorologii de la ANM au emis o estimare a valorilor termice medii pentru perioada de pro...

FOTO-ULTIMĂ ORĂ: Accident pe DN2, la intersecţia cu drumul spre Coteşti. O femeie a fost rănită uşor
www.jurnaldevrancea.ro - Vrancea
Un accident rutier s-a produs în urmă cu puţin timp pe DN2E85, la intersecţia cu drumul judeţean care duce către Coteşti. În accident au fost implicate un | Jurnal de Vrancea

Neamţ: Femeie din Piatra-Neamţ, achitată pentru clonarea contului de Facebook al unei prietene
www.stiri-neamt.ro - Neamţ
O femeie de Piatra-Neamţ şi-a acţionat în instanţă fosta prietenă şi i-a cerut daune morale de 50.000 de euro pentru că i-ar fi clonat contul Facebook ca

Incendiu la un fânar. Trei echipaje de pompieri la faţa locului
sibiupresa.oradesibiu.ro - Sibiu
Un incendiu puternic s-a declanşat la un fânar care se află în câmp deschis, al ieşirea din Cârţişoara spre Arpaşu de Sus. Pentru a localiza şi stinge focul la faţa locului s-au deplasat trei echipaje…

Izvoare: Zile de sărbătoare
www.desteptarea.ro - Bacău
Comunitatea parohială romano-catolică din cartierul Izvoare a trăit în zilele de 6 şi 7 octombrie 2018 două momente marcante pentru viaţa sufletească a credincioşilor. Sâmbătă, 6 octombrie, îmbrăcată în straie de sărbătoare, l-a primit pe PS Aurel Percă, episcop auxiliar al Diecezei de Iaşi, care a prezidat sfânta Liturghie de sărbătorire a 70 de ani …

NASA a minţit? Imagini care „TRĂDEAZĂ” misiunea TOP-SECRET de pe MARTE. Video în articol
evz.ro - Bucureşti
Este cunoscut faptul că NASA desfăşoară de ani de zile misiuni speciale pentru a reuşi să trimită echipaj uman spre Marte în viitorii 20 de ani. Numai că un...

Zeci de kilograme de droguri confiscate de polţişti în doar 2 săptămâni. Peste 140 de persoane sunt cercetate
www.stiridecluj.ro - Cluj
Poliţia română, alături de DIICOT, a desfăşurat pe parcursul ultimelor dou

Comisarul Corina Creţu, acuză: Nu mai accept insultele din partea Guvernului României. Nu sunt proiecte scrise
www.stiridecluj.ro - Cluj
Comisarul Corina Creţu, acuză: Nu mai accept insultele din partea Guvernului României. Nu sunt proiecte scrise

Cladirea pericol de langa CNB se poate demola. Mai aproape de bazinul de inot si de sala de sport
www.tion.ro - Timiş
Una dintre cele mai bune grădiniţe din oraş, ajunsă astăzi o ruină, poate fi demolată în sfârşit de primărie. Este vorba despre fosta PP14 de lângă Colegiul Naţional Bănăţean, în locul căreia municipalitatea vrea să amenajeze o sală de sport cu bazin de înot. A venit şi ultimul aviz şi se poate trece la treabă.

Zeci de kilograme de droguri confiscate de polţişti în doar 2 săptămâni. Peste 140 de persoane sunt cercetate
www.stiridecluj.ro - Cluj
Poliţia română, alături de DIICOT, a desfăşurat pe parcursul ultimelor dou

Volei Alba Blaj, ultima repetiţie amicală înaintea debutului în Champions League | La Rzeszów, turneu extrem de puternic pentru vicecampioana Europei
ziarulunirea.ro - Alba
Pregătirile Volei Alba Blaj, vicecampioana Europei, în vederea tururilor preliminarii din Champions League, intră în linie dreaptă. Formaţia din “Mica Romă” a câştigat cele două turnee de verificare din ţară, Cupa Timişoara şi Cupa Blajului (în weekend, în Sala “Timotei Cipariu”), şi va lua startul, în weekend, la primul turneu internaţional din existenţă, în Polonia, […]

Proiectul Transdanube.Pearls - Retea de mobilitate sustenabila de-a lungul Dunarii“, la Tulcea. Vizita de studiu in Delta Dunarii
www.ziuaconstanta.ro - Constanţa
Vicepresedintele Consiliului Judetean Tulcea, Petre Badea, a participat la inceputul acestei luni la una dintre etapele proiectului Transdanube.Pearls - Retea de mobilitate sustenabila de-a lungul ...

Turcul se urcase băut la volan
ziarulargesul.ro - Argeş
În ultimele 24 de ore, agenţi ai Serviciului Rutier Argeş şi ci ai structurilor similare municipale şi orăşeneşti au aplicat 193 de amenzi în valoare de circa 52.000 , au reţinut în vederea suspendării 17 păermise de conducere şi au retras două certificate de înmatriculare. Unii dintre...

ATAC NEAȘTEPTAT de la Bruxelles. Corina Creţu ȘTERGE PE JOS cu lideri din PROPRIUL PARTID. „Nu mai ACCEPT INSULTE din partea GUVERNULUI”
evz.ro - Bucureşti
Comisarul european Corina Creţu a răbufnit din nou la adresa Guvernului României şi a reiterat că autostrada Iaşi-Târgu Mureş este o prioritate pentru Comis...

FOTO: în continuare, modernizări pe Stadionul “Minaur” din Zlatna! 1000 de scaune în tribuna întâi şi pregătiri pentru meciuri internaţionale
ziarulunirea.ro - Alba
Stadionul “Minaur” din Zlana a fost în centrul atenţiei în urmă cu două săptămâni, când a găzduit, în condiţii de apreciat, partida dintre Unirea Alba Iulia şi FCSB, contând pentru “16”-imile Cupei României. Cu acel prilej, singurei arene cu instalaţie de nocturnă din judeţul Alba i-au fost aduse o serie de modernizări: s-au montat 280 […]

19 octombrie 2018 – AJOFM Alba organizează Bursa locurilor de muncă pentru absolvenţi
ziarulunirea.ro - Alba
AJOFM Alba organizează Bursa locurilor de muncă pentru absolvenţi, în colaborare cu Centrul de Informare, Consiliere şi Orientare în Carieră din cadrul Universităţii „1 Decembrie 1918”, în Sala de conferinţe PAEM situată în Alba Iulia, strada Bucovinei, nr. 6 (Zona Piaţa Centru), începând cu ora 9.30. Absolvenţii unei forme de învăţământ, promoţia 2018, care încă nu şi-au […]

City managerul Oradiei, către cei care n-au mers la referendum: "La ce Dumnezeu vă închinaţi?"
www.ebihoreanul.ro - Bihor
Dacian Palladi, city managerul baptist al Oradiei, a avut, duminică seara, o ieşire vehementă 'îmbrăcată' în doctrine religioase la adresa celor care nu s-au dus la referendumul 'pentru familia tradiţională', ponegrindu-i pe aceştia şi întrebându-se: 'La ce Dumnezeu se închină ei?'.

Explicaţii pentru eşecul referendumului în Argeş
ziarulargesul.ro - Argeş
Duminică şi sâmbătă a avut loc referendumul pentru redefinirea căsătoriei în Constituţie, dar nici măcar 25% dintre alegători nu s-au prezentat la urne, aşa că referendumul nu a fost validat (ar fi fost nevoie de 30%). În Argeş au fost înscrise pe liste electorale 532.334 de persoane, dintre...

Prima reacţie a Patriarhiei după eşecul referendumului pentru familie
sibiupresa.oradesibiu.ro - Sibiu
Eşecul Referendumului pentru familie a făcut ca Patriarhia Română să aibă o reacţie în sensul îndemnării în continuare la unitatea familiei şi la cea spirituală. Reprezentanţii instituţiei le-a…

Accident mortal în Isla
www.zi-de-zi.ro - Mureş
Un conducător auto în vârstă de 23 de ani, din Republica Moldova, în timp ce conducea un autoturism,

Pedeapsa cu închisoarea, eliminată din legea construcţiilor
ziarulargesul.ro - Argeş
Senatul a adoptat tacit proiectul de lege prin care execuţia fără autorizaţie a lucrărilor de construcţii nu mai este sancţionată cu închisoarea. Propunerea legislativă îi are ca autori pe mai mulţi deputaţi, în frunte cu fostul ministru al Justiţiei Florin Iordache, aceştia susţinând că...

Doi ministri de Externe dezbat la Timisoara despre securitatea Balcanilor, in cadrul unei conferinte
www.tion.ro - Timiş
Cea de-a doua ediţie a conferinţei „Security Challenges in the Balkans” este gata de start. Cel mai important eveniment diplomatic organizat în zona de vest a României va avea loc marţi, la Timişoara, la Complexul Senator.

CUTREMUR la Înalta Curtea de Casaţie şi Justiţie. Gestul lui DRAGNEA te lasă FĂRĂ CUVINTE
evz.ro - Bucureşti
După Curtea Constituţională a fost sesizată de Guvern cu privire la un conflict juridic între Parlament şi ÎCCJ, referitor la compunerea completurilor de 5 ...

ULUITOR: Dragnea a dat în judecată Înalta Curte şi colegiul ei de conducere
evz.ro - Bucureşti
Liviu Dragnea, preşedintele PSD şi al Camerei Deputaţilor, a decis să dea în judecată Înalta Curte în cazul constituirii completului de 5 judecători care ju...

Referedumul pentru familie. CINE a pierdut cel mai MULT? Analiză de ULTIM MOMENT
evz.ro - Bucureşti
Referendumul pentru redefinirea familiei a avut loc de-a lungul a două zile - pe 6 şi pe 7 octombrie. Prezenţa finală la vot a fost de 20,41%, sub pragul de...
![Casa Alex, pregătită pentru iarnă! Tu ţi-ai pregătit casa? [FOTO]](/showimg/300-200--zi/images/fullinfo.ro-images/news-232893.jpg)
Casa Alex, pregătită pentru iarnă! Tu ţi-ai pregătit casa? [FOTO]
expressdebanat.ro - Caraş-Severin
Consecvenţă şi profesionalism sunt punctele cheie ale celei mai de succes afaceri din sudul Banatului. Casa Alex este business-ul ce promite să detroneze marile vârfuri din domeniul bricolajului.

Cornel Ionică rămâne primar!
ziarulargesul.ro - Argeş
După cum se ştie şi cotidianul nostru a relatat la larg, Înalta Curte de Justiţie şi Casaţie a decis că Cornel Ionică a pierdut procesul cu Agenţia Naţională de Integritate, motiv pentru care nu va mai putea fi primar al Piteştiului. Mulţi probabil că s-au bucurat la auzul acestei veşti, dar va...

FOTO: Teatrul ”Prichindel” din Alba Iulia, premiat la Festivalul Internaţional de Animaţie „Sub bagheta lui Merlin” din Timişoara
ziarulunirea.ro - Alba
Spectacolul Teatrului de Păpuşi „Prichindel” Alba Iulia, „Capra cu trei iezi”, în regia colectivă a Teodorei Popa, Irinei Melnic, Vioricăi Boda şi Ramonei Benchea-Mincu, a obţinut Premiul de POPULARITATE în cadrul Festivalului Internaţional de Animaţie „Sub bagheta lui Merlin”, ediţia a 3-a, Timişoara 2018. La această ediţie de festival au participat 16 trupe de teatru […]

Peste 1.400 de locuri de muncă neocupate la Cluj, la început de săptămână. Care sunt cele mai căutate meserii
www.stiridecluj.ro - Cluj
Potrivit datelor Agenţiei Naţionale pentru Ocuparea Forţei de Muncă (ANOFM), la nivel ...

Disproporţie impresiunantă la votul din Hunedoara: mai bine de 90 la sută dintre participanţi au spus „DA”
glasul-hd.ro - Hunedoara
Biroul Electoral de Circumscripţie Hunedoara a publicat astăzi rezultatele finale ale referendumului pentru familia tradiţională. Dintre cei prezenţi la vot, o proporţie covârşitoare au votat pentru modificarea Constituţiei astfel încât aceasta să precizeze clar faptul că o căsătorie poate avea loc doar între un bărbat şi o femeie (lucru speficat, totuşi, în Codul Civil). Dintre …

O micuţă voleibalistă are nevoie de mare ajutor!
ph-online.ro - Prahova
Sala Sporturilor Olimpia a fost, în week-end, gazda evenimentului caritabil organizat pentru ajutorarea familiei Alexandrei Bratu. Tânăra voleibalistă...

Incendii in lant: Un maramuresean a murit in propriul apartament
ziarmm.ro - Maramureş
Pompierii maramureseni au intervenit la 8 situatii de urgenta in intervalul 5-8 octombrie, anunta ISU Maramures. Vineri, 5 octombrie, militarii Detasamentului Baia Mare au intervenit pentru lichidarea

Liviu Dragnea dă în judecată Curtea Supremă
www.stiridecluj.ro - Cluj
Liviu Dragnea dă în judecată Curtea Supremă

Mary-Eugenia Pana: "Romania exporta doar 1,7% carne de porc in viu, pana la aparitia focarelor de Pesta Porcina Africana"
www.ziuaconstanta.ro - Constanţa
Romania exporta doar 1,7 carne de porc in viu, din total, pana la aparitia focarelor de Pesta Porcina Africana PPA , a declarat, luni, intr-o conferinta de specialitate, Mary-Eugenia Pana, ...

Rezultate finale referendum Sibiu – Câţi au spus DA şi câţi au spus NU
sibiupresa.oradesibiu.ro - Sibiu
Referendumul pentru modificarea Constituţiei nu a fost validat, dar dacă ar fi să se ia în considerare răspunsurile sibienilor care au participat la referendum Constituţia ar trebui modificată.

FOTO – Ritmul zilnic al lucrărilor de la stadionul Municipal – Încet şi foarte încet sau mai deloc
sibiupresa.oradesibiu.ro - Sibiu
Lucrările la stadionul Municipal ar fi trebuit să avanseze într-un ritm alert, dacă e să judecăm după promisiunile constructorului. În 22 septembrie FC Hermannstadt ar fi trebuit să joace acasă cu CFR…

Pesta porcină: Gospodăriile din Satu Mare se repopulează cu purcei santinelă
portalsm.ro - Satu Mare
Pesta porcină: Gospodăriile din Satu Mare se repopulează cu purcei santinelă

Accident in Ploiesti, pe strada Buda. Un buldoexcavator a intrat in coliziune cu o masina
ph-online.ro - Prahova
Un accident rutier s-a produs in urma cu putin timp pe strada Buda din Ploiesti, fiind implicate un autoturism si un buldoexcavator. In urma impactulu...

Parapantist accidentat la Bunloc
feedproxy.google.com - Braşov
Inspectoratul pentru Situaţii de Urgenţă (ISU) Braşov a fost solicitat să intervină pentru acordarea primului ajutor medical unui bărbat, de aproximativ 40 de ani, care a căzut cu parapanta, în zona Bunloc. „Intervenim cu un echipaj SMURD de terapie intensivă cu medic şi un echipaj Salvamont. Bărbatul este conştient”, a oferit informaţiile de la această

AJOFM Neamţ: 850 locuri de muncă vacante la data de 8 octombrie 2018
www.stiri-neamt.ro - Neamţ
Lista locurilor de muncă vacante înregistrate la data de 8 octombrie 2018. Total locuri de muncă vacante: 850 Agentia Locala pentru Ocuparea Fortei de

Lansare de carte „Imperiul Sacru. Mănăstiri şi biserici din nordul Moldovei”, de ...
feeds.monitorulsv.ro - Suceava
Ultima ora: Biblioteca Universitatii Stefan cel Mare din Suceava USV si Lectoratul de limba romana al USV de la Cernauti organizeaza lansarea cartii Imperiul Sacru. Manastiri si biserici din nordul Moldovei, editia a doua, revizuita, a scriitorului si artistului plastic sucevean Constantin Severin.

Popicarele, calificate în turul I al Ligii Campionilor
www.zi-de-zi.ro - Mureş
Campioana României la popice feminin Electromureş Romgaz Târgu-Mureş s-a clasat pe locul 6 în cadrul

Pietonul accidentat la Moşoaia, tot în comă
ziarulargesul.ro - Argeş
După accidentul de sâmbătă, tânărul lovit de maşină la Moşoaia are şanse tot mai mici de supravieţuire. Se află internat în continuare la Spitalul Judeţean, în comă indusă. Vă reamintim, a ajuns într-o asemenea situaţie după ce, băut fiind, s-a dezechilibrat la marginea drumului şi a călcat fix...

Mafiotul de lângă noi: Povestea lui Vito Bigione, unul dintre cei mai căutaţi mafioţi din lume, care se ascundea sub identitate falsă în Oradea
www.ebihoreanul.ro - Bihor
Vito Bigione, unul dintre cei mai căutaţi mafioţi din lume, a fost depistat şi arestat în Oradea. Italianul urmărit internaţional pentru o condamnare pentru trafic internaţional de droguri de mare risc, după ce pusese în legătură grupările Cosa Nostra şi ‘Ndrangheta şi cartelurile din America de Sud, se ascundea într-un bloc din cartierul Rogerius sub identitate falsă.

Concursul Naţional ”Pe Aripile Sunetului”, la Odorheiu Secuiesc. Șanse pentru talentele muzicale locale
ziarharghita.ro - Harghita
Concursul National de Interpretare Muzicală Pe Aripile Sunetului va fi prezent si în orasul Odorheiu Secuiesc, în perioada 27-28 Octombrie 2018.

VIDEO: Ce au votat vrâncenii la referendum
www.jurnaldevrancea.ro - Vrancea
Biroul Electoral Judeţean Vrancea a finalizat centralizarea rezultatului votului exprimat de alegătorii care au votat pe 6 şi 7 octombrie la referendumul | Jurnal de Vrancea

Referendum familie. Rezultate partiale: Au votat 21,08% dintre alegatori; 3.525.238 au spus 'DA'
www.ziuaconstanta.ro - Constanţa
La referendumul pentru redefinirea familiei au votat 21,08 dintre alegatori, potrivit datelor centralizate de Biroul Electoral Central, disponibile la ora 12,00, anuntate luni, scrie Agerpres.ro. Numarul ...

Casa de Pensii Neamţ: 187 bilete de tratament în perioada 30 octombrie – 01 noiembrie 2018
www.stiri-neamt.ro - Neamţ
Casa Judeţeană de Pensii Neamţ anunţă că pentru a şaptesprezecea serie de tratament balnear, ce are intrare în staţiuni perioada 30 octombrie - 01 Casa Judeţeană de Pensii Neamţ anunţă că pentru a şaptesprezecea serie de tratament balnear, ce are intrare în staţiuni perioada 30 octombrie

Cetateni straini gasiti in ilegalitate. Ce masuri au luat ofiterii de la Imigrari
www.ziuaconstanta.ro - Constanţa
Politistii Inspectoratului General pentru Imigrari desfasoara in permanenta activitati specifice pe linia prevenirii si combaterii migratiei ilegale si a muncii nedeclarate a strainilor, in scopul ...

FOTO Căţel pierdut într-un accident pe Valea Oltului găsit după cinci săptămâni de un poliţist
sibiupresa.oradesibiu.ro - Sibiu
Poliţistul Daniel Stoenete, din cadrul Serviciului Rutier Vâlcea, a găsit căţelul unei familii de ruşi, animalul pierzând-se în urma unui accident rutier care a avut loc la începutul lunii septembrie…

Serviciul de Stare Civila Constanta. Publicatii de casatorie 5 octombrie 2018
www.ziuaconstanta.ro - Constanţa
Obreja Nicu Sardaru Stefania-Marinela Dima Alexandru-Adrian Coroma Elena Radu Vasile Gabriel Draghici Diana Andreea Puscarencu Daniel Pasan Madalina-Florentina Poenaru Adrian Tudor Maria ...

Doliu în presa din România! S-a stins din viaţă un CELEBRU JURNALIST
evz.ro - Bucureşti
Jurnalistul Tiberiu Cosovan, Coso pentru prieteni, a murit la doar 64 de ani. În ultima perioadă, Tiberiu Cosovan a activat la Monitorul de Suceava. ...

Judetul Constanta. Suspect de furt din locuinta, retinut de politisti. Care este valoarea prejudiciului
www.ziuaconstanta.ro - Constanţa
Ca urmare a cercetarilor in cazul savarsirii unei infractiuni de furt calificat, politistii din cadrul Politiei orasului Negru Voda au identificat un barbat, in varsta de 31 de ani, din Negru Voda, ...

Ce mâncăm, ce bem şi ce vedem la „Toamna Piteşteană”
ziarulargesul.ro - Argeş
Ne aşteaptă încă o săptămână de răsfăţ culinar şi voie-bună pe Strada Mare din Piteşti. Târgul de produse tradiţionale "Toamna Piteşteană" a debutat în forţă şi este motivul pentru care unii piteşteni s-au învoit câteva ore de la serviciu pentru a admira mărunţişurile expuse de comercianţi. Dacă...

FOTO, VIDEO. Accident în cartierul Bărăbanţ din Alba Iulia: O maşină s-a răsturnat, iar alta s-a izbit de un stâlp de electricitate
ziarulunirea.ro - Alba
Un accident a avut loc, luni, în cartierul Bărbanţ din Alba Iulia, între două autoturisme, care au intrat în coliziune circulând în aceeaşi direcţie de mers. Potrivit martorilor, ambele maşini veneau dinspre sensul giratoriu de pe DN 1, iar unul dintre şoferi a semnalizat că virează stânga, în vreme ce şoferul din spate nu a […]

Referendumul pentru familie: dosar penal pentru vot multiplu la Sighişoara
www.zi-de-zi.ro - Mureş
Biroul de presă al Inspectoratului de Poliţie Judeţean (IPJ) Mureş a confirmat săvârşirea infracţiun

Marea Mediterana: Spania a salvat aproape 1.200 de migranti in ultimele 48 de ore
ziarmm.ro - Maramureş
Garda de coasta spaniola a anuntat duminica, potrivit AFP, ca a salvat de pe Marea Mediterana, in cursul ultimelor 48 de ore, aproape 1.200 de migranti care, cu ajutorul unor ambarcatiuni improvizate,

Trump - pe punctul de a CÂȘTIGA Războiul cu China
evz.ro - Bucureşti
În ciuda ameninţării cu represalii fiscale, autorităţile comuniste chineze ştiu deja că au pierdut ciocnirea economică cu Donald Trump....

BOMBĂ la EXATLON. Iubita unui CONCURENT a apărut GOALĂ pe internet. S-a văzut ABSOLUT TOTUL - Foto INTERZISE CARDIACILOR
evz.ro - Bucureşti
Bombă la Exatlon. Iubita faimosului concurent Yamato Zaharia a apărut goală pe internet. Blonda Nu a avut nicio inhibiţie să se dezbrace în faţa camerei....

13 calificari in finale si 7 medalii pentru sportivii de la Galactic Dance la “Cupa Maramuresului”
ziarmm.ro - Maramureş
Sambata, 6 Octombrie, orasul Baia Sprie a fost gazda celei de-a 6-a editii a Concursului de Dans Sportiv "Cupa Maramuresului'', concurs in cadrul caruia sportivii baimareni de la Galactic Dance, antre

Doi tineri au fost tăiaţi cu briceagul, în timpul unui conflict la Rovinari
www.gorjeanul.ro - Gorj
Un conflict a izbucnit, aseară, între mai multe persoane, în oraşul Rovinari. La data de 7 octombrie, poliţiştii din cadrul Poliţiei oraşului Rovinari au fost sesizaţi, prin apelul 112 de o tânără de 19 ani, din oraşul Rovinari, despre faptul că a identificat o persoană agres

FOTO, VIDEO. Accident în cartierul Bărăbanţ din Alba Iulia: O maşină s-a răsturnat, iar alta s-a izbit de un stâlp de electricitate
ziarulunirea.ro - Alba
Un accident a avut loc, luni, în cartierul Bărbanţ din Alba Iulia, între două autoturisme, care au intrat în coliziune circulând în aceeaşi direcţie de mers. Potrivit martorilor, ambele maşini veneau dinspre sensul giratoriu de pe DN 1, iar unul dintre şoferi a semnalizat că virează stânga, în vreme ce şoferul din spate nu a […]

O noua companie de top in ansamblul Openville Timisoara: Microsoft Romania
www.tion.ro - Timiş
Companiile IULIUS şi Microsoft România au semnat un contract de închiriere pentru un spaţiu de birouri în ansamblul Openville Timişoara, cea mai mare dezvoltare cu destinaţie mixtă din vestul ţării.

Cum va fi VREMEA până în 21 octombrie, în Transilvania. ANM a publicat prognoza meteo pentru următoarele două săptămâni
ziarulunirea.ro - Alba
Prognoza Administraţiei Naţionale de Meteorologie (ANM) pentru intervalul 8-21 octombrie 2018, publicată luni, arată că temperaturile vor fi oscilante în următoarele două săptămâni în toată ţara, cu maxime de până la 21 de grade în Transilvania, iar probabilitatea de apariţie a ploilor va fi în general redusă. Intervalului de prognoză va fi caracterizat de o […]

„Promoţie” de la Guvern! Românii cu datorii la stat vor primi o reducere dacă îşi achită dările înainte de termen
ph-online.ro - Prahova
Românii care au datorii la stat vor primi o reducere de 10-15% dacă îşi achită dările până în luna decembrie, potrivit unui proiect aflat în lucru la...

Care este anuntul facut Coalitia pentru familie, dupa esecul referendumului
www.ziuaconstanta.ro - Constanţa
Coalitia pentru familie a anuntat astazi ca a fost dizolvat Comitetul de initiativa cetateneasca pentru revizuirea Constitutiei, iar conducerea isi exprima recunostinta pentru cei care au votat ...

Încălzirea globală va distruge Pământul până în anul 2030. Specialiştii avertizează
ph-online.ro - Prahova
Intergovernmental Panel on Climate Change (IPCC), instituţia din cadrul Naţiunilor Unite care se ocupă de evaluarea riscurilor asupra încălzirii globa...

Un finanţator vorbeşte despre BLATURILE din fotbalul românesc: „Am primit propuneri indecente. Nu contează cum sunau, nu vreau să le mai zic”
evz.ro - Bucureşti
Adrian Mititelu, finanţatorul echipei FC „U” Craiova, a povestit despre jocurile de culise care se făceau în fotbalul românesc. ...

Probleme la etaj. Directorii Primariei Baia Mare tremura. Unii raman fara functii
ziarmm.ro - Maramureş
Conducerea Primariei Baia Mare intentioneaza sa reduca mai multe posturi de directori. Anuntul a fost facut pe site-ul institutiei. Pentru ca noua organigrama sa intre in vigoare, cu data de 1 decembr

Neamţ: Referendumul, Ionel Arsene şi „chemarea Bisericilor Creştine”
www.stiri-neamt.ro - Neamţ
Pe 1 octombrie, organizaţia PSD Neamţ îşi asuma popularizarea acestui referendum. După o prezenţă care va duce la invalidarea referendumului, Ionel Arsene

Șoferi morţi de beţi, prinşi circulând pe drumurile Sătmarului. Poliţiştii i-au pus la punct
portalsm.ro - Satu Mare
Șoferi morţi de beţi, prinşi circulând pe drumurile Sătmarului. Poliţiştii i-au pus la punct

VIDEO: Scandal la spitalul din Rovinari, după moartea unei femei din Teleşti
www.gorjeanul.ro - Gorj
O femeie de 57 de ani, din satul Șomăneşti, comuna Teleşti, a murit aseară, la Spitalul Sfântul Ștefan din Rovinari, rudele acuzându-i pe medici de nepăsare. A fost nevoie de intervenţia poliţiştilor, pentru calmarea spiritelor. Reprezentanţii IPJ Gorj au precizat că efectuează cerc

Medifun revine cu muzică bună, competiţii sportive şi socializare de calitate
www.zi-de-zi.ro - Mureş
Festivalul studenţesc Medifun, concept unic în România, se va desfăşura în perioada 10-14 octombrie.

Încătuşat! Şoferul care, beat fiind, provocat un accident mortal în Nucet a fost reţinut
www.ebihoreanul.ro - Bihor
Bărbatul în vârstă de 30 ani din comuna Câmpani care, duminică dimineaţă, beat fiind, a provocat un accident mortal din localitatea Nucet, a fost reţinut pentru 24 de ore, iar luni procurorii Parchetului de pe lângă Judecătoria Beiuş intenţionează să-i ceară arestarea.

18 medalii si alte 9 finale pentru Prodance 2000 la Cupa Maramuresului
ziarmm.ro - Maramureş
Sportivii de la scoala de dans Prodance 2000 Baia Mare au reusit calificarea in 27 de finale, din care au obtinut 18 medalii la Concursul „Cupa Maramuresului”, desfasurat sambata si duminica, 6 octomb

Coaliţia pentru Famile, DECIZIE RADICALĂ. Ce se va întâmpla cu ORGANIZAȚIA după EȘECUL REFERENDUMULUI
evz.ro - Bucureşti
Luni, pe pagina de Facebook, Coaliţia pentru familie a anunţat că a fost dizolvat Comitetul de iniţiativă cetăţenească pentru revizuirea Constituţiei, iar ...

Recompensă! Pe cine şi-a luat Viorica Dăncilă consilier. Personajul este o surpriză totală
evz.ro - Bucureşti
Premierul Viorica Dăncilă are un nou consilier pe probleme sociale de la 1 octombrie. Personajul este deja cunoscut. Acesta este şeful de cabinet al lui Cod...

Peste 1.200 de tineri au primit terenuri gratuite în judeţ – Șelimbărul conduce detaşat
presasibiu.oradesibiu.ro - Sibiu
Aproape cincizeci de hectare de teren au împărţit primăriile din judeţul Sibiu pentru tineri. Cele mai multe s-au dat la Șelimbăr, peste 500 de tineri fiind beneficiari ai unor atfel de terenuri…

Aviz negativ pentru propunerea de numire a Adinei Florea la sefia DNA
www.ziuaconstanta.ro - Constanţa
Sectia pentru procurori a Consiliului Superior al Magistraturii a avizat negativ, luni, propunerea ministrului Justitiei, Tudorel Toader, de numire a Adinei Florea ca procuror sef al DNA, au precizat pentru ...

Neamţ: Riscă închisoarea pentru că a refuzat să-i fie recoltate probele biologice
www.stiri-neamt.ro - Neamţ
Duminică, 7 octombrie, poliţiştii din cadrul Postului de Poliţie Horia au depistat un localnic, de 48 de ani, care conducea un autoturism, în timp ce se

ReferendumFamilie/ BEC – rezultate partiale: Au votat 21,08% dintre alegatori; 3.525.238 au spus ‘DA’
ziarmm.ro - Maramureş
La referendumul pentru redefinirea familiei au votat 21,08% dintre alegatori, potrivit datelor centralizate de Biroul Electoral Central, disponibile la ora 12,00, anuntate luni, informeaza AGERPRES. N

Neamţ: Riscă închisoarea pentru că a refuzat să fie testat alcoolscopic
www.stiri-neamt.ro - Neamţ
Duminică, 7 octombrie, poliţiştii din cadrul Postului de Poliţie Horia au depistat un localnic, de 48 de ani, care conducea un autoturism, în timp ce se

Femeie înecată în râul Vedea, la Conţeşti
ziarulteleormanul.ro - Teleorman
O femeie de 66 de ani, din Conţeşti, şi-a pierdut viaţa sâmbătă, 6 octombrie, în apele râului Vedea, trupul neînsufleţit al acesteia fiind descoperit de un bărbat din localitate, care a şi anunţat poliţia. Potrivit purtătorului de cuvânt al IPJ Teleorman, inspector Teodora Dragole, cadavrul femeii, care la o primă analiză nu prezenta urme de violenţă, a fost preluat şi transportat la morga spitalului. În acest caz a fost întocmit un dosar penal pentru moarte suspectă, urmând a se propune soluţie prin Parchet, a mai precizat sursa citată.

CSM, aviz negativ in cazul Adinei Florea, propusa de Tudorel Toader pentru sefia DNA
ziarmm.ro - Maramureş
Adina Florea, propusa de ministrul Justitiei pentru ocuparea functiei de procuror-sef al Directiei Nationale Anticoruptie, a sustinut luni interviul in fata sectiei pentru procurori a CSM. Avizul este

Refugii montane în munţii Călimani, care pot fi folosite în caz de nevoie
ziarharghita.ro - Harghita
Salvamont Salvaspeo Mureş a finalizat de ansamblat la începutul lunii acesteia 4 refugii montane, care au fost amplasate în Parcul Naţional Călimani, din

De cât succes s-a bucurat referendumul în fiecare oraş şi comună din Bistriţa-Năsăud
www.timponline.ro - Bistriţa-Năsăud
La referendumul pentru definirea familiei, judeţul Bistriţa-Năsăud a avut o prezenţă la vot peste media naţională, procent asigurat de 51 de unităţi administrativ-teritoriale. În alte 11, procentele au fost sub cele naţionale, printre acestea numărându-se şi municipiul Bistriţa cu o participare la v

Raport nefavorabil pentru masurile alternative de executare a pedepselor, in comisiile de specialitate
www.ziuaconstanta.ro - Constanţa
Comisiile juridica si pentru constitutionalitate din Senat au dat, luni, raport comun de respingere a proiectului legislativ privind masurile alternative de executare a pedepselor privative de libertate, ...

De marti se lucreaza pe centura de ocolire a Caransebesului
www.tion.ro - Timiş
Timişorenii care au drum spre Craiova, dar şi spre Bucureşti, pe vechiul drum naţional, vor trebui să ţină seama că de marţi se vor efectua o serie de lucrări pe centura de ocolire a Caransebeşului. Afectate de reparaţii vor fi şi alte drumuri naţionale din zonă.

Hala plina cu deseuri lemnoase cuprinsa de flacari, la Jimbolia
www.tion.ro - Timiş
Incendiu puternic, luni dimineaţă în jurul orei 4.50, pe raza localităţii Jimbolia. O hală dezafectată a fost cuprinsă de flăcări, iar incendiul nu a fost lichidat complet până la ora redactării acestei ştiri. Spaţiul era plin cu 300 de tone de deşeuri lemnoase.

DEZASTRU la ieşirea din ţară! Timp de aşteptare de până la OPT ORE
newsar.ro - Arad
Citeşte azi ce scriu ziarele de mâine!

Naţional: Prima reacţie a Bisericii după referendum
www.stiri-neamt.ro - Neamţ
În urma invalidării referendumului din 6-7 octombrie 2018 pentru redefinirea căsătoriei, Patriarhia Română îndeamnă la unitate spirituală şi la apărarea

Lovitură dată de Digi 24. Șoc pentru RTV şi Antena 3
evz.ro - Bucureşti
Posturile de ştiri au înregistrat audienţe mai mari, ieri, însă clasamentul a fost complet diferit....

Ce hrană primeşte Elena Udrea în închisoarea din Costa Rica: ”Ne-au dat linte cu viermi”
www.stiridecluj.ro - Cluj
Ce hrană primeşte Elena Udrea în închisoarea din Costa Rica: ”Ne-au dat linte cu viermi”

Piatra-Neamţ: Poliţia Locală, amenzi de 24.470 de lei într-o săptămână
www.stiri-neamt.ro - Neamţ
142 de sanctiuni contraventionale in valoare de 24.470 lei au fost acordate de Politia Locala din subordinea Primariei Piatra Neamt in prima saptamana din

Victorie importantă, demnă pentru un lider
www.zi-de-zi.ro - Mureş
Cinste lor, cinste mureşencelor În penultima etapă a primului tur din Divizia A de handbal feminin,

DISTRACȚIE ȘI VOIE BUNĂ LA ZIUA RECOLTEI
www.gorjeanul.ro - Gorj
https://www.youtube.com/watch?v=hYWRllKPKyA&feature=youtu.be

Ce hrană primşte Elena Udrea în închisoarea din Costa Rica: ”Ne-au dat linte cu viermi”
www.stiridecluj.ro - Cluj
Ce hrană primşte Elena Udrea în închisoarea din Costa Rica: ”Ne-au dat linte cu viermi”

Zeci de incendii de vegetatie uscata, in weekend, in Timis
www.tion.ro - Timiş
Weekend plin pentru pompierii timişeni, în judeţul Timiş. Salvatorii au fost chemaţi să intervină la 30 de incendii de vegetaţie uscată în ultimele trei zile. Incendierea spaţiilor pentru igienizare se poate face doar cu avizul autorităţilor, anunţă cei de la ISU Banat.

AVERTISMENT de ULTIMĂ ORĂ. ORBAN îi previne pe LIBERALII care îl critică
evz.ro - Bucureşti
Preşedintele PNL, Ludovic Orban, a afirmat luni că ar fi preferat ca poziţiile publice exprimate de unii colegii ai săi la adresa conducerii partidului....

Melescanu: "Potentialul relatiei bilaterale romano-olandeze este mult mai mare"
www.ziuaconstanta.ro - Constanţa
Ministrul Afacerilor Externe, Teodor Melescanu, a declarat luni, in urma intalnirii cu omologul olandez Stef Blok, ca in planul cooperarii economice relatia dintre cele doua tari are in continuare foarte ...

REFERENDUMUL PENTRU FAMILIE: Peste 90% dintre alegători, adică peste 3,4 milioane, au votat ”Da”
ziarulunirea.ro - Alba
La referendumul pentru redefinirea familiei au votat 20,96% dintre alegători, conform datelor centralizate de Biroul Electoral Central, disponibile la ora 9,00, anunţate luni dimineaţa. Numărul total al persoanelor care s-au prezentat la urne a fost de 3.778.716. Numărul voturilor valabil exprimate la răspunsul ‘DA’ a fost de 3.461.581 (91,61% din numărul participanţilor), numărul voturilor valabil […]

Ronaldo ar fi suspectat şi de pedofilie
www.stiridecluj.ro - Cluj
Ronaldo ar fi suspectat şi de pedofilie

Cum poţi afla dacă CNP-ul tău a votat la referendum
ph-online.ro - Prahova
Asociaţia pentru Apărarea Drepturilor Omului - Comitetul Helsinki (APADOR-CH) a publicat pe pagina sa web un ghid pe care românii îl pot folosi pentru...

Peste 23.000 de spectatori, in total, la primul eveniment produs in cadrul programului BEGA!
www.tion.ro - Timiş
BEGA! prezintă Lumen a însemnat 135 de minute de spectacol excepţional, 200 de voluntari şi 23.500 de spectatori care au trait emoţii intense!

Neamţ: Cinci incendii stinse de pompieri într-o singură zi
www.stiri-neamt.ro - Neamţ
Misiune de stingere incendiu produs la o anexă particulară în localitatea Brusturi Duminică, 07.10.2018, la ora 14:13, Dispeceratul Integrat ISU -

Autorităţile au intrat în alertă după ce au apărut crăpături în asfalt în zona unor blocuri din Centru
stiridegalati.ro - Galaţi
Vor fi făcute expertize tehnice pentru a vedea de unde provin aceste fisuri.

Păţania unui american din Carolina de Nord care gonea pe DN 17
www.timponline.ro - Bistriţa-Năsăud
Un tânăr de 24 de ani, cetăţean al statului Carolina de Nord, care a încercat puterea maşinii pe care o conducea pe DN 17, a avut parte de o zi de duminică plină de ghinion. Oprit de poliţişti pentru depăşirea vitezei legale, şoferul nu a putut prezenta un permis de conducere internaţional, motiv pe

Adina Florea, propusa la sefia DNA: Nu ma hazardez sa fac comentarii cu privire la legile Justitiei
ziarmm.ro - Maramureş
Procurorul Adina Florea, propusa la functia de sef al DNA, nu a dorit sa isi exprime, luni, opinia cu privire la modificarea legilor Justitiei, precizand ca va "astepta" aceste modificari, informeaza

Referendumul pentru familie: comunele din Mureş cu cea mai slabă prezenţă la vot
www.zi-de-zi.ro - Mureş
Potrivit informaţiilor furnizate de Biroul Electoral Central, la nivelul judeţului Mureş au particip

Autoturism în flăcări pe DN 13A
ziarharghita.ro - Harghita
Sâmbătă, 06.10.2018, la ora 13:48, pompierii militari din cadrul Detaşamentului Odorheiu Secuiesc au fost alertaţi de izbucnirea unui incendiu la un

Il Giornale: În România referendumul pentru abolirea căsătoriilor homsexuale n-a trecut
evz.ro - Bucureşti
Presa internaţională are primele reacţii despre Referendumul promovat de guvernul de centru-stânga al României pentru modificarea Constituţiei în sensul in...

SRI se pregăteşte pentru RĂZBOIUL CIBERNETIC. Ce este CyDEx18. A fost nevoie de IMPLICAREA MApN, MAI, MAE, STS, SPP, SIE, ORNISS, CERT-RO
evz.ro - Bucureşti
SRI organizează cel mai important exerciţiu de securitate cibernetică din România. CyDEx18 este organizat, prin intermediul Centrului Naţional Cyberint (CNC...

Cadavrul unui bărbat a fost găsit în barajul de acumulare din Aştileu(FOTO)
www.ebihoreanul.ro - Bihor
Cadavrul unui bărbat a fost găsit, luni, în barajul de acumulare din Aştileu, procurorii Parchetului de pe lângă Tribunalul Bihor declanşând o anchetă pentru stabilirea circumstanţelor în care a murit victima.

Sfârşit de săptămână aglomerat pentru Ambulanţă/ 18 solicitări au avut la bază conflicte şi agresiuni fizice, alte patru pentru tentativă de suicid
ziarulteleormanul.ro - Teleorman
528 de solicitări au fost înregistrate de Serviciul Judeţean de Ambulanţă în perioada 5 octombrie, ora 00.00– 8 octombrie, ora 08.00, pentru trei persoane fiind constatat decesul, în aceeaşi perioadă, potrivit raportului SAJ Teleorman. Totodată, conform informaţiilor furnizate, pe raza judeţului, echipajele Serviciului de Ambulanţă au intervenit şi în şase accidente rutiere petrecute pe raza judeţului, soldate cu 13 victime. Potrivit raportului SAJ Teleorman, în intervalul menţionat, cele mai multe solicitări, respectiv 63, au fost pentru dureri abdominale sau de spate, în timp ce alte 28 de s

BOR: Invalidarea Referendumului „a oferit posibilitatea de a cunoaşte gradul de secularizare al societăţii româneşti”
ziarharghita.ro - Harghita
Referendumul pentru redefinirea căsătoriei a fost invalidat din lipsă de cvorum. Biserica Ortodoxă Română a reacţionat şi a emis următorul comunicat:

Neamţ: Un şofer beat a produs un accident cu victime şi a fugit de la locul faptei
www.stiri-neamt.ro - Neamţ
Aseară, în jurul orelor 20.00, poliţiştii din cadrul Secţiei de Poliţie Bicaz au intervenit la un accident rutier, soldat cu vătămarea corporală a două

Controale ale ANSVA in industria agroalimentara. Au fost aplicate amenzi
www.ziuaconstanta.ro - Constanţa
In cursul lunii septembrie 2018, Directiile judetene sanitare veterinare si pentru siguranta alimentelor precum si a municipiului Bucuresti au desfasurat 8.568 de controale in unitatile din industria ...

ULTIMĂ ORĂ: Avarii în lanţ la reţeaua de termoficare! Mai multe cartiere, fără apă caldă
www.jurnaldevrancea.ro - Vrancea
O serie de avarii s-au produs pe reţeaua primară de termoficare a ENET SA Focşani. Sunt afectate cartierul Gară, bulevardul Independenţei şi cartierul | Jurnal de Vrancea

BNR: Decizie privind creditele de refinanţate. Noi modalităţi de calcul
ziarulunirea.ro - Alba
Banca Naţională va stabili noi modalităţi de calcul a gradului de îndatorare a solicitanţilor unui credit, urmând ca împrumuturile destinate refinanţării altor credite să nu fie incluse în calculul îndatorării. Refinanţarea creditelor ar urma să facă excepţie de la măsura de limitare a gradului de îndatorare a populaţiei, a afirmat, sâmbătă, la Sinaia, preşedintele Consiliului […]

O nouă acţiune de dezinsecţie în municipiul Satu Mare
portalsm.ro - Satu Mare
Din punct de vedere al eficienţei aplicării măsurilor de combatere şi eliminare a unor potenţiale focare de infecţie, actiunile de dezinsecţie trebuie tratate în mod unitar atât pe domeniul public cât şi privat, spaţii deschise ale persoanelor fizice şi juridice la nivelul localităţii, dezinsecţie...

Cluj: Gemuri şi murături din regiunea Scaunul Secuiesc al Arieşului
www.stiridecluj.ro - Cluj
Cluj: Gemuri şi murături din regiunea Scaunul Secuiesc al Arieşului
![[FOTO] Neamţ: Autoutilitară incendiată intenţionat azi-noapte](/showimg/300-200--zi/images/fullinfo.ro-images/news-232787.jpg)
[FOTO] Neamţ: Autoutilitară incendiată intenţionat azi-noapte
www.stiri-neamt.ro - Neamţ
Duminică, 08.10.2018, la ora 01:24, Dispeceratul Integrat ISU - Ambulanţă al judeţului Neamţ a fost anunţat prin Sistemul Naţional Unic pentru Apeluri de

Ce i s-a întâmplat unui bărbat din Suceava care a vrut, cu orice preţ, să aibă o relaţie cu o tânără din Chiochiş
www.timponline.ro - Bistriţa-Năsăud
Un bărbat din judeţul Suceava care a vrut, cu orice preţ, să aibă o relaţie cu o tânără din Chiochiş, a avut parte de un sfârşit de săptămână tumultos. După ce timp de opt luni au căutat dovezi împotriva lui, poliţiştii l-au reţinut pentru 24 de ore acuzându-l că a ameninţat, hărţuit şi şantajat o t

Infractori căutaţi în toată România, pentru comiterea unei tâlhării în Austria. Îi recunoaşteţi? FOTO
www.stiridecluj.ro - Cluj
Poliţia Română a primit o cerere de asistenţă poliţienească, formulată de...

Becali a răbufnit după înfrângerea cu Chiajna: „Suntem în prăpastie. Îl dau afară!”
evz.ro - Bucureşti
FCSB a pierdut, aseară, duelul de pe teren propriu cu Concordia Chiajna, iar Gigi Becali a ordonat scoaterea unui jucător din echipa de start....

Zeci de vitezomani amendaţi de poliţişti la Cluj-Napoca
www.stiridecluj.ro - Cluj
Poliţiştii Biroului Rutier Cluj-Napoca au desfăşurat, în perioada 6 &nda...

Viorica Dancila intrevedere cu prim-ministru al Republicii Franceze
www.ziuaconstanta.ro - Constanţa
Astazi, 8 octombrie 2018, prim-ministrul Viorica Dancila l-a primit la Palatul Victoria pe fostul premier francez Dominique de Villepin, care desfasoara, in prezent, activitati in domeniul consultantei ...

Record de viteză pe autostradă, săptămâna trecută – 234 km/h pe A1. Alţi 17 şoferi au fost depistaţi circulând cu peste 200 km/h
ziarulunirea.ro - Alba
Poliţiştii Brigăzii Autostrăzi şi Misiuni Speciale a Poliţiei Române au depistat, în prima săptămână a lunii octombrie, 70 de persoane care conduceau cu viteze de peste 180 km/h, 17 peste 200 km/h şi 3 care conduceau sub influenţa alcoolului. Cea mai mare viteză înregistrată de radar a fost de 234 km/h, pe autostrada A1. În […]

16 permise de conducere retinute de politistii maramureseni sambata si duminica
ziarmm.ro - Maramureş
Sambata si duminica, politistii rutieri au oprit pentru verificari peste 200 de autovehicule care circulau pe raza judetului Maramures. Pentru neregulile constatate au fost aplicate 96 de sanctiuni co

Naţional: Un tânăr din Piatra-Neamţ a accidentat mortal un biciclist
www.stiri-neamt.ro - Neamţ
Un tânăr din Piatra-Neamţ a accidentat mortal un biciclist în timp ce conducea un autoturism pe DN2 (direcţia Bucureşti - Focşani), în judeţul Vrancea.

Două persoane au fost victimele unui accident rutier produs de un şofer beat din Bălan
ziarharghita.ro - Harghita
Neacordarea de prioritate, pe fondul consumului de alcool, cauza unui accident rutier produs pe D.N.E. 578, în comuna Sândominic La data de 05.10.2018, în

Scandal în trafic provocat de un şofer beat şi de fratele său
feeds.monitorulsv.ro - Suceava
Ultima ora: Un barbat care conducea o masina desi abia se putea tine pe picioare a fost tras pe dreapta de politistii de la Marginea. S-a intamplat duminica seara iar dupa ce masina a fost oprita a urmat si un scandal, provocat in special de fratele soferului, care era si el in masina. Duminica seara, in jur de ora 18.

Tot mai mulţi şoferi inconştienţi pe străzile Clujului? Un bărbat a fost prins la volan cu alcoolemie URIAȘĂ şi fără permis
www.stiridecluj.ro - Cluj
Poliţiştii clujeni cercetează un bărbat din comuna Mociu, judeţul Cluj, pentru comite...

Amenzi de 185.000 de lei date de Protecţia Consumatorilor în ultima lună de vară
ziarulteleormanul.ro - Teleorman
90 de acţiuni de control au desfăşurat comisarii din cadrul Comisariatului pentru Protecţia Consumatorilor Teleorman, pe parcursul lunii august, în urma acestora fiind aplicate 47 de amenzi contravenţionale în valoare de 185.000 de lei şi 27 de avertismente, se arată într-un raport al instituţiei. Acţiunile de control s-au desfăşurat în reşedinţa de judeţ (în proporţie de 28,89%), în celelalte municipii şi oraşe (în proporţie de 17,78%) şi în mediul rural (în proporţie de 53,33%). Din totalul produselor controlate, în valoare de 495.141 de lei, au fost depistate cu abateri produse în valoare d

SĂRBĂTOARE LA SPITALUL TÂRGU-CĂRBUNEȘTI
www.gorjeanul.ro - Gorj
https://www.youtube.com/watch?v=PGjjrScD_yg&feature=youtu.be

Referendum fara incidente in judetul Maramures
ziarmm.ro - Maramureş
Peste 300 de politisti, alaturi de jandarmi, pompieri, politisti de frontiera si reprezentantii celorlalte structuri teritoriale ale Ministerului Afacerilor Interne, au fost angrenati in organizarea s

Pieton lovit grav de un şofer de aproape 70 de ani, pe strada Plopilor. Traversa regulamentar
www.stiridecluj.ro - Cluj
Un accident rutier, soldat cu rănirea gravă a unei persoane, a avut loc, sâmb

ÎNSCENARE ca la carte, dupa "reţeta Portocalã"! Cum a EXECUTAT DNA un avocat celebru FĂRĂ NICIO PROBĂ
ph-online.ro - Prahova
Avocatul Tudorel Dobre a fost trimis în judecată de DNA pentru trafic de influenţă, dar a fost achitat de Curtea de Apel Constanţa, care a decis că ar...

Minor din Șona, prins conducând fără permis un ATV neînmatriculat/ Vârstnic din Teiuş – băut la volan
ziarulunirea.ro - Alba
La data de 07 octombrie 2018, poliţiştii Secţiei 6 Poliţie Rurală Jidvei, în timp ce acţionau pe DJ 107 V, în apropriere de localitatea Alecuş, l-au depistat pe un minor de 17 ani, din comuna Şona, în timp ce circula cu un ATV fără a poseda permis de conducere pentru nicio categorie de autovehicule şi […]

Parisul a luat-o razna: Promovează învăţarea limbii arabe în şcoli
evz.ro - Bucureşti
În Franţa creşte numărul înscrierilor în şcolile religioase catolice. Dar guvernul anunţă reduceri de posturi şi se gândeşte mai bine la cum să promoveze li...

Părinţi puşi de grădiniţă să dea bani pentru săpun, şerveţele şi salariul unei îngrijitoare
ph-online.ro - Prahova
Învăţământul de stat este gratuit doar cu numele, se plâng sute de părinţi la început de an şcolar. Mulţi spun că trebuie să plătească diverse materia...

Dosar penal pentru un tânăr din Teiuş care a condus la Alba Iulia o maşină neînmatriculată
ziarulunirea.ro - Alba
La data de 7 octombrie 2018, în jurul orei 11.00, poliţiştii Serviciului Rutier Alba, în timp ce acţionau pe B-dul Ferdinand din Alba Iulia, au oprit, pentru control, un autoturism condus de un tânăr de 25 de ani, din Teiuş. În urma verificărilor efectuate, poliţiştii au constatat că autoturismul nu era înmatriculat în circulaţie. Faţă […]

Romani, cautati de Politie dupa ce au talharit o casa din Austria
www.ziuaconstanta.ro - Constanţa
La data de 2 august 2018, ora 18.25, un barbat a intrat intr-o casa din Klagenfurt si s-a indreptat catre apartamentul victimei, pe care a imobilizat-o, lovit-o si talharit-o, aceasta suferind leziuni ...

Torţionarul Alexandru Vişinescu, la SPITAL cu fracturi costale şi ruptură de splină
ph-online.ro - Prahova
Torţionarul Alexandru Vişinescu a fost internat, sâmbătă, la Spitalul Bagdasar Arseni din Capitală, cu fracturi costale şi ruptură de splină, fiind mo...

Cugirean prins băut la volan pe raza comunei Vinţu de Jos, condus la spital
ziarulunirea.ro - Alba
La data de 07 octombrie 2018, în jurul orei 02.15, poliţiştii Secţiei 2 Poliţie Rurală Vinţu de Jos, în timp ce acţionau pe DJ 107 C, pe raza comunei Vinţu de Jos, au oprit, pentru control, un autoturism condus de un bărbat de 36 de ani, din Cugir. În urma testării conducătorului auto cu aparatul […]

Barbat, trimis in judecata, pentru ca ar fi vrut sa mituiasca un agent examinator
www.ziuaconstanta.ro - Constanţa
Ofiterii Directiei Generale Anticoruptie Serviciul Judetean Anticoruptie Galati au finalizat cercetarile iar procurorul din cadrul Parchetului de pe langa Tribunalul Galati a intocmit rechizitoriul ...

Stafeta a veteranilor pentru a marca Centenarul Marii Uniri si Ziua Armatei Romane, la Timisoara
www.tion.ro - Timiş
Eveniment inedit organizat de cei de la Brigada 18 Cercetare Supraveghere „Decebal” din Timişoara, pentru a marca Centenarul Marii Uniri şi Ziua Armatei Române. Peste 200 de maratonişti şi biciclişti vor participa la Ștafeta Veteranilor, de la Timişoara la Carei, în perioada 10-25 octombrie.

Ancheta la Spitalul din Campina dupa ce un bebelus nascut prematur a fost incinerat inainte de necropsie
ph-online.ro - Prahova
O tânără în vârstă de 20 de ani, din comuna Brebu, s-a prezentat săptămâna trecută la Spitalul Municipal Câmpina pentru că avea dureri abdom...

Cornel Ionică, maestru de ceremonii la Toamna Piteşteană
ziarulargesul.ro - Argeş
Astăzi, în Piaţa Vasile Milea, s-a dat startul unei noi ediţii a târgului de produse tradiţionale "Toamna Piteşteană". La ora 10 mai toţi producătorii aveau deja pregătite grătarele cu fripturi, mici şi pastramă. În acelaşi timp şi "făurătorii" de licori la butoi au dat cep şi au început...

„Cântec Vechi” cu violoncel, pian şi literatură de calitate, la Teatru 74
www.zi-de-zi.ro - Mureş
Proiectul „100 de ani în 100 de concerte”, ajuns în cea de-a doua săptămână de derulare, este organi

BĂTĂLIA pentru ȘEFIA DNA. Adina Florea: „Protocoalele adaugă la lege”
evz.ro - Bucureşti
Șefia DNA se discută, luni, în cadrul Secţiei pentru procurori a Consiliului Superior al Magistraturii. Procurorul Adina Florea, propunerea ministrului Just...

CTP taie în carne vie. Explicaţia jurnalistului pentru eşecul referendumului
evz.ro - Bucureşti
Eşecul referendumului pentru familie a stârnit multe reacţii în media.
...

Peste 500 de poliţişti, jandarmi şi pompieri au asigurat siguranţa publică la referendumul din 6 şi 7 octombrie
ziarharghita.ro - Harghita
Structurile teritoriale din cadrul M.A.I. au fost angrenate în organizarea şi desfăşurarea Referendumului din 6 şi 7 octombrie 2018 pentru asigurarea unui

Maxim Iacob, vicecampion naţional la badminton (U9)
feedproxy.google.com - Braşov
Maxim Iacob, de la secţia de badminton a ACS Transilvania, este vicecampion naţional la categoria de vârstă U9, după o finală spectaculoasă în cadrul Campionatului Naţional pentru U9 şi U17, care s-a desfăşurat în weekend la Târgu Mureş. De asemenea, colegul său mai mic, David Fitcu, în vârstă de doar 7 ani, a avut o

Masina data in urmarire de autoturitatile din Marea Britanie confiscata de politistii de frontiera timiseni
www.tion.ro - Timiş
Pagubă mare pentru un timişean, în weekend, în Vama Jimbolia. Bărbatul a rămas fără maşină, după ce poliţiştii de frontieră au confiscat-o pentru că era dată un urmărire de autorităţile engleze.

Liviu Dragnea renunta la sefia Camerei Deputatilor pentru o zi. Pe cine a delegat acesta
www.ziuaconstanta.ro - Constanţa
Liviu Dragnea si-a delegat atributiile de sef al Camerei Deputatilor lui Florin Iordache. ...

Scandal IMENS: Merkel încearcă să trimită în Italia 40.000 de migranţi. Salvini: Închid aeroporturile!
evz.ro - Bucureşti
Berlinul vrea să scape de 40.000 de migranţi expediindu-i în Italia cu zboruri charter, dar Salvini rămâne pe poziţie şi se face zid: Nu autorizez nicio ate...

Protest cu peste 100 de oameni la Spitalul Orăşenesc Câmpeni după ce un medic tânăr vrea să plece, nemulţumit că s-a schimbat conducerea
ziarulunirea.ro - Alba
Peste 100 de persoane au participat, luni, la un protest, în faţa Spitalului Orăşenesc Câmpeni, după ce medicul internist Ciprian Budae a anunţat că va pleca din unitate, nemulţumit de schimbarea conducerii. Manager la spital a fost ec. Morcan Dragomir, iar locul său a fost luat de către dr. Daniel Șenilă. La protest au participat, […]

FOTO. Percheziţii de amploare la traficanţii din Cluj. Afaceri cu droguri în oraşul studenţilor
portalsm.ro - Satu Mare
Percheziţii de amploare la traficanţii din Cluj. Afaceri cu droguri în oraşul studenţilor

Al cincilea deces în Bihor după infecţia cu virusul West Nile: un pacient din Diosig aflat în Spitalul Municipal
www.ebihoreanul.ro - Bihor
Un pensionar din comuna Diosig a devenit a cincea victimă a infecţiei cu virusul West Nile înregistrată anul acesta în Bihor. Bărbatul a decedat vineri, în secţia de Infecţioase a Spitalului Municipal Dr. Gavril Curteanu din Oradea. Autorităţile spun că în judeţ mai sunt încă şapte cazuri de îmbolnăvire confirmate.

Stefan Firu va fi înmormântat marţi la Sibiu
presasibiu.oradesibiu.ro - Sibiu
Ștefan Firu, fostul inspector şef al Inspectoratului Școlar Judeţean, va fi înmormântat marţi. Trupul său este depus la capela Bisericii din Groapă, de pe strada Justiţiei. Slujba de înmormântare este…

Gemene născute prematur, preluate de două elicoptere SMURD
www.gorjeanul.ro - Gorj
Două fetiţe nou-născute prematur la spitalul din Târgu-Jiu vor fi transportate la Timişoara, cu două elicoptere SMURD, unul de la Craiova şi celălalt de la Arad. Gemenele suferă de insuficienţă respiratorie şi nu au putut fi transportate cu acelaşi elicopter, pentru că nu aveau loc în

Avansul Simonei Halep in fruntea clasamentului WTA, redus la 1.000 de puncte
www.ziuaconstanta.ro - Constanţa
Avansul romancei Simona Halep in fruntea clasamentului mondial al jucatoarelor profesioniste de tenis WTA dat publicitatii luni s-a redus la circa 1.000 de puncte, dupa ce daneza Carolina Wozniacki a ...

12 ambasadori europeni, in vizita la Muzeul Ceasului. CJ Prahova, gazda intalnirii
ph-online.ro - Prahova
O delegatie a Comisiei Europene se afla, zilele acestea, la Ploiesti, unde vor vizita Muzeul Ceasului, in cadrul unui proiect finantat din fonduri eur...

Irakieni solicitanti de azil prinsi in timp ce incercau sa treaca ilegal din Romania in Serbia
www.tion.ro - Timiş
Planuri date peste cap de poliţiştii de frontieră pentru nouă irakieni, adulţi şi copii, care voiau să treacă ilegal din Romania în Serbia pentru a ajunge în Italia. Ei au fost prinşi de oamenii legii în zona localităţii Moraviţa, în timp ce se îndreptau, pe câmp, spre graniţa cu ţara vecină.

Referendumul pentru familie: comunele din Mureş cu cea mai bună prezenţă la vot
www.zi-de-zi.ro - Mureş
Potrivit informaţiilor furnizate de Biroul Electoral Central, la nivelul judeţului Mureş au particip

NEMȚII au făcut PUBLIC documentul care DINAMITEAZĂ CARIERA lui RONALDO. Acuzaţiile de viol au fost CONFIRMATE. Breaking news. Foto în articol
evz.ro - Bucureşti
Au apărut noi detalii cu privire la scandalul în care Cristiano Ronaldo este acuzat de viol. Revista de Der Spiegel, care a dezvăluit în exclusivitate relaţ...

O nouă lovitură de la ANAF! Se pregăteşte încă o taxă
evz.ro - Bucureşti
Ministrul Muncii, Lia Olguţa Vasilescu, a anunţat în luna septembrie că va majora pensiile şi salariile. În acelaşi timp, Lia Olguţa spunea la sfârşitul lun...

Maxim Iacob, vicecampion naţional la badminton (U9)
feedproxy.google.com - Braşov
Maxim Iacob, de la secţia de badminton a ACS Transilvania, este vicecampion naţional la categoria de vârstă U9, după o finală spectaculoasă în cadrul Campionatului Naţional pentru U9 şi U17, care s-a desfăşurat în weekend la Târgu Mureş. De asemenea, colegul său mai mic, David Fitcu, în vârstă de doar 7 ani, a avut o

Dosar penal pentru doi minori care au furat doua biciclete
www.infobraila.ro - Brăila
Comentarii comentariu

Tortionarul Alexandru Visinescu operat la Spitalul ''Bagdasar Arseni''
www.ziuaconstanta.ro - Constanţa
Alexandru Visinescu, fostul comandant al Penitenciarului Ramnicu Sarat, a fost operat de splenectomie la Spitalul Bagdasar Arseni in prezent aflandu-se la Terapie Intensiva, constient si stabil, au ...

Rezultate finale referendum Satu Mare: DA – 92,3%, NU – 6,3%
portalsm.ro - Satu Mare
Rezultate finale referendum Satu Mare: DA - 92,3%, NU - 6,3%

Trafic restricţionat pe Autostrada A1. Lucrări de reparaţii
ziarulunirea.ro - Alba
Trafic restricţionat pe Autostrada A1. Lucrări de reparaţii Centrul INFOTRAFIC din Inspectoratul General al Poliţiei Române informează că pe Autostrada A1 Sibiu – Deva, circulaţia rutieră este restricţionată astăzi pe unele tronsoane din cauza lucrărilor de reparaţii, asfaltare şi trasare a marcajelor rutiere astfel: – pe sensul Sebeş către Sibiu, între kilometrii 273 şi 272, pe […]

VEȘTI BUNE pentru elevii arădeni! Ce se întâmplă în şcoli
newsar.ro - Arad
Citeşte azi ce scriu ziarele de mâine!

Capitala va fi blocată timp de două zile. Vezi din ce cauză!
evz.ro - Bucureşti
Traficul rutier va fi restricţionat, în Capitală, în perioada 13-14 octombrie, pe perioada derulării celei de-a 11-a ediţii a Raiffeisen Bank Maratonul...

Donează sânge în cadrul Medifun! „Cea mai sângeroasă echipă” va fi răsplătită
www.zi-de-zi.ro - Mureş
Cu speranţa că va fi conturată o nouă tradiţie a Medifun-ului, organizatorii continuă proiectul „Cea

Politistii au depistat in trafic un mopedist fara permis de conducere. Ce masuri s-au luat
www.ziuaconstanta.ro - Constanţa
La data de 07 octombrie a.c., in jurul orei 09.10, politisti din cadrul Sectiei 3 Politie Rurala Liesti au oprit in trafic, pe D.N. 25, in comuna Ivesti, un barbat din localitate care circula cu un ...

Dosar penal pentru un albaiulian care a condus în oraş după ce a băut toată ziua
ziarulunirea.ro - Alba
La data de 7 octombrie 2018, în jurul orei 18.30, poliţiştii rutieri din Alba Iulia l-au depistat pe un bărbat de 53 de ani, din Alba Iulia, în timp ce conducea un autoturism, pe B-dul Încoronării din municipiu, fiind sub influenţa băuturilor alcoolice. În urma testării conducătorului auto cu aparatul etilotest, a rezultat valoarea de […]

Acţiune de salvare la Fundăţica. Un bărbat este prins sub o remorcă
feedproxy.google.com - Braşov
Inspectoratul pentru Situaţii de Urgenţă (ISU) Braşov a fost alertat pentru a acorda ajutorul unui bărbat care a fost prins sub o remorcă plină cu lemne în Fundăţica. „Se deplasează la faa locului o autospeciala de stins incendii cu apă şi spumă cu modul de descarcerare de la punctul de lucru Moieciu şi un echipaj

Tineri retinuti dupa ce au fost prinsi ca au spart doua autoturisme pentru a fura, la Timisoara
www.tion.ro - Timiş
Acuzaţii de furt calificat pentru doi tineri de 17 şi 18 ani, la Timişoara. Ei sunt cercetaţi penal, după ce au fost prinşi că au spart două autoturisme şi au sustras mai multe bunuri.

Gemene născute prematur, preluat de două elicoptere SMURD
www.gorjeanul.ro - Gorj
Două fetiţe nou-născute prematur la spitalul din Târgu-Jiu vor fi transportate la Timişoara, cu două elicoptere SMURD, unul de la Craiova şi celălalt de la Arad. Gemenele suferă de insuficienţă respiratorie şi nu au putut fi transportate cu acelaşi elicopter, pentru că nu aveau loc în

„Focus on 3D Printing –New techs learning activities in libraries” la Biblioteca Judeteana Braila
www.infobraila.ro - Brăila
Comentarii comentariu

VARZĂ, CARTOFI ŞI ALŢI DEMONI
ziarharghita.ro - Harghita
15 octombrie 2018, luni, de la ora 20.00, la Centrul Cultural Judeţean Harghita se prezintă VARZĂ, CARTOFI ŞI ALŢI DEMONI. SYNOPSIS: Un sat, 1.000 de

CLUJ: Percheziţii de amploare la traficanţi de droguri. Șase persoane au fost arestate FOTO
www.stiridecluj.ro - Cluj
Poliţiştii clujeni au efectuat, alături de procurorii D.I.I.C.O.T., 14 percheziţii, &a...

Report loto 6/49. Castiguri de peste un milion de euro
www.ziuaconstanta.ro - Constanţa
Joi, 11 octombrie, au loc noi trageri Loto 6 49, Noroc, Joker, Noroc Plus, Loto 5 40 si Super Noroc, dupa ce la tragerile loto de duminica, 7 octombrie, Loteria Romana a acordat 18.054 de castiguri in valoare ...

Accident la Cugir: Un şofer beat s-a izbit de maşina care circula în faţa sa
ziarulunirea.ro - Alba
La data de 7 octombrie 2018, în jurul orei 18.30, poliţiştii din Cugir, au intervenit pentru soluţionarea unui accident rutier, produs pe strada Victoriei din Cugir. Un bărbat de 34 de ani, din Cugir, în timp ce conducea un autoturism, nu a păstrat distanţa de siguranţă faţă de autoturismul ce circula în faţa sa, intrând […]

Percheziţii DIICOT, inclusiv în Oradea: Captură importantă de droguri (FOTO)
www.ebihoreanul.ro - Bihor
Procurorii Direcţiei de Investigare a Infracţiunilor de Criminalitate Organizată şi Terorism – Serviciul Teritorial Cluj au făcut, vineri, percheziţii, inclusiv în Oradea, într-un dosar complex, în care au fost capturate importante cantităţi de droguri. Şase persoane au fost arestate.

PROGNOZA METEO PE TREI ZILE. Vreme neobişnuit de caldă, octombrie arată ca o lună de vară
ph-online.ro - Prahova
Vremea frumoasă se va menţine şi în prima jumătate a săptămânii următoare. În continuare vom avea maxime de 25 de grade Celsius, chiar cu 26 de grade...

Acţiune puternică a poliţiştilor din Alba: Peste 500 de amenzi aplicate şoferilor, bicicliştilor şi pietonilor. 15 permise, reţinute
ziarulunirea.ro - Alba
Poliţiştii din judeţul Alba au aplicat peste 500 de sancţiuni contravenţionale şi au reţinut 15 permise de conducere, în cadrul unei acţiuni ce a vizat creşterea gradului de siguranţă rutieră pe drumurile publice şi care s-a desfăşurat pe parcursul săptămânii precedente. În perioada 01-04 octombrie 2018, Serviciul Rutier Alba a organizat, pe raza întregului judeţ, […]

Presa din Costa Rica, noi dezvăluiri despre Udrea şi Bica. Legături cu traficanţii de droguri din Columbia
ph-online.ro - Prahova
Presa din Costa Rica este foarte interesată de Elena Udrea şi Alina Bica, iar jurnaliştii vorbesc despre o adevărată reţea internaţională care le-ar f...

IMPORTANT! Toate pensiile vor fi virate pe card, din 2019
ph-online.ro - Prahova
Toate pensiile vor fi virate pe card de anul viitor. Ministrul Finanţelor Eugen Teodorovici vrea ca statul să nu mai cheltuiască 600 milioane lei pe...

Colocviile ”George Coşbuc”, în 12-14 octombrie la Bistriţa, Năsăud şi Coşbuc
www.timponline.ro - Bistriţa-Năsăud
Casa de Cultură a Sindicatelor Bistriţa organizează în perioada 12-14 octombrie a XXXIV-a ediţie a Colocviilor ”George Coşbuc” - Festival naţional de poezie. Manifestările culturale au loc la Bistriţa, Năsăud şi în comuna Coşbuc.

Un adolescent şi un tânăr din Aiud, reţinuţi după ce au furat banii lăsaţi într-o maşină
ziarulunirea.ro - Alba
Poliţiştii din Aiud au reţinut doi tineri care au profitat de neatenţia unui cetăţean şi i-au sustras banii lăsaţi în maşină. Prejudiciul a fost recuperat integral, iar cei doi tineri vor fi cercetaţi sub control judiciar. La data de 06.10.2018, poliţiştii de investigaţii criminale din cadrul Poliţiei Municipiului Aiud au luat măsura reţinerii, pentru o […]

Jurnalistul şi scriitorul Tiberiu Cosovan a plecat să scrie şi să picteze în Ceruri
feeds.monitorulsv.ro - Suceava
Ultima ora: Cel mai indragit coleg al nostru, Tiberiu Cosovan - Coso, asa cum ii spuneam toti, decanului de varsta din redactia Monitorul, a plecat dintre noi.

Un cadru didactic-cercetător senegalez va susţine o conferinţă la Biroul Francez
feeds.monitorulsv.ro - Suceava
Ultima ora: Miercuri, 10 octombrie 2018, de la ora 18, Biroul Francez invita francofilii suceveni sa participe la conferinta Milieu multilingue, apprenants plurilingues et enseignement monolangue: quel médium pour linstruction à Ziguinchor Sénégal, sustinuta de Ndjémé Sow, sociolingvist, cadru didactic-cercetator al Universitatii Assane Seck din Ziguinchor, facultatea UFR Litere, Arte si.

Adina Florea consideră că DNA nu ar trebui să investigheze abuzul în serviciu
ph-online.ro - Prahova
Adina Florea, procurorul propus de Tudorel Toader la conducerea DNA susţine că din statisticile pe care le-a consultat a observat că DNA s-a axat pe a...

Atmosfera senzationala pe Hipodromul Ploiesti. 3000 de spectatori au fost prezenti la derby-ul de trap al Romaniei
ph-online.ro - Prahova
Duminică 7 octombrie s-a dovedit ziua cea mai lungă, dar şi cea mai spectaculoasă, din anul acesta, la Hipodromul Ploieşti. Ziua în care s-a decis câş...

UPDATE: Pagube de 15.000 de lei în urma unui incendiu la o cabană din comuna Horea în care se aflau 15 persoane. Cauza probabilă, un scurtcircuit electric produs la un conductor electric defect
ziarulunirea.ro - Alba
Un incendiu la o cabană din satul Baba, comuna Horea, a izbucnit, în noaptea de duminică spre luni, pompierii fiind chemaţi să intervină. Potrivit ISU Alba, staţia Câmpeni a intervenit cu trei autospeciale şi o autospecială SMURD pentru stingerea flăcărilor. Cabana în care a izbucnit incendiul se află în satul Baba din comuna Horea. Nu […]

Percheziţii DIICOT, inclusiv în Oradea: Captură importată de droguri (FOTO)
www.ebihoreanul.ro - Bihor
Procurorii Direcţiei de Investigare a Infracţiunilor de Criminalitate Organizată şi Terorism – Serviciul Teritorial Cluj au făcut, vineri, percheziţii, inclusiv în Oradea, într-un dosar complex, în care au fost capturate importante cantităţi de droguri. Şase persoane au fost arestate.

UPDATE: Pagube de 10.000 de lei în urma unui incendiu la o cabană din comuna Horea în care se aflau 15 persoane. Cauza probabilă, un coş de fum neprotejat
ziarulunirea.ro - Alba
Un incendiu la o cabană din satul Baba, comuna Horea, a izbucnit, în noaptea de duminică spre luni, pompierii fiind chemaţi să intervină. Potrivit ISU Alba, staţia Câmpeni a intervenit cu trei autospeciale şi o autospecială SMURD pentru stingerea flăcărilor. Cabana în care a izbucnit incendiul se află în satul Baba din comuna Horea. Nu […]

Cine este noul adjunct al IJP Prahova
ph-online.ro - Prahova
Florin Aristan va fi avansat în funcţia de adjunct al şefului Poliţiei Prahova. Acesta este în prezent şeful Serviciului Rutier DN 1. Aris...

FLOREA loveşte în INSTITUȚIA pe care vrea să o CONDUCĂ. Greşelile lui KOVESI, puse sub LUPĂ. „Procurorii nu TREBUIE transformaţi în VEDETE”
evz.ro - Bucureşti
Luni, Adina Florea, propunerea ministrului Justiţiei pentru funcţia de şef al DNA, a criticat fosta conducere a Direcţiei Naţionale Anticorupţie, menţionând...

SCANDAL la Interpol. Şeful dimisonar al organizaţiei internaţionale, cercetat pentru acceptare de mită de către autorităţile chineze
evz.ro - Bucureşti
Meng Hongmei, şeful demisionar al Interpol, viceministru chinez al Securităţii Publice, este anchetat pentru corupţie în China, împotriva lui fiind lansate ...

ȘOC la ANTENA. Un mare PREZENTATOR a vrut să se SINUCIDĂ după ce a fost ABUZAT. Cum a scăpat din ghearele MORȚII
evz.ro - Bucureşti
Răzvan Botezatu, un prezentator cunoscut de la Antena Stars, a vrut să se sinucidă. Acesta a povestit momentele negre prin care a trecut....

Saptamana trecuta in imagini
www.tion.ro - Timiş
Cele mai importante evenimente care au avut loc în săptămâna ce a trecut în Timişoara şi judeţul Timiş au fost surprinse de fotografii www.tion.ro.

Accident rutier pe DN 7. O autoutilitara s-a rasturnat.Traficul este restrictionat
www.ziuaconstanta.ro - Constanţa
Centrul INFOTRAFIC din Inspectoratul General al Politiei Romane informeaza ca circulatia rutiera este restrictionata pe DN 7 Pitesti Ramnicu Valcea, la kilometrul 154 200 metri, pe raza localitatii ...

Perchezitii ale procurorilor DIICOT. Ce au descoperit la locuintele suspectilor
www.ziuaconstanta.ro - Constanţa
La data de 6 octombrie a.c., politistii specializati in combaterea criminalitatii organizate si procurorii D.I.I.C.O.T. din Cluj au efectuat 14 perchezitii la locuintele mai multor persoane, din ...

Expoziţii la Palatul Culturii şi la Fundaţia Culturală Bernády György în cadrul Nopţii Albe a Galeriilor
www.zi-de-zi.ro - Mureş
Noaptea Albă a Galeriilor a propus din nou târgumureşenilor o întâlnire, după lăsarea întunericului,

MODERNIZARE TEHNOLOGICĂ PRIN DOTARE CU ECHIPAMENTE MEDICALE LA SC DUO STIL SRL
feeds.monitorulsv.ro - Suceava
SC DUO STIL SRL, cu sediul in municipiul Suceava, Str. Mihai Viteazul, nr. 54, Bl. 54, Ap.

„Dezvoltarea capacităţii de producţie a societăţii CONELTEX S.R.L.” Cod SMIS 110419
feeds.monitorulsv.ro - Suceava
SC CONELTEX SRLanuntalansarea proiectului Dezvoltarea capacitatii de productie a societatii CONELTEX S.R.L., cod SMIS 110419. Proiectul este cofinantat din Programul Operational Regional 2014-2020, Axa prioritara 2 - Imbunatatirea competitivitatii intreprinderilor mici si mijlocii, Prioritatea de investitii 2.2 - Sprijinirea crearii si extinderea capacitatilor avansate de productie si dezvoltarea serviciilor.

INVESTIM PENTRU CREȘTEREA VALORII ADĂUGATE
feeds.monitorulsv.ro - Suceava
Societatea FORESTFALT SERVICII SRL, cu sediul in Municipiul Falticeni, strada Armatei nr.5C, Judetul Suceava, specializata in prelucrarea lemnului, deruleaza incepand cu data de 12.09.

Târgul de toamnă pentru copii, la ediţia a V-a
feeds.monitorulsv.ro - Suceava
Sub razele unui soare darnic, centrul municipiului Radauti a gazduit, ieri dupa-amiaza, Targul de toamna pentru copii, o actiune care a atras cateva sute de localnici, copii, parinti si radauteni de toate varstele. Mai precis, in vecinatatea fantanii arteziene din centrul localitatii au fost amenajate 15 standuri unde prescolarii si elevii de la Scoala Gimnaziala nr.

Primul Cetăţean de Onoare din istoria localităţii poloneze Mucharz este primarul din ...
feeds.monitorulsv.ro - Suceava
Primarul comunei Manastirea Humorului, Constantin Moldovan, este prima persoana careia i s-a acordat vreodata titlul de Cetatean de Onoare al localitatii poloneze Mucharz. Evenimentul a avut loc sambata, 6 octombrie a.c., la Manastirea Humorului, in cadrul unei sedinte de consiliu local de indata.

Părintele Dumitru Stăniloae, o viaţă ca o rugăciune
feeds.monitorulsv.ro - Suceava
Parintele Staniloae a plecat lasandu-ne mostenire o teologie a luminii si a iubirii intru bucuria de a avea constiinta ca Dumnezeu este cu noi in masura in care ne daruim Lui, facandu-ne fii ai Lui.

Fericiţi veţi fi când vă vor prigoni!
feeds.monitorulsv.ro - Suceava
In vremea aceea au stat in loc ses Iisus, multime multa de ucenici ai Sai si multime mare de popor din toata Iudeea, din Ierusalim si de pe tarmul Tirului si al Sidonului, care venisera sa-L asculte si sa se vindece de bolile lor. Si cei chinuiti de duhuri necurate se vindecau. Si toata multimea cauta sa se atinga de El, ca putere iesea din El si-i vindeca pe toti.

Judeţul Suceava a fost, de la ora 16.00, pe primul loc la prezenţa la votul pentru referendum
feeds.monitorulsv.ro - Suceava
Datele comunicate, ieri, de Biroul Electoral Central referitoare la prezenta la vot la referendumul national de modificare a Constitutiei situau judetul Suceava in top la nivel national.La raportarea de la ora 16.00, judetul Suceava a ajuns pe primul loc in tara, cu un procent de 23,08, mult peste media nationala, care a fost de 15,21, mentinandu-se pe acest loc si la raportarea de la ora 19,00, cu 28,79.

Preşedintele unei secţii de votare din judeţ s-a retras cu două ore înainte de încheierea ...
feeds.monitorulsv.ro - Suceava
Presedintele sectiei de votare din localitatea Cotargasi - Brosteni s-a retras cu doua ore inainte de incheierea votului dupa ce primit vestea ca mama lui a murit pe neasteptate. Presedintele a comunicat Biroului Electoral Judetean ca nu este in stare sa-si continue activitatea nici macar pana la ora 21,00, la inchiderea urnelor.

Iancu Flondor, liderul unionist din Bucovina, pe o marcă poştală din emisiunea „Făuritori ...
feeds.monitorulsv.ro - Suceava
Romfilatelia a introdus in circulatie, incepand cu data de 17 septembrie a.c., emisiunea de marci postale Fauritori ai Marii Uniri partea a II-a, serie care reproduce portretele unor patrioti care s-au luptat pentru indeplinirea acestui ideal national si care include o marca postala dedicata lui Iancu Flondor, artizanul Unirii Bucovinei cu Romania.

187 de opţionale pentru folclor în şcolile din judeţ, în urma Proiectului „10 pentru ...
feeds.monitorulsv.ro - Suceava
187 de optionale pentru folclor, in 124 de scoli gimnaziale, liceale, palate si cluburi ale copiilor si in 21 de gradinite din judet, este rezultatul Proiectului 10 pentru folclor, editia a III-a.

O pictură semnată de Bansky s-a autodistrus imediat ce a fost vândută cu 1 milion de lire ...
feeds.monitorulsv.ro - Suceava
Un tablou realizat de Bansky, un cunoscut artist stradal, s-a autodistrus pe podiumul casei de licitatie Sotheby's din Londra, vineri seara, imediat dupa ce a fost vanduta pentru peste 1 milion de lire sterline, transmite Mediafax. Licitatia pentru pictura denumita Fata cu balon a inceput de la 200.000 - 300.

Inimă răcită prea devreme...
feeds.monitorulsv.ro - Suceava
In aceasta aspra uvertura de Brumarel, a plecat dintre noi VIRUTA - Elvira CORJIN, 59 de ani n. 1959, 40 de ani neintrerupt educatoare in Voievodeasa - Sucevitei, localitatea de bastina. Nu exista casa, in micul si legendarul catun, in care, intr-un fel sau altul, copii, nepoti, parinti sa nu-i fi trecut prin manutele ei doua, gingase si tandre, de Dascalita dedicata.

Dr. Gabriela Creţeanu: „Dacă diabetul ar fi o ţară, ar fi a patra cea mai mare din lume, ...
feeds.monitorulsv.ro - Suceava
Numarul persoanelor care sufera de diabet este in continua crestere, la nivel national fiind aproape doua milioane de persoane cu varste cuprinse intre 20 si 79 de ani. Din pacate, o buna parte dintre acestea ajung sa sufere amputatii ale picioarelor, din cauza complicatiilor acestei boli. Dr.

Fălticenenii au câştigat o repriză în faţa liderului, dar n-a fost de ajuns
feeds.monitorulsv.ro - Suceava
Vizita liderului Suporter Club Otelul Galati la Falticeni nu s-a terminat bine pentru echipa locala Somuz, oaspetii impunandu-se la final cu scorul de 5-1. Partida a avut insa doua parti distincte.

Victorie pentru CSM Bucovina la Arad
feeds.monitorulsv.ro - Suceava
CSM Bucovina Suceava a obtinut ieri a doua victorie in deplasare in acest sezon al Diviziei Nationale, dupa ce s-a impus cu scorul de 30-18 pe terenul formatiei CSUAV Arad. Am inceput meciul cu unele ezitari, astfel ca s-a ajuns ca in minutul 15 gazdele sa conduca cu 8-0. Din acel moment insa am pus stapanire pe joc.

Primul meci acasă s-a soldat cu o victorie categorică pentru RC Gura Humorului
feeds.monitorulsv.ro - Suceava
Ieri, in primul lor joc pe teren propriu din Divizia Nationala, rugbistii de la RC Gura Humorului au dispus fara probleme, cu 66-12, de codasa CSM Sibiu. Nu mai putin de 10 eseuri au marcat in acest joc sportivii de la echipa condusa de Andrei Varvaroi, Stefanita Rusu si Mihai Coca. Dupa cum o arata si scorul, a fost un meci controlat de echipa noastra.

Foresta câştigă la pas confruntarea cu Metalul Buzău
feeds.monitorulsv.ro - Suceava
Foresta a facut uitat esecul usturator de la ultimul meci din deplasare, cu KSE Targu Secuiesc, cu un succes concludent, sambata dupa-amiaza, pe Areni. Sucevenii au dispus cu 4-0 de Metalul Buzau, la capatul unui joc pe care l-au dominat de la primul fluier al arbitrului.

Mai mult sau mai puţin regretabil
feeds.monitorulsv.ro - Suceava
De departe, cel mai derutant rezultat al etapei, si asta fara a le cunoaste pe cele de duminica, este infrangerea lui Bayern Muenchen cu 3-0 in propriul fief! Orice echipa din Bundesliga ar fi izbutit asta era de mirare, cu atat mai mult cand e vorba de Borussia Moenchengladbach, o trupa care sezonul trecut impartea clasamentul in doua.

Wozniacki câştigă turneul de la Beijing şi micşorează avansul lui Halep în clasamentul WTA
feeds.monitorulsv.ro - Suceava
Caroline Wozniacki a castigat turneul Premier Mandatory de la Beijing, dupa ce a trecut cu dublu 6-3 de letona Anastasija Sevastova, intr-o ora si 27 minute, informeaza Mediafax. Cu 3 titluri in 2018, Caroline Wozniacki ajunge la mai putin de 1000 puncte in urma Simonei Halep. De luni, Simona Halep va avea 7421 puncte si un avans de 931 puncte in fata danezei de pe locul doi, 6490 puncte.

Bucovina câştigă şi se menţine în plutonul fruntaş
feeds.monitorulsv.ro - Suceava
Bucovina Radauti a ajuns la al cincilea succes stagional in urma victoriei cu 2-0 inregistrata in fata gruparii CSM Pascani, in cadrul etapei a VII-a a Ligii a III-a. Trupa pregatita de Dorin Goian si Daniel Balan pornea ca mare favorita in acest joc si nici macar eliminarea atacantului Iulian Ionesi, din minutul 5, nu a pus sub semnul intrebarii problema invingatoarei.

ASA Rarău Câmpulung Moldovenesc a făcut scorul etapei
feeds.monitorulsv.ro - Suceava
Somuzul Preutesti continua forma buna aratata in acest debut de sezon. In runda a VI-a a Ligii a IV-a, formatia lui Catalin Vasiliu s-a intors cu toate cele trei puncte dintr-o deplasare grea, la Suceava, impotriva Juniorului, mentinandu-se in fotoliul de lider. Semne de revenire pare sa dea si Viitorul Liteni.

Dosar ignorat total de procurori, timp de doi ani, în cazul falşilor denunţători împotriva ...
feeds.monitorulsv.ro - Suceava
Reversul medaliei asteptat de politistii care au fost tarati timp de doi ani intr-o ancheta care le-a pus la grea incercare carierile si le-a mancat sanatatea intarzie sa apara.

Primele condamnări ale complicilor în afaceri cu droguri ai individului care a lovit un ...
feeds.monitorulsv.ro - Suceava
Magistratii de la Tribunalul Suceava au dat o prima solutie in marele dosar de trafic de droguri cu inculpati din zona Radauti, in cazul gruparii coordonate de Razvan Percec si Alexandru Hutuleac, ultimul fiind cel care l-a lovit cu o sabie in cap pe politistul Dan Ciprian Sfichi, in timpul unei perchezitii de la inceputul lunii decembrie a anului trecut.

8 octombrie
feeds.monitorulsv.ro - Suceava
Lectii de aparare pasiva In urma ordinelor superioare si ordonantei Primariei, toti locuitorii orasului sunt obligati sa asculte cel putin 24 de ore lectiile de aparare pasiva care vor fi predate de persoane brevetate in acest scop.

Autoturism de peste 60.000 de euro, căutat de autorităţile din Polonia, descoperit în PTF Siret
feeds.monitorulsv.ro - Suceava
O masina de lux, un Audi Q7, care fusese dat in urmarire la nivel european, a fost descoperit de echipa de control din Punctul de Trecere a Frontierei PTF Siret.

Poliţiştii au ridicat 370 de kilograme de ciuperci de la comercianţi veniţi de la Sălaj la ...
feeds.monitorulsv.ro - Suceava
Politistii de la Vama au confiscat, sambata, 370 de kilograme de ciuperci de la un grup de persoane de etnie roma din judetul Salaj, care comercializau marfa acte de provenienta.

Doi tineri şoferi au provocat accidente cu opt răniţi din cauza vitezei
feeds.monitorulsv.ro - Suceava
Doi tineri soferi, unul in varsta de 23 de ani si unul de 22 de ani, au provocat accidente rutiere la finele saptamanii trecute, din cauza vitezei. Ambele accidente s-au petrecut la Vicovu de Sus si s-au soldat cu cate patru raniti. Primul eveniment rutier a avut loc vineri noapte, in jur de ora 22.00, la intersectia dintre Calea Bucovinei si Calea Cernauti. Din cercetarile politiei rezulta ca Daniel P.

Șofer băut urmărit în trafic, după ce a refuzat să oprească la semnalul poliţiştilor
feeds.monitorulsv.ro - Suceava
Un tanar de 28 de ani s-a ales cu un dosar penal, dupa ce, fiind la volan sub influenta bauturilor alcoolice, nu a oprit nici la semnalul regulamentar al politistilor. Incidentul s-a petrecut sambata seara, in jurul orei 23.40, in timp ce un echipaj din cadrul Serviciului Rutier Suceava actiona pe DN 17, in comuna Scheia.

Înşelăciuni pe bandă rulantă cu bancnote de tip ”suvenir”, fabricate în Ucraina
feeds.monitorulsv.ro - Suceava
Sesizarile privind inselaciuni cu bancnote euro de tip suvenir, de provenienta ucraineana, s-au inmultit in ultimele saptamani in judetul Suceava.

Șoferi băuţi zdravăn, prinşi de poliţişti în timpul controalelor din weekend
feeds.monitorulsv.ro - Suceava
Consumul de alcool la volan reprezinta una dintre principalele cauze de producere a accidentelor. In scopul prevenirii acestei infractiuni, mai des intalnita la final de saptamana, politistii au desfasurat controale in intreg judetul si la finalul saptamanii trecute, fiind depistate cateva cazuri in care soferii s-au urcat la volan cu alcoolemii mari. Astfel, sambata dupa-amiaza, in jurul orei 15.

Flutur a pus bazele unor parteneriate în domeniul turistic şi aeroportuar între Suceava şi ...
feeds.monitorulsv.ro - Suceava
Presedintele Consiliului Judetean Suceava, Gheorghe Flutur, a anuntat ca in perioada urmatoare vor fi dezvoltate parteneriate intre judetul Suceava si Austria, in special in domeniul turismului, al mediului de afaceri, dar si pentru dezvoltarea unor curse aeriene catre aceasta tara.

Incendiu de pădure urmat de un accident rutier montan şi o asanare pirotehnică, scenariul ...
feeds.monitorulsv.ro - Suceava
Un amplu exercitiu combinat in domeniul situatiilor de urgenta s-a desfasurat vineri in zona de padure a Ocolului Silvic Pojorata, avand drept temaInterventia Comitetului Judetean pentru Situatii de Urgenta, a Directiei Silvice Suceava si a Comitetului Local pentru Situatii de Urgenta al comunei Pojorata, impreuna cu Inspectoratul pentru Situatii de Urgenta al judetului Suceava si celelalte institutii cu f.

Viceprimarul Sucevei Lucian Harşovschi a votat din Statele Unite ale Americii
feeds.monitorulsv.ro - Suceava
Unul dintre voturile inregistrate de peste hotare, la referendumul de modificare a Constitutiei, in sensul redefinirii familiei, este cel al viceprimarului municipiului Suceava Lucian Harsovschi, care si-a exercitat acest drept tocmai din Atlanta - capitala statului american Georgia. Dreptul la vot este esential si este pacat de cei care au luptat pentru acesta daca noi nu il exercitam.

Un membru al comisiei electorale dintr-o localitate din judeţul Botoşani a leşinat în ...
feeds.monitorulsv.ro - Suceava
Un barbat de 52 de ani, membru al comisiei electorale din Vitcani, comuna Candesti, judetul Botosani, a lesinat in sectia de vot sambata, cu putin inainte de inchiderea urnelor. Conform unor surse din cadrul Prefecturii Botosani, incidentul a avut loc sambata seara, cu putin timp inainte de inchiderea sectiei de vot, astfel ca procesul electoral nu a fost intrerupt.

Proiect de peste un milion de euro pentru reabilitarea şi echiparea Colegiului Tehnic ...
feeds.monitorulsv.ro - Suceava
Unul dintre cele mai cunoscute unitati scolare profesionale din Suceava, Colegiul Tehnic Petru Musat fostul Industrial nr. 2, are mari sanse sa beneficieze de fonduri europene de peste un milion de euro, o contributie financiara importanta urmand sa fie acordata de la bugetul local al municipalitatii.

Primăria Suceava se aliază cu firmele în lupta contra crizei de forţă de muncă calificată
feeds.monitorulsv.ro - Suceava
Una dintre principalele probleme cauzate de migrarea fortei de munca peste hotare este criza fortei de munca calificate, care se resimte tot mai acut, de la un an la altul.

Ministrul Justiţiei acuză folosirea dublei măsuri în cazul Adinei Florea, propusă pentru conducerea DNA
evz.ro - Bucureşti
Ministrul Justiţiei, Tudorel Toader, a spus luni că nu s-a dovedit faptul că Adina Florea, candidată la şefia DNA, ar fi săvârşit vreo abatere disciplinară...

Mesajul Patriarhiei după Referendumul eşuat: îndeamnă la unitate şi apărarea familiei “binecuvântate de Dumnezeu”
evz.ro - Bucureşti
Patriarhia Română îndeamnă la unitate spirituală şi la apărarea în continuare a ...

Zilele aşa-zisului Ținut Seciuesc, prilej ca maghiarii din alte zone să-i înţeleagă pe secuii, când nici secuii între ei nu se înţeleg
ziarharghita.ro - Harghita
Patrimoniul nostru: la confluenţa dintre trecut şi viitor – acesta este motto-ul sub care consiliile judeţene din Harghita, Mureş şi Covasna, împreună cu

Un scriitor din Alba a obţinut premiul pentru romanul anului cu un volum inspirat după tragedia de la Colectiv
ziarulunirea.ro - Alba
Scriitorul cugirean Flaviu Predescu a obţinut sâmbătă premiul pentru romanul anului cu un volum inspirat după tragedia de la Colectiv, pe care l-a intitulat ”Perechea dragoste, perechea moarte”. Premiul a fost acordat de Uniunea Scriitorilor din România, iar juriul a fost condus de Nicolae Manolescu. Romanul a fost publicat de editura RAO. ”Mulţumesc juriului condus […]

Multă agitaţie pentru nimic! Nici urmă de gloanţe în trenul Timişoara-Reşiţa, „împuşcat” în luna august!
expressdebanat.ro - Caraş-Severin
Alarmă falsă! Asta s-a dovedit a fi un incident care a inflamat spiritele în luna august, în zona haltei de la Colţan. Cineva a sunat la 112, după ce un geam al trenului a fost spart, anunţând că s-au tras focuri de armă asupra vagonului de călători. Deşi încă de atunci autorităţile făceau apel la…

Locuri de munca in Ploiesti, Campina si Valeni. Vezi aici lista completa a joburilor disponibile
ph-online.ro - Prahova
În total sunt diponibile prin AJOFM Prahova 1050 de locuri de muncă. Printre angajatori se numără şi Profi, Şcoala gimnazială nr 1 Tele...

Care este reactia Patriarhiei dupa referendum
www.ziuaconstanta.ro - Constanţa
In urma invalidarii referendumului din 6-7 octombrie 2018 pentru redefinirea casatoriei, Patriarhia Romana indeamna la unitate spirituala si la apararea in continuare a familiei binecuvantate de ...

Biserica Ortodoxă şi Biserica Catolică, mesaje după referendum
www.timponline.ro - Bistriţa-Năsăud
În urma invalidării referendumului din 6-7 octombrie pentru redefinirea familiei, Patriarhia Română ”îndeamnă la unitate spirituală şi la apărarea în continuare a familiei binecuvântate de Dumnezeu”, se arată într-un comunicat:
”Cu prilejul referendumului, Biserica Ortodoxă Română a împlinit misi

Referendum 2018: În Teleorman, prezenţa la vot a fost de 22,63%
ziarulteleormanul.ro - Teleorman
Referendumul pentru redefinirea familiei în Constituţie nu a îndeplinit condiţiile de validare, prezenţa la vot, duminică, la ora 21.00, la închiderea urnelor fiind de 20,41%, potrivit rezultatelor prezentate de Biroul Electoral Central (BEC). Pentru a fi validat era nevoie de o prezenţă de cel puţin 30% a românilor înscrişi în listele electorale permanente. În ceea ce priveşte judeţul Teleorman, 22,63 % dintre teleormănenii cu drept de vot s-au prezentat, în cele două zile, la secţiile de votare, potrivit datelor centralizate de Biroul Electoral Central. Au trecut pragul secţiilor de votare 7

Val de indignare în Europa după asasinarea unei jurnaliste din Bulgaria
evz.ro - Bucureşti
Asasinarea jurnalistei bulgare Viktoria Marinova - cel de-al treilea reprezentant al mass-media din Uniunea Europeană asasinat în decurs de un an...

Referendum pentru familie. Reacţia Bisericii Ortodoxe Române după invalidarea referendumului
evz.ro - Bucureşti
În urma invalidării referendumului ce avut loc în perioada 6-7 octombrie 2018 pentru redefinirea căsătoriei, Patriarhia Română a transmis un comunicat prin ...

Momente de panică la Exatlon. Liderul echipei Faimoşilor a avut nevoie de intervenţia Ambulanţei
evz.ro - Bucureşti
Panică în echipa organizatorilor competiţiei Exatlon. Monica Roşu, una dintre concurente, s-a accidentat grav la Exatlon şi a fost nevoie să fie preluată de...

Un profesor de la UPG Ploiesti (50 de ani), medaliat cu aur la Campionatul national de culturism şi Fitness
ph-online.ro - Prahova
Profesorul universitar de la UPG Ploieşti care a ajuns pe coperta revistei Men’s Health, uimeşte din nou. Costin Ilinca,noul campion naţional la fitne...

Referendumul pentru familie: prezenţa la urne în oraşele din Mureş
www.zi-de-zi.ro - Mureş
Potrivit informaţiilor furnizate de Biroul Electoral Central, la nivelul judeţului Mureş au particip

AVERTISMENT de la ANAF: Nu transmite email-uri prin care anunţă CONTROALE FISCALE
newsar.ro - Arad
Citeşte azi ce scriu ziarele de mâine!

Incredibil! Au aparut gropi pe str. Elena Doamna, la nici 2 saptamani de la asfaltare
ph-online.ro - Prahova
Ani de zile, şoferii au făcut slalom printre gropile de pe str. Elena Doamna, una dintre arterele foarte circulate din Ploieşti şi parte a unui traseu...

Caz socant. Baiat de 17 ani a fost gasita spanzurata in casa
www.ziuaconstanta.ro - Constanţa
Un adolescent de 17 ani s-a spanzurat de dorul parintilor lui, plecati la munca in Germania, scrie Observator TV. Incidentul a avut loc intr-o familie din satul Draxini, comuna Baluseni, judetul ...

Accident in Ploiesti, pe strada Deltei. O soferita a ajuns la spital dupa ce a intrat cu masina intr-un autoturism parcat
ph-online.ro - Prahova
Un accident de circulatie s-a produs in jurul orei 6:30 in Ploiesti, la intersectia strazilor Deltei si Sergent Mateescu. O soferita in varsta de 24 d...

Incendiu provocat de o ţigară uitată aprinsă, la o locuinţă din Stejaru
ziarulteleormanul.ro - Teleorman
Pompierii militari au intervenit, în noaptea de sâmbătă spre duminică, pentru stingerea unui incendiu izbucnit la o casă de locuit din Stejaru, după ce proprietarul a adormit, lăsând o ţigară aprinsă. “Din fericire, proprietarul s-a trezit la timp, a observat incendiul care cuprinse o parte din locuinţă, a ieşit repede afară şi a încercat să stingă de unul singur focul”, a precizat mr. Gelu Dragomir, purtătorul de cuvânt al ISU Teleorman. Incendiul a fost sesizat prin apel la numărul unic de urgenă 112, de către un vecin, iar la faţa locului s-au deplasat două echipaje din cadrul D

Plan de ASALT al ANAF! ULTRA-lovitura pe care o pregăteşte: Pe cine vrea să impoziteze
ph-online.ro - Prahova
La sfârşitul lunii septembrie, Ph-online.ro vă dezvăluia că Guvernul începe „Marea Recuperare”. Ulterior, a fost confirmat faptul că Agenţia...

Biserica lui Iohannis a chemat la Boicot şi a acuzat guvernul PSD-ALDE de Dictatură
evz.ro - Bucureşti
Evanghelică a saşilor transilvăneni a împrumutat limbajul preşedintelui, al USR şi al celor mai fervenţi militanţi anti-referendum, implicându-se brutal în ...

TĂRICEANU îl ȚINE în ȘAH pe Dragnea. ÎNTÂLNIRE de URGENȚĂ a celor doi LIDERI. Se va face MARELE ANUNȚ?
evz.ro - Bucureşti
Luni la Prlament, Liviu Dragnea şi Călin Popescu Tăriceanu vor relua discuţiile cu privire la legea offshore, pe ordonanţa de urgenţă care înfiinţează Fond...

Preotul Constantin Necula despre Referendumul eşuat: “România îşi poate redefini viitorul, chiar dacă acesta va fi dureros”
evz.ro - Bucureşti
Consilierul de imagine al Mitropoliei Ardealului, preotul Constantin Necula, crede că acest referendum nu înseamnă nici victoria, nici înfrângerea cuiva...

Avertismentul Comisiei Europene în legătură cu automobilele DIESEL. NU exportaţi maşinile
evz.ro - Bucureşti
Comisia Europeană este îngrijorată că producătorii auto vor căuta să exporte maşinile diesel vechi în Europa de Est, după aprobarea subvenţiilor pentru achi...

DRAGNEA şi ASUL DIN MÂNECA sa. Un NOU scandal al protocoalelor SRI? CCR a fost implicată
evz.ro - Bucureşti
Preşedintele Camerei Deputaţilor, Liviu Dragnea, va sesiza luni CCR, cu privire la existenţa unui conflict între Ministerul Public şi Parlament....

Scandalul PROTOCOALELOR se mută la Ministerul JUSTIȚIEI. Toader iese la atac
evz.ro - Bucureşti
Ministrul Justiţiei, Tudorel Toader, susţine că sunt „blamate” numai protocoalele care au avut implicaţii în activitatea de înfăptuire a justiţiei, nu şi ce...

Comisia Europeană este în ALERTĂ MAXIMĂ. Unde ar putea ajunge maşinile diesel vechi second-hand care nu vor mai circula în Germania
evz.ro - Bucureşti
Comisia Europeană şi-a exprimat recent îngrijorarea cu privire la faptul că, după ce au obţinut aprobarea subvenţiilor pentru achiziţionarea unor modele mai...

Românii n-au ieşit la vot. Referendumul a picat!
ziarharghita.ro - Harghita
Din cauza absenteismului la vot, referendumul nu a fost validat. La referendumul pentru redefinirea familiei au votat 20,41% dintre alegători, potrivit

Bunătatea unui om simplu. E lecţie pentru mulţi dintre noi - VIDEO
www.stiridecluj.ro - Cluj
Bunătatea unui om simplu. E lecţie pentru mulţi dintre noi - VIDEO

“Cărticica pentru prichindei şi copii mai măricei”: România în strai de sărbătoare – pictură
www.oltenasul.ro - Dolj
Related Posts via CategoriesSpectacole în weekend, la Teatrul Colibri: Punguţa cu doi bani şi Povestea celor trei purceluşiBiblioteca Aman participă la Festivalul Internaţional de Carte TransilvaniaBiblioteca Aman: O NOAPTE ÎN BIBLIOTECĂ – 28 septembrie 2018 – PROGRAMO nouă ediţie a Nopţii Albe a Galeriilor – NAG Vineri, 5 Octombrie 2018Biblioteca Judeţeană „Alexandru şi Aristia Aman”: O noapte în bibliotecăS-au eliberat […]

Reabilitarea Colegiului Tehnic ”Grigore Moisil”, investiţie cu bani europeni, 30,9 milioane lei
www.timponline.ro - Bistriţa-Năsăud
Consiliul Local Bistriţa aprobă într-o şedinţă extraordinară proiectul “Reabilitare si modernizare Colegiul Tehnic ”Grigore Moisil”, corp A, B şi C”, precum şi cheltuielile legate de proiectul care a fost depus pentru finanţare cu fonduri europene prin Programul Operaţional Regional, a parcurs etapa

Microsoft intrerupe distribuirea actualizarii Windows 10
www.tion.ro - Timiş
Microsoft a întrerupt lansarea ultimei versiuni a sistemului său de operare Windows 10. Totul după ce utilizatorii sistemului de operare au reclamat că actualizarea a şters fişiere de pe computerele lor.

VIDEO. Alba Iulia prezintă autorităţilor locale din România reuşitele în cadrul proiectului pilot ”Smart City” 2018
ziarulunirea.ro - Alba
Reprezentanţii Primăriei Alba Iulia, care au implementat proiectul pilot Alba Iulia Smart City 2018, prezintă primarilor din România şi celor interesaţi ceea ce a mers şi ce nu a mers în cadrul proiectului, după aproape doi ani de la începerea lui. ”Ediţia a 6-a a dezbaterilor naţionale Smart City o găzduim în această toamnă la […]

Voinţa Saelele, prima câştigătoare a premiului Fair-play Knauf de etapă în ediţia 2018-2019
ziarulteleormanul.ro - Teleorman
Colaborarea cu firma Knauf continuă în judeţul Teleoman pentru al 14-lea an competiţional consecutiv. În ediţia 2005-2006 s-au pus bazele acestui parteneriat între Asociaţia Judeţeană de Fotbal şi cunoscuta firmă producătoare de materiale de construcţii KNAUF GIPS SRL. “Prin această implicare, Knauf a ajutat foarte mult fotbalul teleormănean, atât din punct de vedere material, dar şi al factorului disciplinar, mult îmbunătăţit în ultima perioada. Mulţumim şi pe această cale conducerii Knauf, d-lui director general Mihai Marinescu şi d-lui director de zonă Teodor Ionescu, şi sperăm ca această c

Referendum 2018: Câţi clujeni au VOTAT ”DA” şi câţi au pus ştampila pe ”NU”
www.stiridecluj.ro - Cluj
Referendum 2018: Câţi clujeni au VOTAT ”DA” şi câţi au pus ştampila pe ”NU”

La vot, în „ţigănia” din Teleorman. Romii din Buzescu nu şi-au părăsit palatele cu turnuleţe ca să iasă la vot
evz.ro - Bucureşti
Doar 500 de oameni din Las Vegas-ul ţigănesc teleormănean au votat. Dintr-un total de peste 3000 de inşi înscrişi pe listele permanente. Printre ei, doar câ...

Povestea sergentului fotograf Costică Acsinte I GALERIE FOTO
evz.ro - Bucureşti
În perioada 10 octombrie – 4 decembrie va fi itinerantă prin ţară una din cele mai inedite expoziţii de fotografie: 100 de imagini realizate de soldatul fot...

Dragnea e încolţit. A început să tragă de timp. Nu s-a prezentat la Înalta Curte
evz.ro - Bucureşti
Înalta Curte de Casaţie şi Justiţie a amânat luni pentru data de 5 noiembrie începerea judecării apelului în dosarul DGASPC Teleorman, în care preşedintele ...

REFERENDUM: Reacţiile vicarului eparhial şi ale purtătorului de cuvânt al Arhiepiscopiei Târgovişte
www.gazetadambovitei.ro - Dâmboviţa
sursa foto: facebook Cu preoţii implicaţi activ în campania pentru referendum, dar şi în mobilizarea oamenilor la vor în cele

De ce a fost boicotat Referendumul: Peste 91 la sută dintre votanţi au spus „DA”
www.desteptarea.ro - Bacău
Biroul Electoral Central a comunicat luni, la ora 10, primele rezultate parţiale ale Referendumului naţional pentru revizuirea Constituţiei din 6-7 octombrie. Până la ora respectivă au fost centralizate rezultatele din 18.724 de secţii de votare, reprezentând 98,3 la sută din cele 19.040 organizate în ţară şi în străinătate. Revizuirea Constituţiei viza înlocuirea sintagmei „între soţi” …

Referendum 2018: Câţi clujeni au VOTAT ”DA” şi câţi au pus ştampila pe ”NU”
www.stiridecluj.ro - Cluj
Referendum 2018: Câţi clujeni au VOTAT ”DA” şi câţi au pus ştampila pe ”NU”

Ce a declarat Tudorel Toader la intrarea in sediul Consiliului Superior al Magistraturii
www.ziuaconstanta.ro - Constanţa
Ministrul Justitiei, Tudorel Toader, a reactionat, luni, la declaratia presedintelui Partidului Social Democrat, Liviu Dragnea, care a spus sambata ca relatia cu ministrul Justitiei decurge foarte ...

Referendum 2018: Câţi clujeni au VOTAT ”DA” şi câţi au pus ştampila pe ”NU”
www.stiridecluj.ro - Cluj
Referendum 2018: Câţi clujeni au VOTAT ”DA” şi câţi au pus ştampila pe ”NU”

Reparaţii de iarnă pe drumurile naţionale din Caraş-Severin
expressdebanat.ro - Caraş-Severin
Se anunţă lucrări de reparaţii la Secţia de Drumuri Naţionale Caransebeş, iar startul acestora se va da mâine. Valoarea contractului care cuprinde peste 20.000 mp depăşeşte 1 milion de lei.

”30 de ani, un nou început”: Carte dedicată protopopului Ioan Dâmbu, lansată la Năsăud
www.timponline.ro - Bistriţa-Năsăud
Joi 11 octombrie, începând cu ora 12.00, în sala de conferinţe a Protopopiatului Năsăud va avea loc lansarea volumului omagial ”30 de ani ”un nou început”. In honorem protopop Ioan Dâmbu”, la împlinirea a trei decenii de slujire ca protoiereu al Ţării Năsăudului, potrivit Radio Renaşterea.
La fes

Bookfest revine la Braşov. Patru zile de sărbătoare a cărţii
feedproxy.google.com - Braşov
Salonul de Carte Bookfest revine la Braşov cu a IV-a ediţie, între 18 şi 21 octombrie. Cei mai îndrăgiţi autori, şi cele mai bune cărţi ale momentului, vă aşteaptă la Aula Universităţii Transilvania (Strada Iuliu Maniu nr. 41A). Tot la Bookfest veţi avea parte de lansări de carte, sesiuni de autografe, dezbateri dar şi reduceri

Referendum 2018: Câţi clujeni au VOTAT ”DA” şi câţi au pus ştampila pe ”NU”
www.stiridecluj.ro - Cluj
Referendum 2018: Câţi clujeni au VOTAT ”DA” şi câţi au pus ştampila pe ”NU”

Câţi mureşeni au răspuns cu „Da” şi câţi au votat împotrivă la referendum
www.zi-de-zi.ro - Mureş
Biroul electoral de circumscripţie electorală nr. 28 Judeţul Mureş a centralizat datele înregistrate

Unde ieşim săptămâna asta: Pe 12 octombrie, manifestări de Ziua Oradiei
www.ebihoreanul.ro - Bihor
Vineri este Ziua Oradiei, prilej cu care au fost pregătite o serie de manifestări la Casa memorială Aurel Lazăr, expoziţii dedicate Centenarului, dar şi o paradă militară. Află lista evenimentelor din această săptămână!

S-a anunţat rezultatul voturilor de la Referendum. Câţi clujeni au spus ”DA”
www.stiridecluj.ro - Cluj
Biroul Electoral Judeţean Cluj a transmis, luni dimineaţă, rezultatele votului Referend...

Referendum 2018: Câţi clujeni au VOTAT ”DA” şi câţi au pus ştampila pe ”NU”
www.stiridecluj.ro - Cluj
Referendum 2018: Câţi clujeni au VOTAT ”DA” şi câţi au pus ştampila pe ”NU”

S-a anunţat rezultatul voturilor de la Referendum. Câţi clujeni au spus ”DA”
www.stiridecluj.ro - Cluj
Biroul Electoral Judeţean Cluj a transmis, luni dimineaţă, rezultatele votului Referend...

Referendum 2018: Câţi clujeni au VOTAT ”DA” şi câţi au pus ştampila pe ”NU”
www.stiridecluj.ro - Cluj
Referendum 2018: Câţi clujeni au VOTAT ”DA” şi câţi au pus ştampila pe ”NU”

Și-a UCIS IUBITA din gelozie, iar acum va plăti pentru fapta sa. Cât va sta la ÎNCHISOARE tânărul de 19 ani. Deznodământ ȘOCANT
evz.ro - Bucureşti
Tânărul care şi-a ucis iubita adolescentă din gelozie îşi va continua viaţa după gratii. Are doar 19 ani şi îi va petrece pe următorii 15 într-o celulă. Mai...

REACȚIE dură de la VÂRFUL EUROPEI cu PRIVIRE la REFERENDUM. „Am CHELTUIT bani cu drag. A fost ca un duş RECE”
evz.ro - Bucureşti
Europarlamentarul Maria Grapini a avut o reacţie vehementă după ce referendumul pentru redefinirea familiei nu a întrunit cvorumul. ...

Referendum pentru familie. BEC a anunţat REZULTATELE PARȚIALE. Câţi români au mers la vot
evz.ro - Bucureşti
Luni, în jurul orei 10:00, reprezentanţii Biroului Electoral Central (BEC) au anunţat că la referendumul pentru redefinirea familiei au votat 20,96% dintre ...

La ce să fii ATENT pentru a nu cădea în plasa „tratamentelor-minune”. Îţi poţi RISCA sănătatea!
newsar.ro - Arad
Citeşte azi ce scriu ziarele de mâine!

S-a încheiat „25 de ore de teatru non-stop”. Ecourile ediţiei a 8-a
presasibiu.oradesibiu.ro - Sibiu
Weekend-ul care tocmai a trecut (6-7 octombrie 2018) a oferit sibienilor şi turiştilor veniţi special pentru eveniment o nouă ediţie memorabilă a Festivalului „25 de ore de teatru non-stop”…

DATfest, ediţia a IV-a, s-a încheiat. Cine sunt câştigătorii
presasibiu.oradesibiu.ro - Sibiu
Festivalul studenţesc de teatru şi management cultural, DATfest, ajuns la cea de-a IV-a ediţie, s-a încheiat sâmbătă, 6 octombrie. De-a lungul celor patru de festival, publicul sibian şi nu numai…

Test
www.gorjeanul.ro - Gorj
Test

Referendum 2018: Câţi clujeni au VOTAT ”DA” şi câţi au pus ştampila pe ”NU”
www.stiridecluj.ro - Cluj
Clujenii s-au prezentat în număr mic la votul de la Referendum, dar n...

lauraadamache.ro: Supa crema de rosii cu busuioc si parmezan
www.ziuaconstanta.ro - Constanţa
Astazi va propun o reteta delicioasa si rapida de supa crema de rosii cu busuioc si parmezan. Recunosc ca am fost destul de sceptica cand am gustat prima data aceasta supa. Nu din cauza rosiilor si nici a ...

Noul Testament de la Balgrad, din 1648, si Biblia de la Bucuresti, din 1688, expuse la Catedrala
www.tion.ro - Timiş
La Timişoara veţi putea vedea Noul Testament de la Belgrad, din 1648, şi alte exponate de valoare, într-o expoziţie care va avea loc la Catedrala Mitropolitană din Timişoara. Aceste cărţi vechi vor fi expuse în muzeul lăcaşului de cult până la finalul lunii decembrie.

Ajutorul pentru ÎNCĂLZIREA LOCUINŢELOR. Ce trebuie să faci pentru a beneficia de el
newsar.ro - Arad
Direcţia de Asistenţă Socială (DAS) Arad a dat publicităţii informaţii legate de acordarea ajutorului pentru încălzirea locuinţelor. În atenţia familiior sau persoanelor singure care vor depune cereri în vederea acordării ajutorului pentru încălzirea locuinţelor, DAS precizează: „Cererile şi declaraţiile pe propria răspundere se vor depune începând cu data de 15.10.2018, pentru perioada sezonului rece noiembrie

Referendum eşuat. 91% din români au votat DA!
portalsm.ro - Satu Mare
Referendum eşuat. 91% din români au votat DA!

16 braşoveni arestaţi preventiv au votat la referendum
feedproxy.google.com - Braşov
Dintre persoanele încarcerate în arestul IPJ Braşov 16 au depus cereri pentru a vota la Referendumul pentru revizuirea Constituţiei. Astfel, sâmbătă, în intervalul 12.15 – 12.55, prin intermediul urnei speciale, aceştia şi-au exercitat dreptul la vot. Cei 16 sunt 14 bărbaţi, aflaţi în arest preventiv, şi două femei reţinute. More from my siteCentru de

Asociatia Pro Democratia afirma ca, organizarea referendumului, grevata de o serie de deficiente administrative
www.ziuaconstanta.ro - Constanţa
Organizarea referendumului din 6-7 octombrie a fost grevata de o serie de deficiente administrative, printre acestea numarandu-se imposibilitatea de verificare in timp real a votului multiplu, deschiderea cu ...

Producătorii şi distribuitorii de ingrediente alimentare vin la Sibiu la INGREDIENTS SHOW
www.oradesibiu.ro - Sibiu
INGREDIENTS SHOW ce se va desfăşura la Hotel Ramada din Sibiu pe 11 şi 12 octombrie 2018, va fi locul de întâlnire a aproape 200 de specialişti din industria alimentară la şi un bun prilej pentru…

Irakieni solicitanţi de azil prinşi în timp ce forţau a doua oară frontiera
evz.ro - Bucureşti
Nouă irakieni au fost depistaţi în timp ce încercau să treacă fraudulos frontiera, pe la Moraviţa. Ei solicitaseră deja azil în România, dar au fugit în Ser...

Logodnicul Elenei Udrea, al doilea mesaj pe Facebook, după reţinerea Elenei Udrea de către Interpol. Cine mai apare în fotografia care însoţeşte mesajul
evz.ro - Bucureşti
Adrian Alexandrov, logodnicul Elenei Udrea, a postat un nou mesaj emoţionant, însoţit de o fotografie cu fiica lui şi a Elenei Udrea, pe Facebook. Este al d...

Preşedintele Juncker şi comisarul Creţu participă astăzi la deschiderea oficială a Săptămânii europene a regiunilor şi oraşelor, la Bruxelles
www.gazetadambovitei.ro - Dâmboviţa
Preşedintele Comisiei Europene Jean-Claude JUNCKER, împreună cu comisarul european pentru politică regională Corina CREȚU, cu preşedintele Comitetului regiunilor Karl-Heinz Lambertz şi cu vicepreşedintele Parlamentului European Pavel Telička,

Primele rezultate ale referendumului: 91% dintre românii care au mers la vot au vrut modificarea Constituţiei
www.ebihoreanul.ro - Bihor
Biroul Electoral Central a făcut publice, luni, primele rezultate ale referendumului pentru modificarea Constituţiei. Din cei 3.778.716 de români care au mers la vot, 91,61% au votat pentru redefinirea familiei. Totuşi, aşa cum se ştie, referendumul nu va fi validat, pentru că prezenţa a fost de doar 20%.

Scandal la Rovinari
www.gorjeanul.ro - Gorj
Un conflict a izbucnit, aseară, între mai multe persoane, în oraşul Rovinari. Poliţiştii au confirmat că a avut loc un scandal, însă nu au oferit deocamdată alte detalii. Surse susţin că o femeie ar fi ajuns la spital, în urma altercaţiei. Revenim cu detalii!

De la anul, noi tarife pentru vizitarea muzeelor şi caselor memoriale din Bistriţa-Năsăud
www.timponline.ro - Bistriţa-Năsăud
Taxele de vizitare a muzeelor şi caselor memoriale din Bistriţa-Năsăud, pe care le percepe Complexul Muzeal, vor fi modificate începând cu 1 ianuarie 2019. Consiliul Judeţean va aproba în acest sens, într-o şedinţă viitoare, un proiect de hotărâre aflat acum în consultare publică.
Astfel, tariful

Borboly Csaba: Importanţa referendumului a fost batjocorită de politica dâmboviţeană
ziarharghita.ro - Harghita
Declaraţia lui Borboly Csaba, Preşedintele UDMR – Organizaţia Teritorială Ciuc, făcută duminică, 7 octombrie, în ultima zi a referendumului pentru

Astrocafe.ro: Horoscop pentru saptamana 08 - 14 octombrie 2018
www.ziuaconstanta.ro - Constanţa
Berbec Saptamana este importanta in plan relational, intrucat se deschid oportunitati de colaborare sau de implicarea intr-o relatie matrimoniala oficiala. Orice relatie parteneriala se va ...

Criminal de 19 ani, condamnat. Va sta 15 ani la puşcărie şi nu îşi va vedea copilul decât peste încă doi
evz.ro - Bucureşti
Tânărul care şi-a ucis iubita adolescentă din gelozie îşi va continua viaţa după gratii. Are doar 19 ani şi îi va petrece pe următorii 15 într-o celulă. Mai...

Noul grafic de colectare a deşeurilor în municipiul Arad
newsar.ro - Arad
Citeşte azi ce scriu ziarele de mâine!
![[FOTO-VIDEO] Neamţ: Intervenţie dificilă, de peste 6 ore, pentru salvarea unui belgian](/showimg/300-200--zi/images/fullinfo.ro-images/news-232547.jpg)
[FOTO-VIDEO] Neamţ: Intervenţie dificilă, de peste 6 ore, pentru salvarea unui belgian
www.stiri-neamt.ro - Neamţ
Interventie dificilă, care a durat aproximativ 6 ore şi 30 de minute s-a derulat duminică, 7 octombrie, pe versantul Nordic al Masivului Ceahlău,

Serviciul de Stare Civila Constanta. Publicatii de casatorie 4 octombrie 2018
www.ziuaconstanta.ro - Constanţa
Tita Traian Laurentiu Pauc Georgiana Paunescu Nicolae David Elena Florina Iordache Gabriel Riza Anamaria Georgiana Cartoafa Florian Tanase Simona Glont Cristian Colareza Andreea-Georgiana ...

Spectacolul Jubileul – după A. P. Cehov – pus în scenă de grupul Skepsis, marţi, la Casa de Cultură a Studenţilor
ziarulunirea.ro - Alba
Marţi, 09.10.2018, ora 19.00, la casa de Cultură a Studenţilor Alba Iulia, Grupul Skepsis vă prezintă spectacolul Jubileul – după A.P.Cehov. După programul spectacolelor în aer liber, proiectul “Stagiunea cu Skepsis 2018” continuă cu spectacolul JUBILEUL, după A.P.Cehov. Este unul dintre cele mai bune spectacole din repertoriul trupei, construit pe baza piesei omonime într-un singur act […]

USR: Cerem demisia Guvernului Dragnea-Dăncilă care dovedeşte că a pierdut contactul cu realitatea
newsar.ro - Arad
Cetăţenii României au confirmat ceea ce Uniunea Salvaţi România a spus de la bun început, că suntem chemaţi la un referendum inutil care nu schimbă nici situaţia juridică a familiei sau a căsătoriei şi nici viaţa de zi cu zi a românilor. Românii au înţeles că adevăratul pericol vine de la incompetenţa şi hoţia coaliţiei

Spitalul Clinic de Pneuftiziologie Constanta, in doliu
www.ziuaconstanta.ro - Constanţa
Tudorel Giurgiu, administrator la Spitalul Clinic de Pneuftiziologie Constanta a plecat dintre noi. Colectivul unitatii sanitare a primit cu profund regret vestea trecerii in nefiinta a lui Tudorel ...

OFERTA SEZONULUI la IONY – Clinica de maşini din Sibiu
www.oradesibiu.ro - Sibiu
Că te pricepi sau nu la mecanică, nu mai contează. E destul să ştii să conduci bine, spre binele tău şi al celorlalţi şoferi iar când ai probleme cu maşina, există specialişti dedicaţi în Sibiu la…

Procesul lui Dragnea – Decizia luată luni dimineaţa de magistraţi
presasibiu.oradesibiu.ro - Sibiu
Liviu Dragnea a avut luni dimineţa primul termen al apelului în dosarul angajărilor fictive. Judecătorii l-au amânat însă pentru data de 5 noiembrie pentru ca părţile să îşi angajeze avocaţi.

S-a incheiat votul in strainatate la referendumul national pentru revizuirea Constitutiei
www.ziuaconstanta.ro - Constanţa
Votul cetatenilor romani aflati in strainatate la referendumul national pentru revizuirea Constitutiei s-a incheiat astazi, 8 octombrie 2018, la ora 7.00, ora Romaniei, odata cu inchiderea ultimelor ...

EXPLOZIE într-un BLOC din Hunedoara. LOCATARII au fost EVACUAȚI de URGENȚĂ
evz.ro - Bucureşti
Mai multe persoane au fost evacuate în regim de urgenţă, seara trecută, după ce o explozie s-a produs într-un bloc din Petrila....

Breaking News. Ce se ÎNTÂMPLĂ cu DOSARUL lui DRAGNEA. ÎCCJ a decis
evz.ro - Bucureşti
Termenul pentru judecarea lui Liviu Dragnea în Dosarul DGSPAC a fost amânal, la cerea lui Dragnea, pentru data de 5 noiembrie. Conform informaţiil postului ...

Doar elevii fără absenţe circulă gratuit pe liniile RATBV
feedproxy.google.com - Braşov
Având în vedere unele informaţii vehiculate în spaţiul public referitoare la încărcarea abonamentelor gratuite pentru elevi, conducerea RATBV precizează, într-un comunicat de presă, că începând cu data de 1 octombrie 2018, elevii care nu au absenţe nemotivate în luna anterioară beneficiază de gratuitate pentru transportul public local de călători. „Beneficiază de gratuitate la transportul cu

ULTIMĂ ORĂ: Vagonul unui tren arde în Gara Gugeşti
www.jurnaldevrancea.ro - Vrancea
Un incendiu a izbucnit în această dimineaţă în gara Gugeşti, unde vagonul unui tren, încărcat cu cărbuni, a luat foc. Potrivit pompierilor, incendiul se | Jurnal de Vrancea

Decese Constanta 8 octombrie 2018
www.ziuaconstanta.ro - Constanţa
Colectivul Spitalului Clinic de Pneumoftiziologie Constanta a primit cu profund regret vestea trecerii in nefiinta a domnului Tudorel Giurgiu, om deosebit administrator de exceptie, model de devotament ...

Explicaţiile psihologului Laura Maria Cojocaru. A vindeca vs. „vinde ca”
www.zi-de-zi.ro - Mureş
Suntem înconjuraţi de tot felul de terapii

Un dram de speranţă
www.ebihoreanul.ro - Bihor
Periculoasa punere în scenă de la finele săptămânii trecute n-a fost deloc un referendum despre familie, ci un plebiscit pentru politicienii din partide şi zarafii din biserici. Familia din România, nici nu are rost să insistăm, are cu totul alte nevoi decât urgenţa „apărării” de homosexuali.

Toni Greblă RUPE TĂCEREA. „Justiţia, o MAȘINĂRIE care funcţionează GREU”
evz.ro - Bucureşti
Luni a fost programat primul termen la Înalta Curte de Casaţie şi Justiţie al apelului declarat de DNA în dosarul în care, Toni Greblă, fostul judecător al ...

Procesul lui Dragnea de astazi a fost amanat
www.ziuaconstanta.ro - Constanţa
Procesul lui Viorel Dragnea de astazi, a fost amanat . Azi,ar fi avut loc la Inalta Curte de Casatie si Justitie va avea loc primul termen in apelul dosarului DGASPC Teleorman, unde presedintele PSD, ...

Constanta: Controalele Politiei Locale pentru mentinerea curateniei si protectia mediului. Ce amenzi au aplicat
www.ziuaconstanta.ro - Constanţa
Pe parcursul saptamanii trecute, politistii locali din cadrul serviciilor operative ale Directiei Generale Politia Locala Constanta au actionat pe toata raza de competenta pentru asigurarea unui ...

România, pe acelaşi loc cu Germania în topul celor mai mici creşteri la preţurile locuinţelor din Uniunea Europeană
ziarulunirea.ro - Alba
Preţurile locuinţelor din România au crescut cu 4,7%, în trimestru al doilea din 2018, comparativ cu aceeaşi perioadă a anului trecut, arată datele Eurostat – Biroul european de statistică. O creştere similară s-a înregistrat în Germania, astfel că acestea două au ocupat împreună locul 10 în Top 10 al celor mai mici creşteri la preţurile […]

Cinci cutremure cu magnitudinea de pana in 3 grade au avut loc in Covasna si Ialomita
ziarmm.ro - Maramureş
Cinci cutremure cu magnitudine cuprinsa intre 2 si 2,9 pe scara Richter au avut loc duminica in Transilvania - judetul Covasna - si in Muntenia - judetul Ialomita - conform datelor Institutului Nation

Ford pregateste o reorganizare masiva care va duce la scaderea numarului de angajati
ziarmm.ro - Maramureş
Ford Motor a confirmat planurile privind reorganizarea fortei sale de munca la nivel global, imbunatatirea operatiunilor sale de afaceri si crearea unei companii mult mai eficiente, care va avea mai p

RCS&RDS a introdus în grilă două noi canele de filme şi un post de radio
evz.ro - Bucureşti
DIGI|RCS&RDS, cel mai mare operator de cablu şi internet din ţara noastră, a introdus în grila de programe noi canale de filme şi un post de radio.
...

TENSIUNI la sediul ÎCCJ. Dragnea este aşteptat de PROTESTATARI
evz.ro - Bucureşti
Luni, 8 octombrie, la Înalta Curte de Casaţie şi Justiţie (ICCJ), urmează să aibă loc primul termen în apel în dosarul angajărilor fictive de la Direcţia Ge...

ÎNSCENARE ca la carte. Cum a EXECUTAT DNA un avocat celebru FĂRĂ NICIO PROBĂ
evz.ro - Bucureşti
Avocatul Tudorel Dobre a fost trimis în judecată de DNA pentru trafic de influenţă, dar a fost achitat de Curtea de Apel Constanţa....

Explozie într-un bloc din Petrila
evz.ro - Bucureşti
Mai multe persoane au fost evacuate în regim de urgenţă, seara trecută, după ce o explozie s-a produs într-un bloc din Petrila....

Locul 3 in UE la scumpirea locuintelor pentru Romania
www.ziuaconstanta.ro - Constanţa
Locuintele din Uniunea Europeana s-au scumpit cu 1,4 ,scrie Digi 24. Datele Eurostat arata, insa, ca Romania depaseste de aceasta data media europeana si inregistreaza unele dintre cele mai ...

Istoria platanului de la „Şaguna”, în „Săptămâna Ariilor Protejate”
feedproxy.google.com - Braşov
În perioada 8 – 14 octombrie 2018, ProPark-Fundaţia pentru Arii Protejate organizează evenimentul „Săptămâna Ariilor Protejate”. Succesul acestui program iniţiat în judeţul Braşov în 2015, a determinat echipa ProPark să propună replicarea iniţiativei la nivel naţional, astfel evenimentul se desfăşoară în 18 judeţe. În acest an organizatorii promovează ariile protejate în rândul publicului larg cu

Ploaia torentiala din America Centrala a dus la moartea a cel putin 12 persoane
www.ziuaconstanta.ro - Constanţa
Ploile torentiale care au afectat America Centrala provocand inundatii si alunecari de teren au facut cel putin 12 morti in doar cateva zile, au informat duminica responsabili din domeniul serviciilor ...

PER: Românii nu au căzut în capcană. Felicitări bistriţeni, suntem europeni!
www.timponline.ro - Bistriţa-Năsăud
”Felicitări bistriţeni, suntem europeni! La încheierea referendumului constatăm cu satisfacţie că românii au dovedit din nou că sunt un popor inteligent, echilibrat, european şi modern. Românii nu au căzut în capcana întinsă de nişte politicieni desprinşi de realitate, au arătat că trăiesc în contem

Povestea care a ȘOCAT România. O româncă din SPANIA, căsătorită cu un „CASANOVA”. La ce UMILINȚE a fost supusă TÂNĂRA. Detalii TERIFIANTE
evz.ro - Bucureşti
O nouă poveste incredibilă sochează România. De data aceasta este vorba despre o româncă, stabilită în Spania şi un bărbat din Câmpia Turzii! Cei doi au împ...

Câţi bistriţeni au votat NU la referendumul pentru familie şi câţi şi-au anulat votul
www.timponline.ro - Bistriţa-Năsăud
La referendumul pentru redefinirea familiei au participat, în Bistriţa-Năsăud, 70.765 de persoane. În urma numărării voturilor din cele 313 secţii de votare, s-a constatat că nu toţi cei care au trecut pe la secţiile de votare au pus ştampila pe "DA".
Dintre participanţii, 3.596 au votat "NU", ia

Mineralele esentiale in activitatea sportiva
www.tion.ro - Timiş
Transpiraţia din timpul antrenamentelor – fie că suntem la sală, alergăm sau pedalăm pe bicicletă – presupune pierderea de electroliţi şi minerale, implicit. Dacă ne antrenăm până în 4 ore/săptămână nu avem de ce să ne îngrijorăm, însă atunci când activitatea este întinsă pe o perioadă mai mare, ar fi bine să ne suplimentăm dieta fie prin alimente specifice, sau printr-un aport de suplimente cu următoarele minerale: calciu, fier, zinc şi antioxidanţi.

Politistii au identificat o constanteanca banuita de furt dintr-un magazin. A fost intocmit dosar penal
www.ziuaconstanta.ro - Constanţa
La data de 7 octombrie a.c., politistii din cadrul Sectiei 5 Politie au depistat o femeie, in varsta de 48 de ani, din Constanta, care ar fi sustras, dintr-un supermarket din municipiu, un produs ...

Judetul Constanta: Material lemnos, confiscat de politisti. Doi barbati s-au ales cu dosar penal
www.ziuaconstanta.ro - Constanţa
La data de 7 octombrie a.c., politistii din cadrul Postului de Politie Rasova au depistat doi barbati, in varsta de 23, respectiv 43 de ani, din localitatea Rasova, judetul Constanta, care transportau, ...

Rezultatele REFERENDUMULUI în Vrancea! Cum s-a votat în localităţile din judeţ
www.jurnaldevrancea.ro - Vrancea
Referendumul pentru definirea familiei în Constituţie va fi invalidat pentru că nu s-a întrunit cvorumul de prezenţă de 30%. Pentru ca modificarea | Jurnal de Vrancea

Jurnalista bulgara Victoria Marinova a fost asasinata la Ruse
ziarmm.ro - Maramureş
Jurnalista bulgara de investigatii Victoria Marinova, directoare si prezentatoare a televiziunii regionale TVN, a fost asasinata 'intr-un mod deosebit de violent' sambata, in orasul Ruse, transmite ag

Peste 800 de milioane de lei plătite în august 2018 pentru principalele beneficii de asistenţă socială
ziarulunirea.ro - Alba
Conform statisticilor Agenţiei Naţionale pentru Plăţi şi Inspecţie, suma plătită în contul principalelor beneficii de asistenţă socială s-a ridicat în august 2018 la 805,68 milioane de lei, din care 769,57 milioane lei pentru drepturi curente şi 36,107 milioane lei pentru alte plăţi. Cea mai mare sumă a fost plătită pentru alocaţia de stat pentru copii, […]

IGPR: Zeci de kilograme de droguri si peste 350.000 de euro, confiscate in urma perchezitiilor in ultimele doua saptamani
ziarmm.ro - Maramureş
Zeci de kilograme de droguri si peste 350.000 de euro au fost confiscate in urma a 102 perchezitii efectuate pe parcursul ultimelor doua saptamani de catre Politia Romana si DIICOT, pentru destructura

CJ Harghita încearcă să convingă la Bruxelles că ”exodul de creiere” trebuie să înceteze
ziarharghita.ro - Harghita
Consiliul Judeţean Harghita, cu sprijinul Comisiei Europene, Parlamentului European şi Comitetului European al Regiunilor, organizează la data de 9

Atentie soferi. Lucrari pe Autostrada A1. Vor fi trasate marcaje rutiere
www.ziuaconstanta.ro - Constanţa
Centrul INFOTRAFIC din Inspectoratul General al Politiei Romane informeaza ca pe Autostrada A1 Sibiu Deva, circulatia rutiera este restrictionata astazi pe unele tronsoane din cauza lucrarilor de ...

Româncuţa Boglarka: PSD-ista Lilla Boglarka Debelka s-a dat în spectacol în America, în numele Centenarului
www.ebihoreanul.ro - Bihor
Pentru a se duce în America şi în Republica Moldova, folcloriştii Ansamblului Crişana au fost finanţaţi cu 140.000 lei din banii Consiliului Judeţean, în numele Centenarului, cântăreţii şi dansatorii dând săptămâna trecută spectacole la Festivalul Românilor din Sacramento (California). La eveniment au fost însă şi băgători de seamă, dintre care cea mai înaltă în grad a fost Lilla Boglarka Debelka.

Inconstienta la volan. Șoferi fara permis de conducere, depistati de politistii constanteni
www.ziuaconstanta.ro - Constanţa
La data de 7 octombrie a.c., politistii din cadrul Serviciului Rutier Constanta au depistat un barbat, in varsta de 51 de ani, care a condus un autoturism, pe DN 2A, fiind sub influenta bauturilor ...

Ambulanţa Neamţ: Trei persoane decedate în acest weekend
www.stiri-neamt.ro - Neamţ
În perioada 5 octombrie 2018, ora 07:00 - 8 octombrie 2018, ora 07:00, s-au înregistrat următoarele cazuri deosebite: 05.10.2018, ora 08:12, Roman,

Întreruperi energie electrică astăzi
www.gorjeanul.ro - Gorj
GORJ• Între orele 9.00 – 12.00, Scoarţa, PTAB Mogoşani – sat Mogoşani.• Între orele 12.00 – 16.00, Bumbeşti Piţic, PTAB Poienari nr. 2 – sat Poienari.

NEWS ALERT/ Dragnea şi Orban au bătut palma! Referendumul VA CONTINUA şi weekend-ul următor
newsar.ro - Arad
Citeşte azi ce scriu ziarele de mâine!

Ce cuplu celebru a fost impreuna cu Simona Halep intr un club din capitala
www.ziuaconstanta.ro - Constanţa
Simona Halep a petrecut cu Principele Nicolae intr-un club, scrie Romania TV. Sportiva se afla in recuperare dupa ce a aflat ca are hernie de disc si a participat la o petrecere organizate de Nicolae si ...

Începe judecarea apelului DNA în dosarul lui Greblă
www.gorjeanul.ro - Gorj
Înalta Curte de Casaţie şi Justiţie a programat luni primul termen al apelului declarat de DNA în dosarul în care fostul judecător al Curţii Constituţionale Toni Greblă a fost achitat în primă instanţă pentru trafic de influenţă.La data de 11 mai, un complet de trei judecători d

Urs rătăcit pe străzile din Săcele
feedproxy.google.com - Braşov
Un urs a fost filmat, sâmbătă seara, rărăcind, într-un cartier de case din Săcele. Animalul sălbatic alerga pe mijlocul şoselei, probabil în căutarea drumului înapoi spre casă, în pădure. Video-ul a fost postat pe pagina de Facebook Info Trafic Braşov de un şofer care se afla cu autoturismul chiar în spatele animalului. În filmulteţ se

ADEVĂRUL a ieşit la LUMINĂ. O ÎNDRĂGITĂ actriţă a povestit cum a fost HĂRŢUITĂ. SCANDALUL care a cutremurat BOLLYWOOD-ul
evz.ro - Bucureşti
O actriţă indiană, încurajată de mişcarea #MeToo, a depus în mod oficial plângere, a anunţat duminică poliţia din Bombay pentru AFP, citată de Agerpres.
...

Gigi Becali, în delir după ce a căzut Referendumul: Suntem cel mai prost popor din lume. Ruşinea pământului
www.stiridecluj.ro - Cluj
Gigi Becali, în delir după ce a căzut Referendumul: Suntem cel mai prost popor din lume. Ruşinea pământului

OFERTA SEZONULUI la IONY – Clinica de maşini din Sibiu
presasibiu.oradesibiu.ro - Sibiu
Că te pricepi sau nu la mecanică, nu mai contează. E destul să ştii să conduci bine, spre binele tău şi al celorlalţi şoferi iar când ai probleme cu maşina, există specialişti dedicaţi în Sibiu la…

Tenis: Caroline Wozniacki invingatoare la Beijing
ziarmm.ro - Maramureş
Jucatoarea daneza de tenis Caroline Wozniacki, nr.2 mondial, a cucerit duminica al 30-lea titlu in circuitul WTA, dupa ce s-a impus in finala turneului de la Beijing, dotat cu premii in valoare de 8,2

VIDEO. CFR: Lucrările de modernizare a tronsonului feroviar Simeria – Sighişoara, care trece şi prin Alba, finalizate 95%
ziarulunirea.ro - Alba
Lucrările de modernizare a tronsonului feroviar Simeria – Sighişoara sunt finalizate în proporţie de 95% între Simeria şi Sighişoara (174 kilometri), a transmis, CFR Infrastructură pe pagina de Facebook. Cele mai avansate lucrări sunt cele de pe tronsonul Coşlariu – Sighişoara, unde stadiul de execuţie a ajuns la 96%, cu un avans de 4% faţă […]

Euro a incheiat saptamana cu o cotatie de peste 4,67 lei
ziarmm.ro - Maramureş
Ultima majorare a dobanzii-cheie operata de Rezerva Federala, de la care se mai asteapta o alta crestere in decembrie, dar si tensiunile din zona euro, provocate de proiectul bugetar al Italiei pentru

Producatorii de energie regenerabila au primit 10,2 milioane de certificate verzi in primele opt luni ale anului
ziarmm.ro - Maramureş
Producatorii de energie electrica din surse regenerabile au primit in primele opt luni ale acestui an un numar total de 10.266.855 de certificate verzi, potrivit datelor postate pe site-ul Transelectr

MESAJ TRANȘANT al comunităţii LGBT: „Românii au respinsa URA prin BOICOT”
evz.ro - Bucureşti
Reprezentanţii comunităţii LGBT afirmă că, prin eşecul referendumului, „românii au respins ura” şi consideră că prezenţa scăzută la referendum...

SPECTACULOS Ce maşini electrice pregătesc marii producători auto
evz.ro - Bucureşti
Constructorii de maşini şi-au dezvăluit planurile de viitor în privinţa electrificării gamei de produse, singura lor soluţie pentru a îndeplini normele tot ...

EXCLUSIV: Alexandru Vişinescu, internat DE URGENȚĂ la spital. Ce a păţit în puşcărie torţionarul de la Râmnicu Sărat
evz.ro - Bucureşti
Fostul comandant al Penitenciarului Râmnicu Sărat condamnat la 20 de ani de detenţie pentru infracţiuni împotriva umanităţii, Alexandru Vişinescu, a ajuns l...

Derby-ul de trap al României a atras peste 3000 de spectatori la Hipodromul Ploieşti într-o atmosferă de senzaţie
evz.ro - Bucureşti
Duminică 7 octombrie s-a dovedit ziua cea mai lungă, dar şi cea mai spectaculoasă, din anul acesta, la Hipodromul Ploieşti. Ziua în care s-a decis câştigăto...

Salvini: Italia isi va inchide aeroporturile pentru zborurile neautorizate cu migranti
ziarmm.ro - Maramureş
Italia isi va inchide aeroporturile pentru zborurile neautorizate cu migranti din Germania, a declarat duminica ministrul de interne Matteo Salvini, pe fondul relatarilor ca landul Bavaria ar pregati

Este un dezastru total pentru Udrea şi Bica! Costaricanii au aflat cine le-a făcut rost de actele de azil! Ar putea avea probleme extrem de grave
evz.ro - Bucureşti
Elena Udrea şi Alina Bica au primit azi politic în Costa Rica şi încă de la bun început au existat multe speculaţii cu privire la modul în care şi-au obţinu...

Producătorii şi distribuitorii de ingrediente alimentare vin la Sibiu la INGREDIENTS SHOW
presasibiu.oradesibiu.ro - Sibiu
INGREDIENTS SHOW ce se va desfăşura la Hotel Ramada din Sibiu pe 11 şi 12 octombrie 2018, va fi locul de întâlnire a aproape 200 de specialişti din industria alimentară la şi un bun prilej pentru…

Accident rutier grav: Implicata o familie cu doi copii. Care este starea victimelor
www.ziuaconstanta.ro - Constanţa
Un accident grav s-a produs in judetul Buzau, pe raza localitatii Maracineni, scrie Observator TV. Parintii impreuna cu cei doi copii minori de 3, respectiv 5 ani au ajuns la spital, dupa ce patru ...

Întreruperi de curent în Braşov şi Ghimbav
feedproxy.google.com - Braşov
Sucursala de Distribuţie a Energiei Electrice (SDEE) Braşov anunţă întreruperea alimentării cu energie electrică, în oraşul Ghimbav şi în Municipiul Braşov, luni, 8 octombrie, pentru efectuarea de lucrări. Astfel, locuitorii de pe strada Aviatorilor din Ghimbav vor rămâne fără curent electric, în intervalul orar 8.00 – 15.00. De asemenea, va fi întrerupt curentul în municipiul

DNA: In 11 ani, 36.406 persoane au facut obiectul unor mandate de supraveghere
ziarmm.ro - Maramureş
Directia Nationala Anticoruptie sustine ca, in perioada ianuarie 2005 - februarie 2016, au fost dispuse 24.576 de mandate de supraveghere in dosarele instrumentate de procurorii anticoruptie, care viz

Școala de muzică pentru tinerii din Reşiţa şi-a redeschis porţile
expressdebanat.ro - Caraş-Severin
Tinerii talentaţi ai Reşiţei se reîntorc la şcoală. „Profesorul” Dean Bowman reia cursurile pentru lecţiile de reggae şi blues.

Luni 8 octombrie
evz.ro - Bucureşti
Nr. 8341 24 de pagini 2,8 lei...

VIDEO: O familie din Vrancea implicată într-un accident la Buzău
www.jurnaldevrancea.ro - Vrancea
O familie din Vrancea a ajuns la spital după ce au fost implicaţi într-un accident rutier care a avut loc în localitatea Mărăcineni, din Buzău. Accidentul | Jurnal de Vrancea

Primăria Alba Iulia a scos la licitaţie un contract de închiriere şi exploatare a 57 de toalete ecologice cu valoare estimată de 3,1 milioane de lei
ziarulunirea.ro - Alba
Primăria Alba Iulia a scos la licitaţie un contract cu valoare estimată de 3.100.500 de lei, fără TVA privind închirierea, amplasarea, exploatarea şi întreţinerea de toalete ecologice în municipiu pentru o perioadă de patru ani. Potrivit documentaţiei publicată online în 29 septembrie 2018, autoritatea contractantă intenţionează sa încheie minimum patru contracte subsecvente. Valoarea maximă estimată […]

CL Baia Mare: Proiect privind modernizarea parcului auto de transport public
ziarmm.ro - Maramureş
Consilierii locali baimareni au adoptat recent un proiect de hotarare privind aprobarea proiectului si a cheltuielilor legate de obiectivul de investitie "Cresterea mobilitatii urbane durabile in Muni

Începere proiect: ”Investiţie iniţială în cadrul Real Expert Advertising SRL prin crearea unei noi unităţi de producţie, construcţie hală producţie şi spaţii administrative şi împrejmuire”
www.ebihoreanul.ro - Bihor
Anunţ de presă privind începerea proiectului, ”Investiţie iniţială în cadrul Real Expert Advertising SRL prin crearea unei noi unităţi de producţie, construcţie hală producţie şi spaţii administrative şi împrejmuire”.

PSD a demonstrat că respectă democraţia! A plătit pentru asta 163,7 milioane de lei, din buzunarele românilor!
expressdebanat.ro - Caraş-Severin
Deputatul PSD de Caraş-Severin Luminiţa Jivan a găsit un mare câştig în eşecul de proporţii al referendumului pentru familia tradiţonală: un câştig pentru partidul din care face parte! „Cu ocazia acestor două zile care au avut o importanţă majoră pentru ţară, ţin să mulţumesc tuturor celor care şi-au răpit un pic din timp şi au…

Retrospectiva săptămânii, prin ochii lui Bihorel: Odeon vrea şcoli maghiare pe malul izvorului Adona, pe Lacul Roşu şi pe pârâul Paris
www.ebihoreanul.ro - Bihor
Cum arată evenimentele săptămânii trecute, prin ochii lui Bihorel: Odeon explică strategia învăţământului în limbile minorităţilor: „Acum am cerut să avem o şcoală exclusiv maghiară şi pe malul stâng al Crişului”.

LIDERII INTERLOPI au fost ÎNLOCUIȚI. Generaţia nouă pune stăpânire pe AFACERILE ridicate de cele mai SONORE NUME
evz.ro - Bucureşti
Liderii interlopi din vechea generaţie încep să cadă pe capete, unii fiind răpuşi de boală , iar alţii eliminaţi de rivali. Un lucru e sigur....

Ce scrie presa internationala despre referendumul din Romania
www.ziuaconstanta.ro - Constanţa
Presa internationala a scris, duminica seara, despre referendumul din Romania de modificare a Constitutiei in sensul redefinirii familiei, subliniind in special prezenta slaba la vot, informeaza Romania ...

Propusa la sefia DNA, Adina Florea sustine interviul in fata Sectiei pentru procurori a CSM
www.ziuaconstanta.ro - Constanţa
Adina Florea, propunerea ministrului Justitiei pentru ocuparea functiei de procuror-sef al DNA, urmeaza sa sustina luni interviul in fata Sectiei pentru procurori a Consiliului Superior al ...

REFERENDUM PENTRU FAMILIE: Satul din Alba în care prezenţa la vot a fost peste 165%. În zonă se află o mănăstire celebră
ziarulunirea.ro - Alba
Prezenţa la vot la referendumul pentru familie în Valea Mănăstirii, comuna Râmeţ, localitate în care află şi celebra mănăstire, a fost de 165,21%, cea mai mare înregistrată în judeţul Alba. Au votat 228 de alegători, dintre care 71 pe listele permanente, 149 pe listele suplimentare şi 8 cu urna mobilă. Au mai fost cazuri, în […]

Umbra lui CEAUȘESCU la Referendum. Editorial de Dan Andronic
evz.ro - Bucureşti
Nu ştiu ce rezultat final va avea referendumul la ora la care scriu aceste rânduri, fiind ziua de sâmbătă, dar este de presupus că acest referendum nu va tr...

ȘAPTE CUTREMURE în SERIE au lovit ROMÂNIA. Activitate seismică EXTREM de CIUDATĂ. Ce se întâmplă în ADÂNCURI
evz.ro - Bucureşti
Activitatea seismică a fost extrem de ciudată duminică, şapte cutremure lovind România pe parcursul zilei. Experţii sunt îngrijoraţi de adâncimea foarte mic...

Rotary Club Caransebeş aduce la Spitalul Municipal cea mai mare finanţare obţinută într-un proiect
expressdebanat.ro - Caraş-Severin
Clubul Rotary Caransebeş a primit vizita a doi membri Rotary din Germania, care, alături de caransebeşeni, vor depune eforturi pentru a obţine fonduri de 78.000 de euro pentru achiziţia de aparatură medicală la Spitalul Municipal de Urgenţă.

Compania de Apă Oradea, programul săptămânal de citire a contoarelor
www.ebihoreanul.ro - Bihor
Compania de Apă îşi anunţă consumatorii că în vederea facturării consumurilor de apă rece pentru luna Octombrie 2018, citirea contoarelor de branşament se va face între orele 8.00 şi 16.00, după următorul program:

Acestea sunt cele şapte ştiri pe care trebuie să le ştii în dimineaţa asta
presasibiu.oradesibiu.ro - Sibiu
La Sibiu a fost un weekend plin, cu numeroase evenimente, unele fericite altele foarte triste. Finalul de săptămână a fost marcat de Referendum şi de marele spectacol din Piaţa Mare…

Accident rutier cu o victima pe DN 22A.Traficul este intrerupt
www.ziuaconstanta.ro - Constanţa
Centrul INFOTRAFIC din Inspectoratul General al Politiei Romane informeaza ca circulatia rutiera este oprita la aceasta ora pe DN 22A Harsova - Tulcea, pe raza localitatii Ciucurova, judetul Tulcea, ...

Nelu Popa nu dă Reşiţa pe New York!
expressdebanat.ro - Caraş-Severin
S-a decis să candideze la Primăria Reşiţa atunci când şi-a dat seama cât de mult s-a degradat oraşul. Prea ocupat probabil cu afacerea sa pe care mai toţi cărăşenii o ştiu, Nelu Popa a ajuns în ultimii ani la concluzia că Reşiţa este pe o pantă greşită. Și a ales să candideze în municipiul pe care spune că nu l-ar da nici pe fabulosul New York.

ENEL anunta intreruperea furnizarii energiei electrice in Constanta. Care sunt bulevardele afectate
www.ziuaconstanta.ro - Constanţa
Electrocentrale Constanta SA CET Palas a comunicat in data de 8.10.2018 ca inregistreaza o avarie pe reteaua care alimenteaza cu energie termica primara punctul termic nr. 108. In consecinta, in ...

VREMEA. Ce ne AȘTEAPTĂ LUNI. Schimbările meteorologice i-a lăsat MASCĂ pe EXPERȚII ANM
evz.ro - Bucureşti
Vremea. Deşi până acum temperaturile au fost în scădere, luni urmează să avem o vreme de primăvară, cu temperaturi ce depăşesc 25 de grade....

Motiunea simpla pe Economie dezbatuta astazi de Camera Deputatilor
www.ziuaconstanta.ro - Constanţa
Camera Deputatilor dezbate luni motiunea simpla pe Economie in care liberalii solicita demisia ministrului economiei Danut Andrusca, urmand ca votul sa fie dat miercuri, scrie Agerpres.ro. Economia ...

Revista presei locale
www.ziuaconstanta.ro - Constanţa
Revista presei locale

VALENTINA PELINEL ÎI ESTE ALĂTURI LUI CRISTI BORCEA
www.7est.ro - Iaşi
%

Se conturează cea mai slabă prezenţă la vot din istoria democraţiei de după ’89.
www.7est.ro - Iaşi
%

Elena Udrea si Alina Bica, ajutate în Costa Rica de notarul traficanţilor de droguri columbieni
www.7est.ro - Iaşi
%

O poveste uimitoare de supravieţuire pe mare: 49 de zile într-o colibă, plutind în derivă
www.7est.ro - Iaşi
%

ANDREEA MARIN A STRĂLUCIT ÎNTR-O ȚINUTĂ SEEN USERS, LA PARIS
www.7est.ro - Iaşi
%

CULISE Sindicatele au bătut palma cu Guvernul!
www.7est.ro - Iaşi
%

Incendiu la o cabană din comuna Horea în care se aflau 15 persoane
ziarulunirea.ro - Alba
Un incendiu la o cabană din satul Baba, comuna Horea, a izbucnit, în noaptea de duminică spre luni, pompierii fiind chemaţi să intervină. Potrivit ISU Alba, staţia Câmpeni a intervenit cu trei autospeciale şi o autospecială SMURD pentru stingerea flăcărilor. Cabana în care a izbucnit incendiul se află în satul Baba din comuna Horea. Nu […]

Toamna orădeană s-a încheiat cu un foc de artificii incendiar (FOTO / VIDEO)
www.ebihoreanul.ro - Bihor
Festivalul Toamna Orădeană s-a încheiat, duminică seară, cu un foc de artificii incendiar, care a ţinut cu sufletul la gură orădenii adunaţi în Cetate şi în jurul ei. Fortificaţia s-a dovedit, din nou neîncăpătoare pentru mulţumea de orădeni veniţi să se bucure de muzică bună cu Antonia şi Carla’s Dream, de street food sau o bere rece. Pentru a evita blocajele oamenii de ordine au fost nevoiţi să monteze garduri de acces pentru a delimita sensurile de intrare şi ieşire din Cetate iar când curtea fortificaţiei s-a umplut de lume au restricţionat accesul dintre curtea interioară a Palatului Prin





















































































































































![[FOTO-VIDEO] Neamţ: Incendiu la un depozit de materiale de construcţii](/showimg/300-200--zi/images/fullinfo.ro-images/news-233189.jpg)
























































































































 www.zi-de-zi.ro - Mureş
www.zi-de-zi.ro - Mureş

![Casa Alex, pregătită pentru iarnă! Tu ţi-ai pregătit casa? [FOTO]](/showimg/300-200--zi/images/fullinfo.ro-images/news-232893.jpg)































































































![[FOTO] Neamţ: Autoutilitară incendiată intenţionat azi-noapte](/showimg/300-200--zi/images/fullinfo.ro-images/news-232787.jpg)









































































































































































































![[FOTO-VIDEO] Neamţ: Intervenţie dificilă, de peste 6 ore, pentru salvarea unui belgian](/showimg/300-200--zi/images/fullinfo.ro-images/news-232547.jpg)
































































































